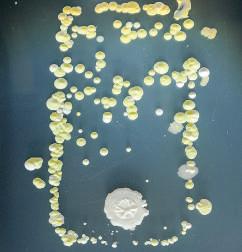

УДК 57+504(075.3) Б63

Авторський колектив: Р. В. Шаламов, М. С. Каліберда, Г. А. Носов
Видано за рахунок державних коштів. Продаж заборонено
Рекомендовано Міністерством освіти і науки України (наказ Міністерства освіти і науки України від 12.04.2019 № 472)
Б63Біологія і екологія (рівень стандарту): підручник для 11 класу закла-
ISBN 978-617-7673-06-3
раціонального
застосування досягнень біології в селекції, біотехнологіях, медицині. Підручник містить актуальні факти й результати відкриттів, описує досягнення в медицині й біології, зроблені нещодавно. Особливу увагу приділено формуванню ключових компетентностей в учнівства, застосуванню навчального матеріалу в реальному житті, вихованню молодих громадян і батьків, стимулюванню підприємливості. Навчальне видання призначене для учнів і учениць 11-х класів закладів загальної середньої освіти, студентів і студенток закладів професійної і професійно-технічної освіти, учителів і вчительок біології та всіх, хто цікавиться природознавчою тематикою. УДК 57+504(075.3) © Шаламов Р. В., Каліберда М. С., Носов Г. А., 2019 © ТОВ «ТО «Соняшник», оригінал-макет, художнє оформлення, 2019
ISBN 978-617-7673-06-3

якомога швидше, оскільки ваш
чи вчителька біології
останніми професійними біологами чи біологинями в житті. Тож отримайте від них те, що вам необхідно для здорового й щасливого існування та цивілізованої взаємодії з довкіллям. Курс «Біологія й екологія» в 11-му класі складається з п’яти тем. Перша з них має назву «Адаптації». Вона присвячена пристосуванням організмів до умов середовища, їхньому формуванню на різних рівнях організації живої природи, а також способам співіснування організмів

го людства. Тут ви не тільки
біології, а й, можливо, знайдете свій шлях у житті в царинах медицини, селекції чи біотехнології, бо він є одним із найперспективніших сьогодні.
Для розкриття окремих тем ми доповнили параграфи рубрикою «Цікаве життя», де поділилися з вами різними цікавинками, дотичними до них. Завдання, уміщені після параграфів, справді не варто оминати. Завдяки ним ви навчатиметесь мислити критично, а це

тощо, які є довкола них. Тобто вони є пристосованими до свого середовища
різних живих організмів, яких ми маємо змогу спостерігати
стосування організмів до умов
організмів та їх угруповань до довкілля якраз
тим вона більш еволюційно успішна. Тому важко не
одного». Саме вивченню властивостей адаптацій, їх
У процесі адаптування виникають пристосування, що покращують виживання
організмів Поняття «адаптація» зрозуміле
є
щоб плавати (рис. 1.1, А), у ластівки крила, щоб літати, у соняшника
для приваблення комах-запилювачів
ди адаптацій,



видів, популяції яких

до складу екосистеми, буде змінюватися
ні умов середовища. Але ми, здебільшого, будемо розглядати
саме на організмовому рівні організації живого. Важливо зазначити, що адаптація не обов’язково є рисою будови (морфологічною), як у зазначених вище прикладах із тюленем, ластівкою й соняшником. Наприклад, адаптацією може бути фізіологічна ознака. Так у рослин, що зростають на засолених ґрунтах (рис. 1.1, Б), вища концентрація солей у цитоплазмі, ніж у рослин звичайних ґрунтів, завдяки чому


сувального значення1. Тому перш ніж стверджувати, що певна характеристика є адаптацією, її потрібно добре проаналізувати. Однак переважна більшість рис організмів має пристосувальне значення. Утім сформувати нові адаптації, не маючи «матеріалу» для цього, на порожньому місці, неможливо. Тому в кожній адаптації є певна
характерна предковій еволюційній
виникло
якого він формувався (рис. 1.3).
місність. Яскраво цю властивість демонструє співвідношення кількості нащадків і рівня батьківської турботи про них. Так, у Ропухи зеленої кількість ікринок, які
відкладає самиця (власне адаптація), сягає
кількох тисяч, у жаби-повитухи — лише
кілька сотень, а в суринамської піпи й того
менше — близько сотні (рис. 1.4). Річ у тім, що зелена ропуха після розмноження залишає ікру напризволяще, тоді як жабаповитуха намотує стрічки з ікрою собі на
лапи, а суринамська піпа носить ікру на спині. Тобто ропуха не
ресурсів на охорону ікри





ше потрібно їсти тварині, тому його шия й має обмежену довжину.
Адаптації мають відносний характер Будь-яке пристосування організму формується у відповідь до певних вимог навколишнього середовища. І, як наслідок, адаптації мають пристосувальне значення лише до цих умов. Якщо вони зміняться, то
своє



ність покращувати пристосованість
певних умов і на певному рівні, зі зміною яких адаптація втрачає своє пристосувальне значення.
Організм і середовище мешкання міцно взаємопов’язані Унаслідок формування адаптацій під впливом умов навколишнього середовища організми стають більш пристосованими, тобто їхня здатність до виживання й ефективність розмноження покращуються. З другого боку, організми змінюють і середовище, що їх оточує, обмінюючись із ним речовинами та енергією, які вони поглинають і виділяють1. Ба більше, змінене середовище по-новому впливає на організм, який починає пристосовуватися
впливати на середовище. Такі взаємодію, взаємозалежність і взаємовплив
ганізму та середовища, у якому він живе, називають законом єдності
му й середовища його

водою, але це неможливо зробити у маловодних річках, тож
саму річку. Отже, лише змінивши середовище свого мешкання, вони можуть спорудити житло, але мають зробити це, пристосувавшись до нових, ними ж створених умов середовища. У цьому й проявляється взаємозалежність

3. Відносність захисної дії зміїної отрути має прояв у
А неспроможності отрути діяти на всіх природних ворогів
Б здатності отрути вражати людину
В збільшенні виживання виду загалом
Г необхідності формування отруйних залоз
4. Виберіть прояв закону єдності організму
А швидкість бігу гепарда зростає

5. Увідповідніть адаптацію та рівень організації живого, на якому вона проявляється.
А клітинний Б органний В організмовий Г популяційно-видовий Д екосистемний
6. Наведіть власні приклади морфологічних, фізіологічних і поведінкових адаптацій. Доведіть, що
7.
заздалегідь, що вона хоче
Чарльзом Дарвіном. Саме еволюційне
що природний добір забезпечує переважне
пристосованих особин



спадкової мінливості, тобто утворення мутацій і нових комбінацій спадкового матеріалу (переважно в процесі статевого розмноження), у популяції постійно з’являються особини, чиї генотипи, а тому й фенотипи, відрізнятимуться. Під час життя, взаємодіючи з іншими представниками свого виду (наприклад, конкуруючи за їжу чи світло), організмами інших видів (мутуалістами, хижаками, паразитами), умовами абіотичного середовища (наприклад, хто з меншими витратами переживе холоди), частина з усієї різноманітності особин популяції краще
не лихо чи нерівноймовірне
полі запилюються), якісь алелі (а, отже, і фенотипи, зумовлені ними) можуть із часом отримати перевагу, а якісь — зовсім зникати. Припустімо, що в озері була популяція жаб, які мали різноманітне забарвлення тіла (рис. 2.2). Через посуху частина особин загинула, а вижити змогли лише одиниці, що переховувались у маленьких кaлюжах. Після сезону дощів озеро наповнилося водою, і популяція жаб відновила свою чисельність. Проте, як виявилося, різноманіття забарвлення шкіри в популяції значно зменшилося! Це було пов’язано зовсім не з тим, що жаби якогось певного кольору краще переносять посуху, а з випадковістю: усі особини,

усьому світу (рис. 2.3). Але в якихось популяціях Азії чи Африки виникла мутація, що забезпечила комах захистом від цих убивчих речовин. Унаслідок штормів або
стійкі до інсектицидів комарі поширились світом. Разом
речовин. Фактично потік генів відіграв роль мутагенезу, забезпечивши генофонди популяцій новими алелями, яких у ньому не існувало.
З іншого боку, потік генів може додавати до популяції й алелі, що протидіятимуть чи «вимикатимуть» корисні, які підвищують пристосованість. Або ж, навпаки, популяція втрачатиме носіїв корисних алелей через потік генів. В обох випадках потік генів протидіятиме адаптивній
еволюції. Саме процес природного добору є єдиним еволюційним механізмом, що призводить до появи адаптацій.
Появу навіть складних
поступовою дією

фосфорорганічних інсектицидів. Б. Обробка сільськогосподарського поля інсектицидом.
Однією з проблем теорії природного добору було пояснення механізму формування складних адаптацій. Річ у тім, що складна адаптація,

ціонувати, як єдиний орган.
частинах,
ханізми їхнього розвитку. Виявилось, що складні адаптації розвиваються поступово, і при цьому їхні частини повноцінно функціонують та покращують пристосування організму до середовища. Так, наприклад, формування ока почалось із появи шару світлочутливих рецепторів
в оці сформувалася лінза — кришталик (рис. 2.4, Д). Приблизно водночас з’явилися райдужка, що живить око й регулює діаметр отвору для світла — зіниці, та рогівка, що забезпечує додаткове світлозаломлення (рис. 2.4, Е). Поява кожної зі структур
добору.
Преадаптація — це майбутня адаптація
функція органу змінюється під час еволюції. Характерним
тепла, подібно до
з’явився стрижень. Таке пір’я, властиве
залицянні. У майбутньому
для польоту. Тобто орган формувався
чав виконувати іншу1 .




Рис. 2.5.
Еволюція пір’я А. Еволюційні зміни будови пір’їни. Б. Відбиток

В. Реконструкція опіреного нелітаючого динозавра синозавроптерикса.
Г. Реконструкція опіреного летючого динозавра чан’юйраптора.


зменшення опору (рис. 2.6). Таке зміщення було б не-
можливим, якщо б череп був одним цілим чи його
кістки нерухомо зросталися заздалегідь. Тобто незрослий стан і наявність окремих кісток черепа стали
адаптацією до пологів у людини лише з формуванням
великого мозку, і, внаслідок, великого черепа. Подібні до викладених вище характеристики, що мають потенційно пристосувальне значення для ще
неіснуючих форм взаємодії організму й середовища,
називають преадаптаціями1. У їхньому формуванні так само, як і у формуванні адаптацій, провідну роль відіграє природний добір.
Постадаптація робить
Формування адаптації



1.

з них має рацію?
А лише Сергій Б лише Олена
В обидвоє Г жоден
4. Який процес ілюструє наведене зображення?
А природний добір Б а даптацію
В потік генів Г дрейф генів
5. Який із наведених прикладів є преадаптацією?
А потові залози ссавців (з них виникли молочні залози)
Б очі рептилій (з них розвинулись очі ссавців)
В двокамерне серце риб (стало основою трикамерного серця амфібій)
Г оплодень (його структура різниться в соковитих і сухих плодів)
6. Увідповідніть компонент ока людини та його функцію
1 зіниця
2 кришталик
3 райдужка
4 сітківка
А фокусування світла
Б живлення передньої частини ока В регулювання кількості світла в оці Г захист світлочутливого шару
Д світлосприйняття

воду в спеціальних тканинах (кактуси, молочаї, алое тощо).
вих регіонах, тому виробили значну кількість адаптацій до таких
3.1). Завдяки товстій воскоподібній кутикулі та незначній кількості продихів зменшується втрата води через випаровування. Ба більше, продихи відкриваються лише вночі, коли прохолодно. Розвинена коренева система ефективно поглинає воду з поверхневого шару ґрунту одразу після дощу, доки та не встигла випаруватися, або, навпаки, заглиблюється аж до підземних водоносних шарів. Листки й стебло є м’ясистими, заповненими водянистими клітинами, що накопичують рідину. Отже, завдяки стратегії активного адаптування організми підвищують здатність до опору неоптимальним умовам середовища й забезпечують свою життєдіяльність за їхній рахунок. Стратегія пасивного адаптування полягає в підкоренні життя організму умовам середовища. Наприклад, окремі тварини впадають у сплячку в періоди нестачі харчів (ведмідь, їжак, тушканчик). Лишайники чи деякі нематоди здатні переживати відсутність вологи, впадаючи в анабіоз, коли в організмі майже повністю припиняються процеси життєдіяльності. Листопадні рослини на зиму скидають





несприятливих умов А. Бурачок пустельний. Б. Зірочник середній (мокрець). В. Гусячий ключ. А

й пустельні рослини-ефемери1 проростають, відцвітають та
(рис.
Завдяки коадаптації
потрібна зміна не одного органу,
шиї жирафи в процесі адаптування до поїдання високо розташованих листків потребувало не лише видовження хребців шийного відділу хребта, але й видовження судин і нервів (рис. 3.3). Ба більше, тепер для піднімання крові високо вгору до мозку (довжина шиї жирафи сягає 2 м) серце й судини повинні створювати більший тиск. А це означає, що і їхня будова теж має змінитися. Таке взаємне пристосування органів і їх частин для забезпечення життєдіяльності в
умовах середовища називають коадаптацією. Схожі приклади взаємопристосування органів

співпрацюють





Рис. 3.4. Приклади коадаптацій А. М’язи крил (червоним) для свого кріплення потребували розвитку великої поверхні грудини — кіля (синім). Б. Яскраві
У більшості трав’янистих рослин для приваблення комах квіти стали яскравими й пахучими, а також зібралися в суцвіття. У двостулкових молюсків одночасно з появою мушлі сформувалися м’язи-замикачі, що не дають змоги хижакові розкрити стулки.
Міжвидові коадаптації розвиваються в процесі коеволюції
Коадаптуватися можуть не лише органи, але й види, що входять до складу однієї екосистеми. За появи певної адаптивної зміни в популяції одного виду для популяції іншого, пов’язаного виду змінюються умови існування, тому він намагатиметься пристосуватися. Наприклад, для того, щоб запилювачі переносили пилок з однієї рослини на другу, у квітках з’явилися нектарники зі смачним наповненням і привабливим ароматом. Спеціалізуючись до запилення






Рис. 3.6. Коеволюція як
(правий стовпчик) подібне до забарвлення яєць тих птахів, у чиї
Б. Природний

(квітковим
відповідно
тами та хазяями, хижаками та жертвами (рис. 3.6). У такому разі хазяї й жертви, намагаючись захиститися від паразитів і хижаків (чи тих, хто їх поїдає), виробляють адаптації, до яких згодом
і хижаків, і починається
Чорної Королеви1: вид змушений постійно адаптуватися

довгим.
Іншим цікавим










видів із часом. Який процес ілюструє графік?
А дрейф генів Б коеволюцію
В а
даптування шляхом уникнення несприятливих умов
Г а даптивну радіацію двох видів
3. Заповніть пропуски в реченні.

Пристосованість
Необхідною умовою (1) є взаємодія видів у межах однієї (2).
А 1 – коадаптації, 2 – популяції Б 1 – коеволюції, 2 – екосистеми
В 1 – преадаптації, 2 – популяції Г 1 – адаптації, 2 – екосистеми
4. Зазначте НЕправильне твердження щодо адаптивної радіації.
А характерна лише багатоклітинним організмам
Б триває тисячі – мільйони років В утворені види споріднені між собою
Г відбувається в середовищі з різними комбінаціями умов 5. Увідповідніть стратегію адаптування та її приклад. А відмирання бактерій під час стерилізації
1 а ктивне адаптування
2 а ктивне адаптування
3 а даптування уникнен-
ням несприятливих умов
6.
7.
високих температур
у творення хобота в слона
ції є саме спадкова мінливість, що
матеріалу. Тобто, на якому б із рівнів організації
фіксуватиме її саме на молекулярному. З огляду на це власне молекулярні та клітинні адаптації
Гени стійкості до антибіотиків
бактеріям уникати знищення Більшість бактерій ґрунту
нізмів, розкладаючи їх до неорганічних речовин. Але



такими стійкими до антибіотиків бактеріями, стало значно складніше, і смертність від них, на жаль, зросла.
Білки-кристаліни очей різних тварин виконують однакову функцію, але мають відмінне походження Як вам уже відомо, для того, щоб краще фокусувати промені світла в оці, у процесі еволюції виникла лінза — кришталик. Для ефективного функціонування він повинен бути заповнений

-кристалін
-кристалін
-кристалін
Речовина, від якої походить матеріал
Білки теплового шоку
Фермент ретинальдегідрогеназа (бере участь у світлосприйнятті) Фермент аргініносукцинатліаза (працює в печінці в циклі утворення сечовини)
Фермент лактатдегідрогеназа В (фермент молочнокислого бродіння)
Фермент глутатіон-S-трансфераза (фермент антиоксидантного захисту організму) Фермент алкогольдегідрогеназа (окиснює спирти до альдегідів)


Рис. 4.2.

проходити до середини цитоплазми й сполучатися з гемоглобіном






гадаймо, що внаслідок точкової (генної) мутації одна нітрогеновмісна основа в ланцюзі
спричинити зміну амінокислотної послідовності білка. Білок із такою зміною набуде іншої просторової форми. За умови, що новий
ню й розмноженню особини, такий алель

сприятиме
добором і з часом поширено популяцією. Так сталося, наприклад, із гемоглобіном S, наявність алеля якого спричиняє серпуватоклітинну анемію. За цієї хвороби частина еритроцитів людини набуває серпуватої форми й гине швидше за звичайні. Утім у регіо-
нах, де поширена малярія, швидка загибель серпуватих еритроцитів має адаптивне значення, оскільки блокує
розвиток малярійних плазмодіїв усередині еритроцитів і забезпечує краще виживання. Ген гемоглобіну S1 відрізняється від гена звичайного гемоглобіну А лише одним нуклеотидом (рис. 4.5).
тин, органів й організму. Нерідко така зміна
ганізму погіршиться. А подекуди вона не буде мати ніякого значення, бо не проявиться у фенотипі (мовчазна мутація), або не змінить його принципово (наприклад, одна коротка неполярна амінокислота буде замінена подібною короткою й неполярною). Тому для «експериментування» еволюції потрібна копія гена. Вона може виникнути завдяки хромосомній мутації — дуплікації. Саме ця мутація, разом із низкою інших мутацій, що відбулися згодом, відповідальна за наше чудове кольорове бачення. Більшість ссавців у колбочках сітківки ока мають два типи відповідальних за колір фотопігментів. Основними їхніми компонентами є фотопсини — білки колбочок, що беруть участь у світлосприйнятті. Один із фотопсинів («синій») входить до складу пігменту, що реагує на
Африки й
таких фотопсинів три: їм характерний


цями, у середині яких міститься кристал із феромагнітних речовин магнетиту (Fe 3 O4) чи грейгіту (Fe 3 S4). Ці кристали мають розмір від
35 до 120 нм. Якщо б вони були меншими, то не могли б створити достатній магнітний момент для спрямовування клітини вздовж лінії
магнітного поля. Крім того, інші за розміром
кристали втрачали б постійну намагніченість і не функціонували б належним чином.
Магнітні кристали утворюються завдяки білкам, розташованим у мембрані магнетосо-
ми. І, на відміну від штучно синтезованих, володіють надзвичайною чистотою, ідеальною формою і приблизно однаковим розміром, що дозволяє застосовувати бактерії, магнітосоми чи самі кристали як точні мініатюрні магніти. Також штучне позаклітинне використання бактеріальних білків, відповідальних за



стає
сів Землі

постійно зростає, починаючи з 2002 року Б чим вища стійкість до пеніциліну, тим вона вища й до тетрацикліну
В зі збільшенням стійкості до антибіо-
тиків кількість хворих на гонорею збільшилась
Г стійкість збудника до флуорохінолонів зросла більше ніж у десять разів
за останні 10 років 2. Який вплив має видалення ядра з еритроцита у ссавців?
збільшує

4.
5.
точку зору про те, що основою адаптацій організмового
є зміни на молекулярному.
6. Які заходи вживаються для зменшення кількості
Оцініть їхню ефективність.
7.
назву екологічна
до умов неживої природи — абіотичних факторів (температури,
го складу середовища,
ням (біотичні фактори): хто полюватиме

й
вони поїдатимуть, із ким конкуруватимуть тощо. Усі зв’язки
пуляціями інших видів у екосистемі,
середовища
Тому говорять, що екологічна
це умовне місце, яке займає вид в екосистемі, його «фах». Екологічна ніша окремої людини в суспільстві — це її рід занять, інтереси, коло знайомств, а також умови, за яких особа існуватиме. Екологічну нішу можна схарактеризувати графічно. Якщо на осях відкласти межі витривалості за екологічними факторами, то отримана багатовимірна фігура й ілюструватиме екологічну нішу виду в екосистемі (рис. 5.1). Ширина екологічної ніші залежить від екологічної пластичності виду Основним параметром екологічної

няє малоактивність, небажання їсти, загальмованість реакцій. Тому можна стверджувати, що ці риби — екологічно непластичні. Пластичність характерна не тільки відносно абіотичних факторів, але й біотичних. Загальновідомим є той факт, що коала живиться винятково листям евкаліпта, тому є непластич-
ним видом щодо типу харчування (рис. 5.2, В). А от усеїдний бурий ведмідь є екологічно плас-
тичним видом: він може ласувати як рослинною, так і тваринною їжею (рис. 5.2, Г).
Але варто пам’ятати, що екологічна плас-
тичність чи непластичність за одним фактором, не означає таку ж властивість за другим. На відміну від непластичності щодо їжі, коала є екологічно пластичним видом відносно кліматичних умов і добре витримує як тропічний клімат, так і прохолодні умови помірного. Важливо також зазначити, що екологічна непластичність не є недоліком. В умовах конкуренції між видами (див. нижче) екологічно непластичні види мають перевагу над екологічно пластичними. Це відбувається тому, що в процесі еволюційного розвитку непластичних
ни «прагнули» максимально
совуватися до визначених умов, тоді як пластичні види «витрачали




Адаптивний потенціал
велике
господарстві. Сорти рослин і породи тварин повинні мати якомога більший адаптивний потенціал. Тоді за зміни умов (нестачі якогось хімічного елемента в ґрунті, спалаху інфекції, екстремальної спеки,
дарства будуть меншими. Крім того, доведено, що адаптивний потенціал невеликих популяцій значно менший, ніж великих. Тому зменшення чисельності популяції нижче певної межі спричиняє таке зниження

виникає конкуренція. У результаті
конкуренції обом видам починає не
вистачати ресурсу. Як наслідок, його
нестача (екологічного фактора) спричиняє звуження ширини екологічної
ніші. І навпаки: за відсутності кон-
куренції за ресурс екологічна ніша
збільшується (рис. 5.3).
Принцип конкурентного
виключення обмежує
кількість видів у екологічній ніші
(довжини, розміру, форми тощо).
Рис. 5.3. Звуження екологічної ніші внаслідок конкуренції А. Частина ресурсу (вище червоної лінії) стає недоступною для виду через конкуренцію — її використовує інший вид.
конкурентного виключення1 (рис. 5.4). Щоб уникнути жорсткої
ватимуть свою екологічну
ка прикладів такої зміни. Одним зі шляхів зменшення конкуренції є просторове розділення видів з екологічними нішами, що перекриваються.
один вид морських жолудів
угору (рис. 5.5). Жорстка конкуренція за ресурси між
пливної-відпливної зони, а другий — був змушений задовольнятися

Щільність
популяції (особин/см3)
Щільність
популяції (особин/см3)


5.6). Вони мають схожу харчову базу та мешкають в іден-
тичних умовах. При цьому єгипетська голчаста миша веде нічний спосіб життя, а золотиста — денний. Але виявилось, що якщо з екосисте-
ми вилучити єгипетську мишу, то золотиста
голчаста швидко переходить до нічного спосо-
бу життя. З цього випливає, що денний спосіб
життя золотистої миші є механізмом зміни її
екологічної ніші задля зменшення конкуренції із єгипетським видом. Таким чином організми використовують різні шляхи для послаблення
конкуренції та розділення екологічних



виконується не завжди Час від часу внаслідок зміни умов середовища (стихійного лиха, нашестя хижаків чи

свідчать, що це правило виконується не завжди. Наприклад, вивчивши різноманіття
Види із (1) шириною екологічної ніші (2) виживають
і є екологічно (3).
А 1 – ма лою, 2 – краще, 3 – непластичними Б 1 – великою, 2 – гірше, 3 – пластичними
В 1 – ма лою, 2 – гірше, 3 – непластичними
Г 1 – великою, 2 – краще, 3 – пластичними
2. Як співвідносяться об’єми екологічних ніш виду, якщо він в екосистемі немає конкурентів (X) і якщо співіснує в ній із подібним видом (Y)? А X > Y Б X < Y В X = Y Г X ≈ Y
3. Знайдіть вислів, який відповідає правилу обов’язкового заповнення екологічної ніші. А немає страшнішого недоліку за душевну порожнечу Б кожна людина так тісно пов’язана з іншими, а якщо вона йде, то залишається величезна діра В природа не допускає порожнечі
Увідповідніть
1
2

5.
6.
логічно пластичними видами.

ми інших істот.
Якщо проаналізувати різноманіття зовнішнього вигляду рослин чи тварин, що мешкають у одному середовищі, то можна виокремити
які мають схожу організацію тіла. Такі типи побудови організмів, що
являються в його зовнішньому вигляді, називають життєвими формами. Існують різноманітні класифікації життєвих форм, що залежать від ознаки, покладеної в основу. Найпростішим прикладом життєвих форм наземних вищих рослин є поділ їх на дерева, кущі, напівкущі й трави (табл. 6.1). Серед тварин наземно-повітряного середовища виокремлюють життєві форми наземних, деревних і повітряних тварин.
При цьому кожну з життєвих форм можна
й далі поділяти для отримання більш детальної
класифікації. Наприклад, існують дерева листопадні й вічнозелені, трави одно-, дво- й багаторічні, повітряні тварини дво- й чотирикрилі тощо. Крім того, є й перехідні види (наприклад, багатостовбурове дерево чи білка-летяга). Ба більше, життєві форми можуть змінюватися протягом усього існування організму (наприклад, у матий-мачухи чи комара) (рис. 6.1).


Весняна
форма без зелених листків. Б. Літня фотосинтезувальна життєва форма зі зеленим листям.
дія екологічних факторів суттєво змінюється залежно від регіону, пори доби чи року, висоти над
ленних екологічних нішах наземно-повітряного
ду, зауважимо, що окремого
на істота не існує все життя, від народження

ніж перейти до
у повітрі. Хоча деякі птахи, як-от серпокрильці (рис.


У тваринному світі освітлення забезпечило орієнтування в просторі задля пошуку їжі, партнера, утечі від хижака чи побудови житла. Адаптацією до його сприйняття є формування очей, які характерні для більшості організмів у наземно-повітряному середовищі мешкання. Оскільки інтенсивність освітлення змінюється протягом доби1, то виникли специфічні екологічні ніші денних, нічних і сутінкових тварин. Цікаво, що структура їхніх очей відрізняється. Денні тварини здебільшого мають очі, що забезпечують кольоровий зір (тобто містять кілька різновидів фотопсинів), тоді як у нічних і сутінкових — поганий кольоровий зір, проте в них є спеціальні пристосування для збільшення вловлювання світла. Наприклад, у собак чи котів, замість світлопоглинального шару, позаду сітківки розташовується світловідбивальний, що забезпечує проходжен-
ня світла крізь фоторецептори два рази:
ззовні до шару й від шару на-
зовні (рис. 6.3). Як тварини бачать уночі, ви можете дізнатися з відео.

Велика мінливість температури
Температурні умови

у будові ока людини й кішки Світло в оці людини (А) поглинається шаром під сітківкою (зображено вишневим кольором), тоді як в оці кішки (Б) цей шар (зображено зеленим кольором) світло відбиває. Відбиття забезпечує двократне проходження світлових променів крізь зорові рецептори сітківки (зображено жовтим кольором).



Рис. 6.4. Теплолюбні організми
A. Дрібне листя акації добре обвітрюється, що дозволяє йому краще охолоджуватися. Б. Родина левів під час полуденної сієсти відпочиває в тіні. В. Великі вуха слона виконують охолоджувальну функцію.
лоджується повітрям і відбиває сонячні промені (рис. 6.4, А), або ж у них воно зовсім відсутнє, як у кактусів. Теплолюбні ж тварини в періоди спеки знижують свою активність й переховуються в норах, ґрунті чи просто тіні (рис. 6.4, Б), тобто мають поведінкові адаптації. Крім того, у теплолюбних ссавців є частини тіла, що випинаються для охолодження, розвинена
ти тепло (рис. 6.4, В). Холодолюбні види навпаки почуваються

й утворення руйнівних кристалів льоду. Крім того, їхній ріст і розвиток зазвичай пришвидшений, оскільки сприятливий для цього сезон у прохолодних регіонах є дуже коротким. Холодовитривалі тварини, своєю чергою, задля переживання сильних заморозків впадають у сплячку чи анабіоз1, під час яких метаболізм значно сповільнюється.
Параметри тіла тварин залежать від

Рис. 6.5. Правила Бергмана й Алена

A. Тіло північноамериканського підвиду сірого вовка (ліворуч) є більшим за тіло індійського підвиду (праворуч). Б. Розмір вух зростає з потеплішанням клімату: найменші вуха — у полярного зайця (ліворуч), середні — у європейського зайця-русака (у центрі) і найбільші — у мексиканського зайця Алена (праворуч).
у великих тварин більша теплопродукція й менша тепловтрата (об’єм зріс більше, ніж площа поверхні тіла), що добре відповідає холодним умовам, тоді як у дрібних тварин навпаки. Іншим наслідком цієї залежності є зменшення розміру частин тіла, що виступають (вух, хвоста, кінцівок тощо): що холодніший клімат, у якому живе тварина, то меншими є розміри її частин тіла. Ця закономірність відома як правило Алена. Остання залежність зумовлена тим, що такі частини тіла мають невеликий об’єм, але значну площу поверхні. А це означає, що тепловтрати в них великі, теплопродукція мала, що неприпустимо в холодних умовах. Наведені правила не є абсолютними і справджуються не завжди.
Інші екологічні фактори мають суттєвий вплив на
в наземно-повітряному середовищі
Як і температура, вологість у

розчину (як люди). Покриви організмів таких місцин
потовщення забезпечує зменшення випаровування вологи з тіла. Оскільки концентрація кисню в наземно-повітряному
3. Якщо виміряти параметри тіл за допомогою кубиків, то об’єм тіла росо-
махи у (X) разів більший, ніж у ласки, але площа поверхні тіла — у (Y) разів. Це свідчить, що великі
звірі є (Z) тепловитратними порівняно з дрібними.
А X – 3, Y – 9, Z – більш Б X – 27, Y – 3, Z – більш
В X – 27, Y – 9, Z – менш Г X – 9, Y – 6, Z – менш


4. Піренейська рись є одним із найрідкісніших видів ссавців
кає на півдні Іспанії. Порівняно з її хвостом, хвіст у звичайної карпатської
А має таку ж довжину Б довший
5. Увідповідніть рису організму й
вища, пристосуванням до якої вона є. А твердість ґрунту
Б висока температура
В заморозки
Г низька густина повітря
Д нестача води

6.
но-повітряного середовища однієї
пляються на території України.
7. Слон і бегемот є великими тваринами, які живуть у спекотному кліматі, тоді
контактує з мінливим наземно-повітряним середовищем. Чим глибше проживають організми, тим зміни умов менші,
сотень метрів, майже всі







Рис. 7.2. Життєві форми тварин-гідробіонтів A. П ланктонні організми мають густину, близьку до густини води, й вирости, що допомагають зависати в її товщі. Б. Червонокнижний білобокий дельфін завдяки потужним ластам і хвостовому плавцю може розвивати швидкість до 60 км/год. В. Смертельно небезпечна кубомедуза морська оса використовує реактивний рух для плавання.
тварини мають пристосування до активного руху — це плавці й ласти для греблі, утворення для реактивного руху (у головоногих молюсків і медуз) та обтічна форма тіла. Наявність численних планктонних істот призвела до виникнення великої екологічної групи організмів-фільтраторів. До них належать губки, ланцетники, двостулкові молюски, синій кит, китова акула. Ці представники пропускають крізь себе воду, при цьому виловлюючи планктонні організми й органічні рештки. Здебільшого

Водні тварини
адаптувалися до незначних змін температури
Температура у водоймах змінюється лише біля поверхні, й то незначно. Це пояснюється тим, що вода має великі теплоємність, значення теплот випаровування й плавлення. Тому для того, щоб змінити її температуру, випарувати чи перетворити на лід, потрібно надати або забрати багато теплоти. У результаті весь
тів зумовлена тим, що глибина
глинаються червоними пігментами.
Тварини поверхневого шару

що
туватися в добре освітлюваному різнокольоровому світі. У
тварин очі є спрощеними,






гідробіонтів.
організми (харчуються рештками), що
тьох із них є ферменти, які вони виділяють у навколишнє середовище
клітинного травлення. Саме ці організми










Рис. 7.7. Макрофауна ґрунту A. Личинка жука-ковалика. Б. Вовчок. В. Багатоніжка кістянка.

(рис. 7.7). Вони пересуваються, розширюючи наявні
прокопуючи нові щелепами
здатності активно рухатися такі тварини швидко залишають зони з несприятливим для себе умовами.
збільшенню родючості.
Великих землерийних ссавців, які живуть у ґрунті, відносять
фауни. Вони мають

копальні різці (сліпаки), малорозвинені очі та зменшені вушні раковини (рис. 7.8). Усе це дозволяє їм активно пересуватися в товщі землі в пошуках їжі й сприятливих умов.




3.
Б на явністю світла
залежністю
сталістю температурних умов біля поверхні
4. Розгляньте діаграму складу ґрунту
за масою й укажіть правильне твердження.
А на йпоширеніший компонент ґрунту — живі організми Б г умус
як в наземно-повітряному середовищі

6.
7.
сповільнюються, їхня швидкість стає недостатньою для забезпечення потреб
А за температури нижче нуля кристалики льоду, що утворюються в клітинних розчинах, розривають мембрани й спричиняють загибель клітин. Висока ж температура розбалансовує процеси обміну речовин:
починають відбуватися настільки швидко, що інші не встигають забезпечувати їх

гії в ньому утворюватиметься. Загалом терморегуляція
Якщо основним джерелом теплоти для організму є зовнішні об’єкти, то температура тіла залежатиме безпосередньо від температури довкілля. Такі Рис. 8.1. Схема теплового балансу організму
1. Надходження тепла від більш
3.
Пойкілотермні організми здійснюють терморегуляцію завдяки випаровуванню води, роботі м’язів і поведінковим змінам Більшість пойкілотермних видів живе в умовах, де коливання температури незначні. Тому вони адаптувалися до
і
в регулюванні температури тіла. Наприклад, рослини тропічних лісів
зниження температури
в діапазоні температур води
ні та мають вузький діапазон толерантності за температурою. Але частина пойкілотермних
в умовах мінливої температури, тому вони виробили способи терморегуляції, що дозволяють їм добре переносити нагрівання чи
На молекулярному рівні пристосування, пов’язане з коливанням температури, може здійснюватися шляхом зміни структури ферментів. Наприклад,
в припливно-відпливній зоні північних
на 20 °С. Тому молюски, що там живуть, мають білки, форма яких залежить від
змінюється так, що реакція починає відбуватися інтенсивніше.

в умови мінливої температури. Але вони мають ефективні
з поверхні листків
й випаровування води потрібно багато енергії, рослини,
Інтенсивність транспірації,

Температура листка, °С

Рис. 8.3. Джміль на квітці в інфрачервоному спектрі Тіло джмеля має набагато вищу температуру, ніж квітка, тому в інфрачервоному діапазоні променів у нього яскравіший вигляд.
енергії використовується для виконання
гляді теплоти,
крил їхні тіла розігріваються аж до +36...+38
(рис. 8.3)!
чином, скорочуючи м’язи, самка пітона, що висиджує яйця, може підвищити температуру свого тіла на 5-6 °С. Інші наземні тварини, уподібнюючись до рослин, регулюють свою температуру шляхом випаровування води. При цьому вона може випаровуватися як із поверхні тіла (як-от у наземних амфібій), так і з відкритого рота (у рептилій).
Гомойотермні

тварини зовнішнього кола час від часу міняються місцями із тваринами усередині, щоб зігрітися (пінгвіни) чи охолонути (верблюди).


Але повністю уникнути несприятливих умов не завжди є можливим, тому гомойотермні характерні й фізіологічні способи регуляції: зміна стану покривів і посилення випаровування. У прохолодних умовах, збільшивши кровопостачання шкіри, птахи й ссавці забезпечують її ефективне зігрівання. А регулюючи стан оперення й хутра, вони можуть значно підвищувати їхні теплоізоляційні властивості (рис. 8.5, А): прогріте повітря біля шкіри
повітрю наближатися до шкіри. За спекотної
Рис. 8.5. Способи терморегуляції гомойотермних тварин A. Збільшення товщини пришкірного повітряного прошарку завдяки настовбурчуванню пір’я дозволяє краще зберігати тепло в холодну погоду. Б. Розповсюдженим способом охолодження в ссавців є випаровування води зі слизових оболонок дихальних шляхів і рота.
тварини

ють випаровування води зі шкіри чи слизових
й верхніх дихальних шляхів (рис.
термні тварини, втрачають
Унікальним способом терморегуляції гомойотермних організмів
шення теплопродукції шляхом
тіло
температур, використовуючи
них тварин. Так, у випадку переохолодження до шкіри людини притікає збільшена кількість крові, тому часто на морозі в людей рожевіють щічки. Також волосини шкіри, завдяки скороченню волосяних м’язів, піднімаються догори, що робить її «гусячою», і затримує
повітря біля неї (рис. 8.6, А). Але якщо дія холоду не зменшується, то втрати тепла



8.6, Б). Його випаровування
дним із найпоширенішим серед ссавців методів зниження температури тіла є випаровування поту з його поверхні. Але рівень розвитку потових залоз в окремих груп ссавців є різним: найбільше їх у шкірі копитних і приматів, мало в хижих, зайцеподібних і гризунів, а зовсім відсутні — у кротів, лінивців, хоботних і китоподібних. Кількість потових залоз у шкірі є адаптацією до умов середовища мешкання та способу існування. Гризуни, кроти й кити мешкають у вологих середовищах, де випаровування води з поверхні шкіри було б малоефективним, та й, крім того, саме середовище їхнього існування перегрівається лише в поверхневому шарі, який легко покинути. Також зменшення кількості поту, що
виділяється гризунами й зайцеподібними, значно ускладнює їхнє знаходження хижаками: лисиця, проходячи повз відкриту схованку зайця, не знаходить його, бо
і



повітря біля шкіри.
організм? Бегемоти, носороги й кабани, які також
що «потіє
Г під час зниження температури довкілля
не змінюється
2. Серед наведених груп організмів оберіть ту, в якій усі організми є гомойотермними.
А синій кит, страус, гібон Б єнот, колібрі, хамелеон В восьминіг, акація, кабан Г ягуар, амеба, пінгвін
3. Яка з реакцій, схеми яких наведено, може бути використана гомойотермними організмами для отримання теплової енергії?
А білок суміш амінокислот Б СН4+ О2 СО2 +Н2 О В СО2+Н2 О С2Н12 О 6+О2 Г нейтральний жир +О2 СО2+Н2 О
4. Заповніть пропуски у твердженні, що ілюструє зміни кровопостачання
шкіри людини на морозі.
Спочатку капіляри (1) задля нагрівання (2), але згодом (3), щоб зберегти
тепло для (4).
А 1 – звужуються, 2 – шкіри, 3 – розширюються, 4 – внутрішніх органів
Б 1 – розширюються, 2 – шкіри, 3 – звужуються, 4 – внутрішніх органів
В 1 – звужуються, 2 – внутрішніх органів, 3 – розширюються, 4 – шкіри
Г 1 – розширюються, 2 – внутрішніх органів, 3 – звужуються, 4 – шкіри 5. Увідповідніть спосіб терморегуляції й механізм, завдяки якому він впливає на температуру тіла.
1
2

А виділення теплоти як побічного продукту хімічної реакції Б зміна площі тіла, що
збільшення тепловтрат
середовища мешкання, значною мірою
компонента. Річ у тім, що останнє середовище це організми інших
любки заселяють представники різних

істот, які
тварин і рослин. Співіснування різних видів, що виникає в результаті, називають симбіозом1. Надалі ми називатимемо більший організм, на якому оселяються — хазяїном, а того, хто оселяється — симбіонтом. Організм як середовище має кілька особливостей. По-перше, місця для життя симбіонта не так багато, як у довкіллі: тіло має значно менші розміри. Тому, щоб поміститися, симбіонти мають бути менші за своїх хазяїв у кілька разів2. По-друге, організм
загине. Отже, симбіонту потрібні шляхи заселення нових


чи є гермафродитами.
шлях — це оселення в тих частинах тіла хазяїна, що забезпечують передавання симбіонта іншим особинам. Наприклад, соски матері є джерелом перших симбіотичних кишкових біфідобактерій, які немовля отримує з грудним молоком. А респіраторні віруси й бактерії розмножуються на слизовій оболонці органів дихання та легко поширюються з краплинками слини. Якщо розглядати тіло організму
й слабше, завдяки
водорості, що живуть на шерсті лінивця (рис. 9.1, А), забезпечені додатковою рідиною в період відсутності дощів, завдяки наявності на волосинах тріщинок і жолобків, у яких накопичується потрібна їм вода. На зовнішнього симбіонта середовище
тації симбіонта (зовнішній вигляд і









сталі. Тому зникає потреба активно реагувати на зміни
іншого. Ну й, урешті-решт,
паразитизм

1
2
3
4



подекуди мутуалізм буває багаторівневим. Так, у кишківнику австралійських термітів живуть одноклітинні міксотріхи (рис. 9.6, Б), які втратили власні мітохондрії й отримують
біонтам. Іще
фіксувальні бульбочкові бактерії

рослиноїдними організмами, отримувати більше світла


2. Черв-симбіонт, що оселяється на шкірі корови,
подібні до таких у
А ґрунтової личинки хруща Б г усені метелика
В водної личинки комара Г пуголовка
3. Прикладом мутуалістичної коадаптації є
А відповідність розміру кігтиків воші товщині волосини
Б червоне забарвлення вишень
В на явність в орхідеї повітряних коренів, що поглинають вологу з повітря
Г товстий теплоізоляційний шар жиру під шкірою кита
4. На світлині зображено рослиноїдного кліща (блідо-рожевий, під крилами), що переноситься мухою. Який тип співвідносин між цими організмами? А паразитизм Б обов’язковий мутуалізм
В коменсалізм Г необов’язковий мутуалізм
5. Увідповідніть адаптацію та середовище мешкання, для організмів якого вона характерна.
1 висока плодовитість
2 копальні кінцівки
3 здатність поглинати розчинений кисень
4 крила


А наземно-повітряне Б водне В ґрунтове Г інший організм
6.
яким типом симбіонта бути
7. Як мутуалізм може сприяти освоєнню нових екологічних ніш і пристосуванню до нових умов?
8. Поясніть, чому вусоногі раки

Паразити є надзвичайно поширеною екологічною групою істот
Паразитизм — це співіснування організмів двох видів, коли один із них використовує другий тривалий час, як джерело їжі. Люди звикли, що паразит — це щось погане, що підлягає знищенню, бо через них інші живі істоти страждають і навіть гинуть. Можливо, така відраза й була причиною того, що вчені тривалий час уважали паразитизм досить рідкісним явищем у природі. Однак аналіз останніх десятиліть довів, що, насправді, паразитів дуже багато. Наразі вчені схиляються до кількості в 40–50 % від усіх біологічних видів, тобто майже кожен другий відомий науці вид, вочевидь, є паразитом!
Паразитизм як спосіб життя виникав у процесі еволюції багаторазово, тому поширений у різних систематичних групах (рис. 10.1). Як вам відомо з курсу біології попередніх років, усі віруси є внутрішньоклітинними паразитами. Паразитичних бактерій навдивовижу небагато: лише близько 100 видів прокаріотів спричиняють хвороби в людини та ще кілька сотень видів паразитують у рослинах і тваринах. Одноклітинні еукаріоти мають у своєму складі кілька груп, у яких поширений паразитизм. Наприклад, усі апікомплекси, до яких належать малярійний плазмодій і токсоплазма, є паразитами. Паразитичні гриби спричиняють ураження й загибель як рослин, так і тварин.







Таблиця 10.1. Форми паразитизму
ектопаразитизм ззовні тіла хазяїна (кліщі, комарі, блохи)
біотрофний паразитизм
паразити харчуються живим хазяїном (малярійний плазмодій, мінога)
облігатний2 паразитизм
паразити гинуть без зв’язку з хазяїном (воші, блохи, ціп’яки)
постійний (стаціонарний)
паразитизм усе життя проводять у контакті з хазяїном (блохи, аскариди, паразитичні рослини)

1 Від. грец. nekros — мертвий і trophe — їжа.
2 Від лат. obligatus — обов’язковий.
3
facultatis — можливість.
ендопаразитизм усередині тіла хазяїна (гельмінти, стеблові нематоди)
некротрофний1 паразитизм
паразити вбивають хазяїна й живляться рештками (чумна
паличка, паразитичні оси та гриби)
факультативний3 паразитизм
паразити можуть живитися не на хазяїнові (хижі п’явки, сальмонели)
тимчасовий (періодичний) паразитизм
контактують із хазяїном час від часу для живлення (комарі, ґедзі)





Окрім зазначених у таблиці форм паразитизму, є ще кілька спеціалізованих (рис. 10.2). Перша з них — це
для рослин, що отримують лише
шої рослини. Омела чи дзвінець
є паразитоїдність.
на личинковій стадії, спричиняючи
належить до ряду Перетинчастокрилі

є певні хімічні
нападника. У більшості

паразити просто застрягають у
У
пошкодження покривів насінні рослини утворюють леткі фітонциди, що мають протигрибкову й антибактеріальну дію. Крім того, рослини й тварини можуть ізолювати паразита, перешкоджаючи його поширенню й живленню. Для цього в рослин потовщуються клітинні стінки й формуються гали (рис. 10.3, Б), а в тварин — капсули навкруг паразитів. Цікаво, що іноді навіть перлини двостулкових молюсків формуються навколо личинок плоских червів.
Поселення паразита може змінювати поведінку хазяїна

Рис. 10.4.

Часто паразит змінює поведінку хазяїна, роблячи його фактично своїм рабом. Наприклад, гриб кордицепс примушує свого хазяїна мураху тікати з мурашника, дертися на рослину, закріплюватися щелепами на листку й вмирати. А сам після цього утворює плодове тіло, яке завдяки підвищенню,
лазма робить щурів безстрашними, і
кота, який, поїдаючи їх, заражається й сам. Личинки
не тільки пригнічувати його імунітет, але й стимулювати ненажерливість, забезпечуючи себе додатковими порціями їжі. Але й хазяї змінюють свою поведінку задля захисту. Наприклад, шимпанзе, заражені
глистами, частіше споживають рослини, що містять отруйні для паразитів речовини.
А тварини з ектопаразитами інтенсивніше
чешуться чи труться, механічно скидаючи паразитів зі своїх покривів.
Паразити мають спеціальні
пристосування для паразитування Паразити, як і решта симбіонтів, стикаються з уже відомими нам із попереднього параграфа проблемами з розмноженням і вирішують їх, як



ротового апарату (рис. 10.1, Є) або інших структур, що
пробивання покривів. Окрім того, у тимчасових паразитів часто розростається травна система
щоб надовго накопичувати харч і не повертатися до хазяїна часто
хом, подібним до того, що використовують хазяї
захисні
на поверхні еритроцита вузлики, завдяки яким
судин
однакових малярійних плазмодіїв, що
Iще в III – IV ст. до н.е. Аристотель і його учень Теофраст («батько»
ботаніки) описували появу іржі
на стеблах і листках злаків (рис. А), уважаючи її наслідком «опіків» сонячними променями, сфокусованими краплями роси, за сприяння теплоти Місяця. У давніх греків був
навіть бог іржі на рослинах — Ро-
біго, для отримання поблажливості якого й відвернення іржі від злаків
навесні здійснювали жертвоприношення! Пліній Старший уважав іржу
найбільшим лихом для злаків через колосальні втрати врожаю. Лише у XVIII ст. стало зрозуміло, що причиною іржі є паразитичний іржаний гриб. Уже тоді допитливі природодослідники помітили, що кущі барбарису також страждають від подібної хвороби, якщо поряд є злаки, й навпаки. Це спостереження стало причиною




1.

2.
на це, вірус гепатиту D є
А факультативним паразитом Б гіперпаразитом
В паразитоїдом Г ектопаразитом
3. Поява численних вузликів на корінні (див. рис.) може бути спричинена
А укусами кротів
Б проникненням нематоди
В нестачею Фосфору в ґрунті
Г посухою
4. Імунодефіцит, який спричиняє
ВІЛ, є адаптацією до
А протидії знищенню з боку хазяїна
Б ефективного розмноження

В перенесення вірусу між організмами хазяїв
Г забезпечення вірусу поживним речовинами
5. Увідповідніть організм і форму його паразитизму.
1 кишкова паличка
2 їздець
3 кордицепс
4 іксодовий кліщ
А ектопаразитизм
Б факультативний паразитизм
В некротрофний паразитизм
Г паразитоїдність
Д гіперпаразитизм
7.
8.
Наземно-повітряне

Тварини
Причин ритмічності кілька: по-перше, процес не може початися знову, доки не завершено попередній. Наприклад, молекула ферменту
дично розщеплювати молекулу
нього етапу розщеплення. По-друге,
телію шкіри
ня білків, що братимуть участь у




центрація речовин
змін у організмі1 .
Періодичність
змін у навколишньому середовищі
Адаптивні біологічні ритми збігаються за періодичністю з процесами в довкіллі (табл. 11.1). Дуже розповсюдженими є
біоритми, що мають періодичність, близьку до 24-х годин. Найбільший прояв вони мають у моменти активізації процесів життєдіяльності денних (бабки, мурахи, гуси) і нічних тварин (таргани, сови, кажани) у відповідний час. У рослин протягом доби можуть змінюватися положення листя, розкриватися квіти, рухатися суцвіття. У людини із періодом у 24 години змінюється активність нервової системи, ефективність розумової діяльності, температура тіла, артеріальний тиск тощо (рис. 11.2). Залежно від добового біоритму активності

Таблиця
Біологічний ритм Добовий
Припливновідпливний
Місячний
Сезонний (річний)
Багаторічний
Зовнішній періодичний процес
Обертання Землі навколо своєї осі
Обертання Місяця навколо Землі й Землі навколо своєї осі
Обертання Місяця навколо Землі
Обертання Землі навколо Сонця Зміна сонячної
активності, циклічні зміни клімату
Приклади
Розкривання й закривання суцвіть кульбаби, зміна активності нервової системи в людини Закривання й розкривання стулок молюсків у припливно-відпливній зоні, закопування безхребетних тварин у дно Розмноження багатощетинкових
20:00
Найвища температура тіла 00:00 12:00 10:00 22:00 08:00
02:00
Найглибший сон
04:00
Найнижча температура тіла

16:00
Найшвидша реакція 14:00
Найкраща координація рухів
Рис. 11.2. Добові зміни в організмі людини
Припливно-відпливні ритми проявляються в зоні припливів і відпливів, що відбуваються двічі на добу1. Фактично, під час приливу ділянка дна є частиною водного середовища, а під час відпливу — наземно-повітряного й ґрунтового. Внаслідок відтоку води, організми, що там живуть, залишаються без захисту від тварин наземно-повітряного середовища, які прилітають поживитися ними. Організми ж товщі води здебільшого
У результаті чотири рази на добу в зоні припливів і відпливів змінюється
екосистема: там з’являються й
організми! Значна кількість змін у зовнішньому вигляді, фізіологічних
ми. Рослини й тварини ростуть, розмножуються, утворюють нащадків
життєдіяльності змінюються залежно від сезону: узимку ведмеді впадають у сплячку, сповільнюючи свій метаболізм, а влітку активно рухаються, підтримуючи
речовин. Так само й поведінка тварин залежить від пори року: вони мігрують, будують житло, шукають партнерів для спарювання у відповідний сезон. Річні біоритми дозволяють організмам уникати несприятливих умов і максимально ефективно використовувати сприятливі.
Реакцію організмів
фотоперіодизмом
багатьох тропічних
клімату, фотоперіодизм менше виражений,

тривалістю
переходять у стан спокою За типом фотоперіодичної реакції

скидають листя або частково відмирають. Для таких рослин найхарактернішими регіонами походження є помірні й приполярні широти. Тривалість світлового дня впливає й на тварин. Здебільшого вони сприймають довжину дня завдяки очам і поверхні тіла. Улітку більшість комах помірних широт, як представників тварин довго дня, активно харчуються, ростуть і розмножуються. А восени ціпеніють. Навесні ж, зі збільшенням довжини дня, із яєць розвиваються личинки, а дорослі організми знову паруються. До речі, значний внесок у вивчення фотоперіодизму в комах зробив ентомолог українсь-

починає
в приміщенні, можна


гого рачка. Яка з причин може бути поясненням його поведінки?
А уночі на поверхні менше водоростей
Б удень на глибині
вода тепліша
В удень на глибині рачки менш помітні
Г уночі на глибині немає хижаків
3. Фотоперіодизм у живих організмів забезпечує
А здатність змінювати життєдіяльність відповідно до пори року
Б зміну положення листків щодо висоти сонця над горизонтом
В зміну пори року
Г можливість реагування
Увідповідніть приклад біоритму
1
2

добовий біоритм Б припливно-відпливний


ну екологію», «вплив
«екологія» вживається в значенні «навколишнє середовище» чи
середовища». Таке використання терміна є некоректним. Варто пам’ятати, що екологія — це наука, а довкілля — один із об’єктів її дослідження. Останнім часом у поняття «екологія» почали включати
блем впливу людини на довкілля, ефективного використання та
вколишнього середовища. Питання взаємодії
наразі актуалізувалися тому, що
стало зрозумілим, що людство є найпотужнішою екологічною

здобутках наук про Землю, фізики,
що вивчає будову, функціонування й взаємозв’язки багатокомпонентних систем із елементів живої й неживої природи
Екологія вивчає взаємовпливи
організмів і довкілля
Далі в цьому розділі, говорячи про екологію, ми матимемо на увазі класичну (біологічну), що досліджує взаємодію організмів між собою та з довкіллям. Відповідно, об’єктами її
є живі організми та їхні групи: популяції, екосистеми, біосфера. Крім

Рис. 12.2. Об’єкти (зелені кола) й предмети (стрілки) вивчення екології
взаємовпливу, зв’язки між організмами, угрупованнями й середовищем якраз і є предметом вивчення екології. Саме вони визначають структуру й принципи функціонування організмів і надорганізмових біологічних систем, які також досліджує екологія (рис. 12.2). Знаючи, що вивчає біологічна екологія, легко зрозуміти її основні завдання. Головним завданням екології є вивчення взаємозв’язків між живою й неживою природою. Також екологія, як наука надорганізмового рівня, займається дослідженням популяцій, угруповань, екосистем і біосфери з огляду на їхню організацію, закономірності функціонування, принципи розвитку. Прикладна екологія додала до цих завдань ряд своїх, таких як вивчення взаємовпливу суспільства й природи та гармонізація відносин між ними. І оскільки людство стало основною
екологічною силою нашого часу, але водночас залишається залежним від ресурсів, джерелом яких є біосфера, то останні питання будуть найбільш актуальними в сучасній екології.
Для екологічних досліджень застосовують різноманітні методи
Класична екологія є біологічною дисципліною, тому для вирішення поставлених завдань використовує звичні для неї методи спостереження й опису та порівняння. Для того,


Рис. 12.3. Пристрої, що використовуються
тва-
dy dt
= –gy + δxy = (δx – g)y
Жертва Хижак
Чисельність Час А Б = αx – bxy = (α – by)x
Рис. 12.4. Екологічні моделі

A. Математична модель Лотки-Вольтерри для системи «хижак-жертва» заснована на двох диференційних рівняннях і описує коливання чисельності популяцій із часом. Б. Комплекс «Біосфера-2» моделює умови різних природних зон Землі.
спостереження накопичуються
совують математичні методи статистичної обробки. Експериментальні методи не поширені
рівня
ликі території. Наприклад, щоб дослідити, як впливає
кількість зайців у

Математична чи лабораторна модель є спрощеним відображенням
12.4)
Завдяки ній легше проаналізувати процеси, що відбуваються в біологічній системі, та її реакцію на різноманітні впливи. Крім загальнобіологічних, є й специфічні для екології
ня. До таких належить
індикації. Його суть полягає у використанні видів-індикаторів



Рис. 12.5. Види-індикатори A. Інтенсивне розмноження ціанобактерій спричиняє «цвітіння» водойм, забруднених фосфоровмісними добривами й мийними засобами. Б. Личинки волохокрильців здатні розвиватися лише в чистій воді. В. Хвощ польовий є індикатором кислого ґрунту.
факторів живої й неживої природи. Наприклад, щодня відбирають проби води чи повітря, аналізують зміни температури, кількості організмів чи їхньої активності. До речі, часто об’єктами екомоніторингу є якраз види-індикатори. Останнім часом у екологічному моніторингу почали застосовувати інформацію, отриману космічними супутниками чи дронами. У результаті

значення
математичних моделей екологам доводиться орієнтуватися й
в галузі екології 2. Проаналізуйте
оберіть правильні.
І. Методи статистичної
них операціях. ІІ. Дані екології
законодавства.
жодне із тверджень не є
3. Оберіть біологічну систему,

дослідження способів
клітин організму В встановлення закономірностей змін у популяціях
Г удосконалення методів навчання задля покращення екологічної обізнаності 5. Увідповідніть метод екологічних досліджень і його приклад. А використання інфрачервоної камери для визначення видів сов у парку
1 моніторинг
2 екологічна індикація
3 моделювання
4 спостереження
Б вивчення наявності чутливих до забруднення повітря видів лишайників навколо заводу В використання акваріума з рибами для дослідження швидкості розмноження ціанобактерій Г щомісячне визначення співвідношення самок і самців коропа в Канівському водосховищі
6.
екологічні чинники.
екологічних факторів, які діють на біологічну систему, якраз і формує те, що вчені називають навколишнім середовищем, або довкіллям. Як вам уже добре відомо, за походженням усі екологічні фактори поділяють на абіотичні, біотичні й антропічні (антропогенні). Абіотичні — це фактори впливу неживого середовища на організми. Виокремлюють кілька їх основних груп: кліматичні (температура, вологість, тиск повітря, вітер), фізичні (освітлення, звук, радіоактивне випромінювання, сила течії), хімічні (солоність і кислотність води, уміст речовин у повітрі чи ґрунті) та географічні (рельєф місцевості, висота над рівнем моря). Біотичними називають екологічні фактори, що проявляються у взаємодії з іншими організмами. Це можуть бути харчові зв’язки, конкуренція, вплив паразитів тощо. Отже, будь-яка форма взаємодії організмів різних видів

й опосередкованої дії. Якщо
тура,
то другі впливають на екологічні фактори прямої дії.
Як вам уже відомо з § 5, ширина діапазонів толерантності (меж витривалості) різних організмів відрізняється. Організми, що мають широкі діапазони толерантності, є екологічно пластичними, і їх називають еврибіонтами, тоді як екологічно непластичні організми — стенобіонтами1 (рис. 13.2). Кактус є стенобіонтом стосовно температури й вологості ґрунту: він не
української зими й загине, якщо його надмірно
ки добре переживають

особина
фенотипи (зовнішній вигляд, життєдіяльність) окремих особин відрізняються (наприклад, усі люди, крім однояйцевих близнят, зовнішньо неоднакові), а тому відрізняється й толерантність до різної інтенсивності екологічних факторів. Також еврибіонт зазвичай мають
Таблиця
Тип
Мутуалізм
Коменсалізм
Хижацтво
Рослиноїдність (виїдання)
Паразитизм (див. § 10)
Конкуренція (див. § 9) Характеристика

Приклад
Бджоли й квіткові рослини
Реп’ях і корова (поширення плодів)
Павуки й летючі комахи
Короп і водорості
Блоха й щур
Вівці й ховрахи (за траву)
У ній знаком «+» позначена вигода виду від співіснування, знаком «–» — його шкідливість, а знаком «0» — відсутність як користі, так і шкоди. Про мутуалізм (+/+) і коменсалізм (+/0), за яких один організм є середовищем життя для іншого, вам уже добре відомо із § 9. Але в наземно-повітряних, водних чи ґрунтових екосистемах також трапляються ці типи
наприклад,
квіткових рослин, отримуючи за це смачний нектар. А тварини, поїдаючи поживні плоди, сприяють поширенню
рослин. Часто мутуалістичні взаємини можуть бути й такими, коли види добре існують
проте разом їм значно краще. До прикладу, 80 % покритонасінних рослин і всі
речовин із ґрунту (від 1 см кореня може відходити до 3 м гіф грибів!). Грибний симбіонт за таку допомогу отримує органічні речовини від рослини. Утім обидва
організми можуть існувати й незалежно, хоча в такому випадку інтенсивність їхнього росту й розвитку зменшується (рис. 13.3, А). Деякі мурахи захищають попелиць від хижаків, отримуючи від них
краплинки поживної паді (рис. 13.3, Б), але обидва організми обходяться й без взаємодії, хоча боронитися від хижаків і харчуватися їм стає складніше. Останні приклади ілюструють висновок


Рис. 13.3. Необов’язковий мутуалізм А. Рослини одного віку, що ростуть у ґрунті без мікоризи (ліворуч), мають менші розміри, ніж ті, що ростуть із мікоризою (праворуч).
Б. Мурахи «вичавлюють» із попелиць краплинки паді як плату за захист, хоча можуть харчуватися й незалежно.
Крім того, один вид може під’їдати рештки їжі за іншим, тобто бути нахлібником. Наприклад, глибоководні риби харчуються рештками потонулої їжі, яку не з’їли риби поверхневих шарів. А риби-прилипали прикріплюються до акул присоскою й живляться за рахунок решток їхньої трапези (рис. 13.4,
нок ефективнішого



Завдяки хижацтву й рослиноїдності підтримується стабільність екосистем Розповсюдженим типом міжвидової взаємодії є хижацтво (+/–)1, коли один організм ловить і вбиває інший із метою поїдання. Зазвичай хижаки є екологічно пластичними щодо типу їжі: оскільки витрати енергії на пошук, полювання й поїдання жертв значні, то перша-ліпша жертва вже буде корисною. Для її пошуку деякі хижаки переміщуються (окуні, яструби, лисиці), а інші чекають, зачаївшись (восьминоги, жаби, гадюки) або побудувавши пастку (павуки). У хижаків добре розвинені органи чуття, й вони здатні до швидких рухів. Жертви, натомість, мають безліч захисних пристосувань. Це й великий розмір тіла (слони,
барвлення тощо (рис.


Рис. 13.5. Захисні адаптації жертв А. Риба фугу здатна різко збільшувати

голки, відлякуючи хижака.
Б. Попереджувальне

утворюючи колючки (кактуси), тверді покриви (дерева), в’язкі (живиця хвойних) й отруйні речовини (алкалоїди пасльонових) тощо. Відповідно, рослиноїди мають пристосування, що дозволяють уникати цих захисних механізмів. Між хижаками й жертвами, рослиноїдами й рослинами тривають безупинні «перегони озброєнь» за принципом Чорної Королеви (дивись § 3). Основне значення всіх взаємодій типу +/– (хижацтво, рослиноїдність, паразитизм) полягає в підтриманні стабільності екосистем: зміна чисельності організмів, що отримують вигоду (хижаків, рослиноїдів, паразитів), впливає на чисельність організмів, для яких співіснування є шкідливим (жертв, рослин і хазяїв), та навпаки (рис. 13.6). Також усі
Досить рідкісним різновидом стенобіонтів є організми, що живляться
лише одним видом їжі — монофаги. Цим тваринам характерне поїдання організмів одного виду чи декількох видів, що належать до одного роду. Більшість монофагів є рослиноїдними організмами, при цьому здебільшого це комахи.
Цікавим прикладом монофага є мете-
лик Данаїда монарх (рис. А). Його гусінь живиться тільки на рослинах роду Ваточник. При цьому в ній накопичується значна кількість отруйних речовин кардено-
лідів, через які як гусінь, так і доросла особина не до смаку хижим птахам. Особливістю метелика є його здатність мігрувати на відстані до 3000 км для зимівлі в Мексиці. І якщо на південь летить одне покоління, то на північ повертаються його онуки й правнуки, які народжуються й виростають під час мандрівки з місць зимівлі.
Інший вид-монофаг знайшов своє застосування в біологічній боротьбі з бур’я-
нами. Це жук звіробійний листоїд, який живиться на рослинах роду… Звіробій!
Як і звіробій, жук був розповсюджений
у Євразії й Північній Африці. У XVIII ст.
насіння звіробою потрапило до Америки, де за відсутності природних ворогів стало

Рис.

Рис.

бур’яном й заполонило великі площі. У 1930–1940-х роках для боротьби з «нашестям» звіробою до Америки привезли кілька видів листоїдів, які допомогли «очистити» луки від звіробою-бур’яну (рис. Б). Монофаги трапляються не тільки серед комах.
Г течія, що відносить медуз
2. Якщо інтенсивність дії екологічного фактора є більшою за максимальне значення інтенсивності в діапазоні толерантності, то організм
А впадає в сплячку
Б гине
В повільніше розмножується
Г швидше еволюціонує
3. Оберіть правильне твердження щодо мутуалізму.
А організми-мутуалісти витрачають частину ресурсів на підтримання взаємовигідних відносин
Б прикладом мутуалізму є поїдання сорокою пташенят інших птахів
В що більше в екосистемі мутуалістичних відносин, то
в ній існує різних видів
Г види-мутуалісти змагаються за

ресурсу
4. Виділення часником сульфурoвмісних фітонцидів із різким запахом
А відбувається для підтримання мутуалістичних відносин
Б є наслідком коеволюції
В є поведінкою жертви
Г захищає рослину від несприятливих абіотичних факторів
5. Увідповідніть тип симбіозу з його прикладом.
2 коменсалізм 3 рослиноїдство
хижацтво
використання мурахами хвоїнок для побудови мурашника 1 мутуалізм
А висмоктування попелицями рослинних соків Б поїдання попелиць сонечками В захист мурахами попелиць від поїдання сонечками Г висмоктування соку з однієї рослини попелицями
комарами
інтенсивності екологічного фактора,

найсильніше обмежувати життєдіяльність організму. Такі близькі за інтенсивністю до меж толерантності екологічні фактори отримали назву лімітувальні, або обмежувальні. А закон мінімуму Лібіха формулюють так: виживання організму визначається лімітувальним фактором, інтенсивність якого наближається до мінімуму витривалості (толерантності).
закон легко проілюструвати
ані
розуміння обмежувальних факторів має велике значення,
врожаї. Наприклад, нейтралізація кислотності ґрунту внесенням
збільшити врожаї пшениці.
Взаємодія екологічних факторів
організму
Виявляється, що

з ним нестача одного
існують. Є й інший наслідок пристосованості кожного виду до власної екологічної ніші — правило екологічної
ності. Відповідно до нього набір адаптацій кожного виду є унікальним і властивим лише для нього. Незважаючи
пристосування (наприклад, для водоплавних тварин характерна обтічна форма тіла, що зменшує опір води), сукупність усіх
ного виду

у книзі «Коло, що замикається» сформулював чотири всеохопні закони
принципи функціонування біосфери й дають поради людству, як
родою. Закон «усе пов’язано з усім» ілюструє нерозривний
усіх процесів і об’єктів у природі. Тому будь-яка дія людини на неї матиме наслідки, що проявляться одразу або з часом, у цьому ж

Рис. 14.4. Обкладинка популярного американського журналу «Time» за лютий 1970 року Завдяки активній громадській діяльності в США Баррі Коммонер асоціювався з екологічними проблемами, тому його портрет зображено на обкладинці журналу між світлим природним довкіллям і темним, зруйнованим людиною середовищем.
виробництва перероблялися та не накопичувалися в природі. Наступний закон стверджує, що «природа

якусь суспільну вигоду (більше їжі, теплі будинки
потрібно буде «відшкодувати». Наприклад, інтенсивне спалювання
задля отримання енергії спричиняє збільшення викидів
свідчить про те, що
А Фосфор пригнічує життєдіяльність ціанобактерій
Б кількість Фосфору у воді залежить від смертності ціанобактерій
В вміст Фосфору у воді є лімітувальним екологічним фактором
Г збільшення вмісту Фосфору у воді компенсує оптимальну кількість світла 3. В організмі людини амінокислота тирозин утворюється з амінокислоти фенілаланіну. Тому згідно зі законом компенсації екологічних факторів
А нестача фенілаланіну може бути компенсована надлишком тирозину
нестача тирозину може бути

та її опис.
1 правило екологічної індивідуальності 2 закон толерантності
3 закон компенсації екофакторів 4 закон сукупної дії екофакторів
А пристосування організму залежать від умов
Б виживання організму визначається взаємодією всіх екологічних





Популяції тварин відрізняються за типом використання простору. Осілі популяції комах, зайців, ґрунтових організмів усе життя проводять на одному місці. Вони добре орієнтуються на території проживання, мають зроблені запаси харчу, знають, де ховатися від хижаків. Популяції копитних, граків,
ців належать до кочових. Вони постійно переміщуються на невеликі відстані в пошуках їжі чи кращих умов середовища. А мігруючі популяції проживають у кількох віддалених місцях і час від часу переселяються з одного в друге. Наприклад, перелітні птахи, вугрі, лососі долають
уникнення несприятливих умов чи розмноження.
Основними характеристиками популяції є чисельність і щільність
В усіх популяцій є кілька характеристик, що дозволяють аналізувати процеси, які в них відбуваються. Найважливішими серед них


Оптимальна щільність популяції має відповідати ємності
середовища мешкання
Підтримання більш-менш сталої щільності популяції — гомеостазу популяції — досягається шляхом балансування народжуваності й смертності, тобто урівнювання кількості особин, що народжуються й вмирають за певний проміжок часу. Крім цього, підтримання гомеостазу може здійснюватися шляхом еміграції (відтоку особин із популяції) чи імміграції (притоку особин до популяції). Співвідношення цих чотирьох
зміни чисельності популяції з часом. Оптимальна густота популяції повинна відповідати ємності середовища мешкання — здатності довкілля забезпечувати визначену кількість
умов швидкість використання ресурсів відповідає швидкості їх відновлення.
середовища.
Існує багато механізмів підтримання
Виокремлюють дві групи механізмів підтримання гомеостазу: внутрішньовидові й міжвидові. Серед рослин розповсюдженим механізмом внутрішньовидового підтримання чисельності
регуляції
дії. Як ви пам’ятаєте із § 13, чисельності популяцій хижаків і
і паразитів, рослиноїдів і рослин, що
взаємозалежні. Ця взаємозалежність є
чисельності популяції — популяційних хвиль1 (рис. 13.6). Популяційні хвилі зумовлені коливанням екологічних факторів як абіотичної (зміна пори року, температури), так і біотичної (зміна чисельності хижаків, паразитів) й антропічної (антропогенної) природи (браконьєрство, забруднення водойм). Тому чисельність популяції не залишається на одному рівні постійно, а коливається близько до цього значення.




Просторова, вікова, статева структура популяції залежать
і умов довкілля
особини, то її чисельність зростатиме, якщо старі — спадатиме,
якщо
рівні, то чисельність буде стабільною. Але у тварин і рослин із коротким життєвим циклом (комахи, однорічні рослини) вікова структура швидко змінюється: після періоду народжень молоді
самок
упливають на статеву структуру. У планктонних ракоподібних більшу частину року популяція складається тільки з самиць, що розмножуються партеногенезом. Але при зміні умов (похолодання, посуха) у популяції з’являються самці. У крокодилів і черепах стать новонароджених залежить від температури, за якої розвиваються яйця. Популяції тварин також відрізняються поведінковою структурою. Розрізняють популяції
Поодинокі організми, такі як численні комахи,
тя (табл. 15.2)

цариця). Також часто
у приматів переважно лише альфа-самець спарюється із самками, тоді як решта самців



знайти
що горобців на
му полі втричі більше, ніж на іншому, та їхня чисельність зросла на 10 % протягом останнього місяця. Але часто, як і Петрику, екологиням й
саме абсолютну чисельність популяції. Для
виду є (1), ніж між особинами
А 1 — більшою, 2 — окремими популяціями
Б 1 — меншою, 2 — окремими екосистемами
В 1 — більшою, 2 — єдиною популяцією
Г 1 — меншою, 2 — єдиною екосистемою
2. Зазначте рису, притаманну кочовим популяціям.
А проживання в різних місцях, що віддалені одне від одного
Б усе життя проводять поряд із місцем, де народилися
В знаходяться в постійному русі з місця на місце
Г добре освоюють одне місце, у якому постійно мешкають

є (2).
3. Що сповільнить зростання чисельності в перенаселеній популяції?
А зниження стійкості до інфекцій
Б збільшення кількості яєць, що відкладає самка
В зменшення відстані, на яку поширюється насіння
Г зменшення тривалості ембріональних етапів життєвого циклу
4. Розгляньте статево-вікову структуру населення України
значте, як змінюватиметься чисельність
ми (без урахування міграцій).
А зростатиме Б не змінюватиметься
5. Увідповідніть


час видиху чи випорожнення)
елементів (поглинання — використання — виділення), який і є
нізмів різних видів, що пов’язані між собою та з навколишнім середовищем колообігом речовин і потоком енергії. Зразками екосистем є міський парк, ліс, березовий гай, лісове озеро, Чорне море (рис. 16.1). Як ви бачите, їхні розміри дуже мінливі: є дуже дрібні, наприклад калюжа чи трухлявий пеньок, а є гігантські — Атлантичний океан чи тропічний ліс басейну Амазонки.
Також екосистеми відрізняються ступенем замкненості колообігу речовин. В екосистемах проточних водойм, кам’янистих схилів гір неорганічні речовини безупинно надходять до екосистеми й швидко залишають її, тому в колообігу постійно беруть участь нові атоми хімічних елементів. А в екосистеми лук чи озер ці хімічні речовини надходять у незначній кількості, і, здебільшого, одні й ті ж атоми хімічних елементів повсякчас поглинаються
й вивільняються організмами.
Популяції різних видів
У складі будь-якої екосистеми є два основних компоненти: неживий




екосистеми, — угрупованням, або біоценозом2. Його складають популяції всіх видів, які утворюють цю екосистему. У складі угруповання виокремлюють три відмінні за функцією й типом
лення групи популяцій: продуценти, консументи й редуценти.
Продуценти — це автотрофні організми, які здатні перетворювати неорганічні сполуки на органічні й використовувати останні для побудови
тів, здатних до фотосинтезу
забезпечують включення неорганічних речовин у колообіг
екосистеми. У подальшому органічні речовини, що
утворили продуценти, поглинаються консументами — гетеротрофними
які живляться іншими організмами. Зазвичай це рослиноїди, які харчуються продуцентами. А рослиноїдів їдять інші консументи: хижаки чи паразити. Консументи перетворюють органічні
Якщо вони екстремальні (занадто низькі чи високі температури, надмірна чи недостатня вологість тощо), то кількість видів у екосистемах є невеликою. Через це пустелі чи арктичні регіони менш заселені організмами. Порівняйте: у тундровій екосистемі є
лісі — кілька десятків тисяч (рис. 16.3). Видове різноманіття залежить і від різноманітності умов у біотопі. Що більш відмінними за своїми умовами є ділянки біотопу та що
то




ними. Прикладами таких видів є фікуси
печують більшість тварин
спричиняє спалах чисельності рослиноїдів, що згодом
акації в савані,

ярусність помітна в розташуванні
рівнях розміщуються дерева, яким необхідно
використовують кущі, трави й мохи, що ростуть біля поверхні
й належать до окремих ярусів. Зрозуміло, що
живляться на відповідних
тобто також розміщуються ярусами. Але їхня здатність до руху робить тваринну ярусність не такою очевидною.
пошаровому розміщенню зменшується
екологічних ніш популяцій, а значить, і конкуренція, що дозволяє всім видам краще розвиватися.
Реалізація



і хазяїв є взаємозалежними, як про це вже йшлося в попередніх параграфах. Також, наприклад, якщо редуценти не встигатимуть поновлювати запаси мінеральних речовин у землі, розклавши рештки, то швидкість збільшення біомаси рослин (їхня
зменшуватиметься.
Завдяки розмноженню
до самовідновлення: після загибелі частини організмів, їхня кількість швидко відновлюється. Крім того, екосистеми володіють стійкістю, тобто здатністю



1.

болото Б пустеля Гобі
В Чорнобильський ліс Г джерело мінеральної води
2. Виберіть характеристику екосистеми, що НЕ описує біоценоз.
А кі лькість видів-хижаків
Б г устина популяції домінантного виду
В річний діапазон коливань температури
Г рослини, що утворюють деревостій
3. Що більше популяцій різних видів входить до складу екосистеми, то
А більше в ній продуцентів
Б менша конкуренція в ній
В швидший колообіг речовин у ній
Г більша її стійкість
4. Рослини найнижчого ярусу широколистяного
А світлолюбними Б теплолюбними
В тіньолюбними Г посухолюбними
5. Екосистема з високою стійкістю
А повільно руйнується Б швидко відновлюється після руйнування
В легко винищується під дією зовнішнього впливу
Г не здатна відновитися після руйнування
6. Увідповідніть функціональну роль у колообігу
Між популяціями в біоценозі існують різні типи зв’язків Як ми з’ясували в попередньому параграфі, тривале існування екосистеми, її саморегуляція та стійкість забезпечуються популяціями різних видів, що пов’язані між собою в складі біоценозу. Це об’єднання забезпечується різними типами зв’язків (рис. 17.1). Основним типом зв’язку між по-
пуляціями різних видів є трофічний1 зв’язок, за якого організми, їхні мертві рештки чи продукти життєдіяльності є джерелом їжі для організмів інших видів. Часто одні
популяції створюють умови для існування особин других популяцій. Цей тип зв’язку називають топічним 2 . Наприклад, птахи, що гніздяться на гілках дерева, пов’язані з ним топічними зв’язками, як і світлолюбні рослини, що створюють під своєю кроною затінені умови для тінелюбних. Завдяки топічним зв’язкам організми одного виду використовують видозмінене іншим видом середовище. Форичний 3 зв’язок виникає тоді, коли представники однієї популяції
беруть участь у поширенні особин іншої
популяції. Яскравими прикладами такого зв’язку є перенесення плодів лопуха на
шерсті травоїдних ссавців, яєць глистів —
на ногах мух і тарганів (тому важливо не
допускати контакту цих тварин зі стравами!), а насіння рослин (вишні, чорниць, горобини) — у травній системі птахів. Якщо особини однієї популяції
інших популяцій, то виникає фабричний4 зв’язок.




Рис. 17.1. Різні типи зв’язків між популяціями в біоценозі А. Трофічний зв’язок: муха «влипла» у слиз росички, яка її перетравить за кілька днів. Б. Топічний зв’язок: кактуси пітахаї ростуть у затінку куща паркінсонії, де волого в ґрунті.
В. Форичний зв’язок: насіння горобини поширюється вільшанкою

1 Від грец. trophе — їжа.
2 Від грец. topos — місце.
3 Від грец. phorae — носіння.
4 Від лат. fabriсo — виготовляти.
чатку трофічного
харчування всієї екосистеми. Такі автотрофні організми, що перетворюють неорганічні речовини в органічні, належать до трофічного рівня продуцентів. Як ви пам’ятаєте, найчастіше це рослини, здатні до фотосинтезу. Ними харчуються рослиноїдні організми, яких відносять до трофічного рівня консументів першого порядку. Консументів першого порядку поїдають уже м’ясоїди — консументи другого порядку, а їх — консументи

організмів, які харчуються органічним матеріалом, що розкладається. Поїдання детритофагами рослинних решток розпочинає новий трофічний ланцюг. Такий харчовий ланцюг, що бере початок від мертвих решток, називають детритним, тоді як той, що починається поїданням живих продуцентів — пасовищним (рис. 17.2).
Рис. 17.2. Харчові ланцюги
1. Кукурудза (продуцент).
2. Сарана (консумент І порядку).
3. Ящірка (консумент ІІ порядку).
4. Змія (консумент ІІІ порядку).
5. Опале листя (рештки продуцента).
6. Мокриця (консумент І порядку).
7. Горобець (консумент
Трофічні мережі виникають, коли трофічні ланцюги
перетинаються Зазвичай у природних екосистемах окрема популяція є компонентом одразу кількох трофічних ланцюгів. Напри-
клад, зайців їдять не тільки вовки, але й лисиці та яструби, а синиці харчуються як комахами, так і насінням і плодами рослин. Унаслідок таких перетинів ланцюгів формується складна структура харчових взаємин у біоценозі — трофічна мережа (рис. 17.3).
Навіть трофічні мережі бідних на
Акула (рибоїдна риба)
Тунець (рибоїдна риба)
Оселедець (харчується планктоном)
Мальки (харчуються планктоном)
Молюски (зоопланктон)
Рис.

Каракатиця
Анчоус (харчується планктоном)
Ракоподібні (зоопланктон)
Одноклітинні фотосинтетики (фітопланктон)
види екосистем є дуже складними й заплутаними тому, що різні організми мають відмінні харчові вподобання: хтось живиться кількома іншими видами, а хтось — декількома десятками. Крім того, популяція може розміщуватися на кількох трофічних рівнях водночас. Особливо це стосується всеїдних організмів, як-от ведмедя чи їжака,
як
Енергія,

тіл, переходить до консументів частково, оскільки більшість продуцентів не поїдається й відмирає, стаючи основою детриту. Частина з енергії з’їдених продуцентів
термодинаміки
теплоти. Зрештою, хімічна енергія органічних
суті, правило екологічної піраміди
організмах одного рівня, не можливо. Тому на практиці часто будують піраміди біомаси, або піраміди чисельності. Вони відтворюють зміну маси організмів чи їхньої чисельності. Піраміди чисельності, чи біомаси, можуть бути перевернутими,
ніх рівнях організмів менше
рівнів. Така перевернута піраміда чисельності виникає,
в екосистемі є набагато меншою за
тварин, що ними живляться.
морським екосистемам. Якщо великі
фітопланктоном,


1.

2. Зазначте правильну характеристику консумента другого порядку.
А гетеротроф, що живиться тваринами
Б а втотроф, що не здатний до фотосинтезу
В гетеротроф, що живиться рослинними рештками
Г гетеротроф, що розкладає органічні речовини
до неорганічних
3. Розгляньте схему трофічної мережі. Визначте, який
із зображених організмів є консументом третього порядку. А лисиця Б заєць В жаба Г синиця

4. Скориставшись правилом екологічної піраміди, визначте
центів, необхідну для існування в екосистемі
суха маса яких становить
6.
8.

відлітають далеко на південь. Унаслідок цього видовий склад і трофічні мережі літньої та зимової екосистем істотно відрізняються. Утім зміни в екосистемах не обов’язково
Одні угруповання організмів можуть змінюватися на інші,
екосистемі


Тому в прикладі лісове озеро й заболочувалося. Ці незбалансованості спричиняють зміну умов біотопу й видам, пристосованим до старих, жити стає «незручно». Зате інші види в нових, видозмінених біоценозом, умовах отримують перевагу й витісняють попередні. У результаті біоценоз змінюється: популяції одних видів зменшуються й зникають, а інших — збільшуються й починають

сформувалася пустеля Аралкум. Також причиною сукцесії
складу продуцентів, і, як наслідок, консументів у степовій екосистемі. Хоча буває й навпаки: припинення випасання в заповідниках, створених на місцях колишніх пасовищ, є причиною витіснення трав’янистої рослинності кущами. Якщо в результаті сукцесії сформується така екосистема, у якій зміни середовища, спричинені одними видами, компенсуються
Завдяки первинній сукцесії екосистема виникає там, де її до цього не існувало
Розрізняють два основних типи сукцесій: первинну та вторинну. Якщо сукцесія розпочинається на територіях, де раніше не мешкали організми (скелі, застиглі потоки вулканічної
кам’янистих субстратах
лишайники, які руйнують породу та збагачують її поверхню доступними мінеральними речовинами. Завдяки цьому формується первинний ґрунт, на якому проростають мохи й найневибагливіші трав’янисті рослини. Далі, залежно від місцевих

вості полягає в тому, що пісок не тримається на одному місці
вітром.
сповільнюють пересипання. На них
комахи. Поласувати останніми приходять ящірки. Згодом осока ще більше закріплює ґрунт своїми кореневищами. На малорухомому ґрунті з’являється шар решток, на якому оселяються однорічні

екосистеми Сукцесії
леглих екосистем.
неосвоєним ділянкам. На початкових стадіях сукцесій

до екосистеми.
структурі. Вивченням таких особливостей займається наука біогеографія. Завдяки
і біогеографинь було з’ясовано, що для більшості груп організмів зі збільшенням географічної широти розташування наземної екосистеми (тобто чим далі вона розміщена від екватора і ближче до полюса) зменшується видове різноманіття (рис. 18.6). Тому екваторіальні й тропічні екосистеми характеризуються більшим різноманіттям організмів, ніж помірні й полярні. Крім того, видове різноманіття відмінне в екосистемах, розташованих на різній довготі: так, у каліфорнійських лісах на 45-ому

як вони еволюціонували, у яких групах відбувалася адаптивна радіація,
видів певного регіону. Ці види надалі розселялися територією
різноманіття екосистем є абіотичні умови середовища.
вища, тому й видове різноманіття в них більше. Згодом
Б
В відновлення змішаного лісу на схилі гори після буревію
Г зміна рослинного угруповання на полі, де випасають худобу
3. Яка риса НЕ притаманна клімаксній екосистемі?
А ма ле видове різноманіття
Б низька швидкість колообігу речовин
В дуже розгалужена трофічна мережа
Г баланс процесів використання й відновлення ресурсів
4. Із наведеного
1
2
4

6.
7.
8.
Людина створює агроценози, щоб прогодувати себе
Тривалий час людські спільноти існу-
вали за рахунок того, що їм удавалося віднайти чи вполювати в природі. Лише
близько 10 тис. років тому на Близько-
му Сході в регіоні Родючого півмісяця (рис. 19.1) в процесі неолітичної революції люди перейшли до осілого способу

життя з використанням землеробства й тваринництва (про це йтиметься у § 39). Із того часу все більші площі суходолу використовуються для висівання окультурених рослин і випасання одомашнених тварин. Такі, створені людиною для отримання сільськогосподарської продукції, екосистеми
мами1, а угруповання
їжі, виробляючи близько 2,5

територія,
окультурення рослин
одомашнення тварин
1. Середземне море.
2. Аравійський півострів.
3. Перська затока.
цієї площі обробляється як рілля, а решта — це пасовища. В Україні більше 60 % земель використовують для сільськогосподарських потреб. Усі агроекосистеми можна поділити
мерські угіддя, що обробляються завдяки м’язовій силі людини й тварин,
великі сільськогосподарські



добрива Однією з основних рис екосистеми є відносна замкненість колообігу хімічних елементів. Для агроекосистем такий колообіг є незамкненим. Річ у тім, що людина систематично вилучає частину біомаси у вигляді врожаю чи приплоду. Тому хімічні елементи не повертаються редуцентами до ґрунту, що спричиняє швидке виснаження мінеральних запасів. Унаслідок цього продуктивність агроекосистеми повинна б швидко зменшуватися з часом. Аби запобігти цьому й відновити запаси мінеральних речовин у ґрунті, у сільськогосподарські землі систематично вносять добрива. Додавання недостатньої кількості

агроценозу. Для того, щоб продуктивність угідь була максимальною, господарі намагаються мінімізувати конкуренцію між видами й
полях чи у великих садах
один або кілька домінантних видів. Решта конкурентів і шкідників



що
тримання поточного
гору над культурними і відбувається сукцесія, під час
тя зростає, а продуктивність зменшується. Також для сільськогосподарських екосистем характерні періодичні спалахи чисельності окремих видів — гризунів, комах-шкідників, паразитичних грибів. Це зумовлено тим, що механізми регуляції чисельності

ляє більш ефективно використовувати ґрунтові
рослини різних видів відрізняються своїми вимогами до них. Наприклад, бобові потребують більше Цинку, а картопля — Бору. Тому якщо провести сівозміну бобових на картоплю, то запаси як Цинку, так і
вичерпуватимуться повільніше. Окрім того, різні культури мають відмінну стійкість до шкідників, приваблюють різних комах
впливають на мікробіологічні характеристики ґрунту, що підвищує загальну стійкість екосистеми. Час від часу протягом сівозміни

і пестицидів, що вносяться в поля й сади, повинна бути


А винищенню видів-конкурентів для сільськогосподарської культури
Б розведенню культурних і диких рослин поряд
В ма ксимально щільному засіванню території
Г збільшенню кількості сонячної енергії, що надходить
3. Схильність агроекосистеми до сукцесії зумовлена
А унесенням добрив
Б відсутністю редуцентів
В нестабільністю агроценозу
Г високою розгалуженістю трофічних
4. Використання досконаліших сортів і порід у господарстві дозволяє
А зменшити стійкість агроценозу
Б збільшити продуктивність агроценозу
В зменшити витрати на насіння
Г збільшити об’єми добрив, що вносяться
5. Увідповідніть захід для підвищення продуктивності
обґрунтування.
1 унесення адекватної кількості добрив
2 висаджування
окремих організмів на певній відстані
3 сівозміна
4 періодичний полив

А упровадження періоду для відновлення ґрунтових ресурсів
Б зменшення продуктивності окремої рослини
В підтримання оптимальної вологості ґрунту Г уникнення пригнічення росту через на длишок мінеральних солей Д зменшення конкуренції
яка має назву біосфера.
як і будь-яка екосистема, містить біотичний та абіотичний компоненти
редовище їхнього мешкання відповідно. Поняття «біосфера» 1875 року запропонував австрійський учений Едуард Зюсс, але найповніше розвинув
біосфери у своїх працях Володимир Вернадський — геніальний учений,
ший президент Української академії наук.
Межі біосфери визначаються діапазоном
та в землі (рис. 20.1), які

на всіх глибинах. Верхня межа біосфери сягає 20–22 км
живого визначається озоновим шаром (20–30 км), вище за який ультрафіолетове випромінювання знищує всі живі організми. Більшість організмів мешкає в набагато вужчому шарі — від глибини кількох метрів під землею до кількох десятків метрів над поверхнею Землі. У планетарних масштабах біосфера невелика: її маса становить лише 0,1 %

ції, що забезпечуються розгалуженістю трофічних мереж і видовим різноманіттям. Завдяки міжвидовим взаємодіям, обміну організмами між екосистемами (наприклад, перельотам птахів, міграціями риб) і сукцесіям біосфера підтримує свою сталість у часі. Саме завдяки стійкості біосфера вже кілька разів переживала масштабні катастрофи (наприклад, кисневу катастрофу, льодовикові періоди), після яких утрачала мільйони видів (чого вартує
крейдяно-палеогенове вимирання, під час якого загинули динозаври разом із майже 75 % усіх видів Землі), але все одно відновлювалася.
Біосфера характеризується централізованістю. Як зазначав
Вернадський, «організми формують основу біосфери та є її центральним компонентом».
Біосфера — відкрита система, тобто вона обмінюється речовиною
єю з іншими системами. Насамперед, це стосується сонячної енергії, без надходження якої існування біосфери є неможливим. У ній наявний
до космічного
елементів (рис. 20.2, А). Так, азотфіксувальні бактерії перетворюють азот на амоніак, сіркобактерії — окиснюють сполуки Сульфуру, а рослини — відновлюють сполуки Карбону.
Організми намагаються обжити кожну доступну ділянку Землі, адаптувавшись і змінивши умови середовища. У цьому полягає функція утворення середовища, що її здійснює жива речовина. Завдяки ній мінеральні породи руйнуються і включаються до колообігу елементів.
Також жива речовина постійно перетворюється: організми вмирають і народжуються знову, рештки розкладаються. Усе це забезпечує рух хімічних елементів і впливає на умови існування.
Постійний склад атмосфери підтримується діяльністю живої речовини. Організми поглинають і виділяють гази, і регулюючи таким чином їх уміст у повітрі. При цьому вони виконують газову функцію (рис. 20.2, Б). Поява киснеутворювальних організмів-фотосинтетиків змінила вигляд Землі й уможливила виникнення озонового шару, завдяки якому життя змогло вийти на суходіл.



Концентраційна функція полягає в накопиченні хімічних елементів
Середньорічна температура,


Рис. 20.3. Поширення наземних біомів А. Умови в наземних біомах. Б. Географічний розподіл біомів. 1 – тундра, 2 – тайга (хвойний ліс), 3 – листопадний і мішаний ліс, 4 — степ, 5 – пустеля, 6 – саванна, 7 – тропічний ліс. 1 2 3 4 5 6 7 30 15 1 100 200 300 400 0 Середньорічна кількість опадів, см
період тепла. Основою цього біому є лишайники, злаки й карликові
(рис. 16.3, А). Південніше, ніж тундра, розташована тайга, основою якої є хвойні дерева (рис. 15.4). Хвойні ліси тайги
також характерні тривалі
широтах переважають два типи біомів: листопадні
яскравий прояв сезонні зміни. Ці біоми зазнали найбільшого впливу людини, оскільки саме в них розташовані осередки розвитку цивілізації. Характерною особливістю
спеки. Як і в степах, тут живе велике різноманіття
кають.



розуміння, але можна
ризують уявлення вченого.
. Розселення людини по всій планеті та
. Глобалізація, зміцнення зв’язків
державами, формування глобальних інформаційних систем.
. Використання нових джерел енергії, що дає змогу людям стати найважливішою геологічною силою на планеті.
. Розвиток демократії, зростання добробуту людей, припинення війн.
. Розвиток науки, створення умов для вільного розвитку наукової думки, зростання ролі науки в житті людей.
. Розширення біосфери шляхом космічної експансії людства та підкорення інших планет.
Реалізація рис, наведених Володимиром Вернадським,
дозволити людині гармонійно співіснувати з природою. На жаль, наявність фінансової нерівності між верствами населення (мало багатих і багато бідних) і низький рівень добробуту спричиняють споживацьке



учених-біонавтів. Додатково доводилось підігрівати
1.

В верхня мантія на глибині 20 км
Г підводна печера глибиною близько 1 км
2. Централізованість біосфери забезпечується
А реалізацією функцій живої речовини
Б значним видовим різноманіттям
В здатністю рослин акумулювати сонячну енергію
Г сталістю умов неживої природи
3. Проаналізуйте рисунок 20.3, Б і визначте, які біоми найбільш характерні для України.
А тайга та листопадний і мішаний ліс Б степ і пустеля
В степ та листопадний і мішаний ліс Г тайга й степ
4. Умовою існування тропічного лісу є
А для цього біому характерна низька
В сюди надходить дуже мало світла Г температура довкілля надзвичайно
5. Увідповідніть функцію живої речовини
виділення вуглекислого
2
6.
7.

частині циклів знаходиться найбільша кількість атомів хімічного елемента. Основним джерелом енергії
енергію якого використовують організми для
діяльності. Оскільки все живе на 98 % складається з чотирьох хімічних елементів — Карбону, Оксигену, Нітрогену й Гідрогену, то в цьому параграфі йтиметься саме про їхні колообіги. Наявність біогеохімічних циклів дозволяє біосфері існувати
тривалого часу, оскільки забезпечує
Розкладання решток

паливних копалин (торфу, вугілля, природного газу, нафти) чи осадових порід, утворених, здебільшого, карбонатами (СО32-). А от ліси, попри те що поглинають десятки гігатонн вуглекислого газу на рік, приблизно стільки ж виділяють назад до атмосфери. Це в жодному разі не означає, що ліси некорисні для планети та їх вирубування
літосфери, поглинувши
резервуаром Оксигену є атмосфера, де він міститься, здебільшого, у вигляді молекул кисню й вуглекислого газу. Рослини
газ у процесі фотосинтезу. Також під час
ну молекул води. Унаслідок фотосинтезу

води й вуглекислого газу, які потрапляють у довкілля. Отже, завдяки процесам фотосинтезу й дихання виникає
біосферою й атмосферою (рис. 21.2). Частина атомів Оксигену, що містяться в організмах, переходять до літосфери у
(наприклад, вапняку): здебільшого, це черепашки молюсків і морських одноклітинних організмів. І, зрештою, існує безпосередній зв’язок між атмосферою й літосферою, бо процеси окиснення деяких речовин
поживних речовин у кисні відкрило перед живим світом нові можливості й сприяло появі багатоклітинних організмів та

Він є необхідним компонентом як носіїв спадковості — нуклеїнових кислот, так і білкових каталізаторів — ферментів, а також багатьох інших сполук, наприклад хлорофілу чи
на
організмами тому, що хімічний зв’язок у молекулі N2 дуже міцний, і щоб розірвати його, необхідна велика кількість енергії. У промисловості для того, щоб розірвати зв’язки в цій молекулі, наприклад, для виробництва амоніаку, потрібні висока температура, тиск і каталізатор. У природі з цим завданням можуть упоратися лише деякі ґрунтові мікроорганізми — азотфіксувальні бактерії.
(N2) у
рослин), але є й азотфіксатори, що вільно живуть
роді пов’язані з діяльністю бактерій. Нітрифікувальні бактерії трансформують амоніак, що утворюється азотфіксувальними бактеріями, на нітрити (NO2-) та нітрати (NO3-), які рослини можуть використовувати для синтезу нітрогеновмісних органічних сполук. Тварини
поїдаючи



при змиванні азотних
кає евтрофікація, про яку йшлося в
Іншим шляхом потрапляння Нітрогену до ґрунту є випадання його із кислотними опадами. Оксиди Нітрогену, що утворюються як викиди промисловості й транспорту1, потрапляють до атмосфери, де, взаємодіючи з водою, утворюють нітритну (HNO2) і

2. Які
процеси мають взаємопротилежний вплив на концентрацію вуглекислого газу в атмосфері?
А дихання й розкладання мертвих решток
Б використання людиною паливних копалин і дихання
В розкладання мертвих решток і фотосинтез Г фотосинтез і хемосинтез
3. Під час якого процесу ґрунт збагачується оксигеновмісними сполуками?
А дихання Б поглинання рослинами оксигеновмісних солей
В розкладання мертвих решток Г утворення осадових порід
4. Завдяки яким організмам кількість
А амоніфікувальним бактеріям Б азотфіксувальним бактеріям
В нітрифікувальним бактеріям Г денітрифікувальним бактеріям
5. Увідповідніть тип бактерій і перетворення, які вони здійснюють.
1 нітрифікація
2 денітрифікація
3 азотфіксація
4 амоніфікація

А NH 3 NO3-
Б N2 NO3-
В органічні речовини NH3
Г N2 NH 3
Д NO3- N2
6.
8.





Питання
Цим параграфом ми починаємо новий розділ, що буде присвячений взаємодії людини й навколишнього середовища. Усі аспекти цього питання вивчає прикладна екологія, або наука про довкілля. Вона надзвичайно молода: її зародження відбулося у 1960-х роках у США. Поштовхом до об’єднання екологів-енвайронменталістів1 стала книга американської біо-
логині Рейчел Карсон «Мовчазна весна» (рис. 22.1), у якій авторка в стилі, доступному для широкого загалу, описувала наслідки впливу пестицидів на
довкілля й здоров’я людини. Основна ідея книги про
значний негативний вплив людини на навколишнє середовище стала єднальною для багатьох екоактивістів та екоактивісток. Також суспільний ажіотаж
підштовхнув



років добробут людей постійно зростає, а стан екосистем погіршується, хоча благополуччя людства пов’язане
лишнього середовища. На їхню думку, пояснення парадоксу полягає в тому, що, по-перше, завдяки використанню досконаліших технологій, людство легше

ватиме на Землі, сягне майже 10 млрд осіб. Найбільший вклад у ріст чисельності роблять країни Південної та
Південно-Східної Азії, Африки й Латинської Америки, де щорічне зростання кількості людей перевищує
2 %. Тоді як у розвинутих країнах ріст є незначним, або чисельність навпаки зменшується.
Оскільки джерелом усіх продуктів, товарів та енергії є природа, то й вплив на неї зростав прямопропорційно чисельності. Про наслідки таких
відносин ітиметься в наступних параграфах. А до цього варто окреслити загальні екологічні проблеми, що вже існують.
Забруднення є найбільшою екологічною проблемою сучасності Оскільки обсяги продукції
то й відходів виробництва утворюється щороку мільярди тонн. Наприклад, у процесі добування корисних копалин з’являються
не містить потрібного ресурсу (рис. 22.3, А). Колосальні об’єми газів викидаються в атмосферу промисловими виробництвами, а разом із ними туди потрапляють різноманітні шкідливі речовини й дрібні часточки пилу. Також, коли якийсь товар стає непотрібним чи



впливають на природні екосистеми. Так, міське освітлення порушує фотоперіодизм у рослин, підвищення температури
ня (рис. 22.3, В), а радіація

мутагенним фактором.
Одними з найбільших забруднювачів є міста, кількість населення

Темпи

різноманіття (рис. 22.5). Оскільки життя
біоценозів екосистем залежить від стану
абіотичного середовища, то вплив на біотоп різних забруднювачів, а також зміна температури й вологості призводять до змін умов існування організмів. Окрім цього, велика роль у скороченні чисельності популяцій і вимиранні належить безпосередньому впливові людини. Зі зростанням кількості населення на планеті, збільшувалася й потреба в їжі. Тому, щоб себе прогодувати, люди безупинно полювали, виловлювали рибу, аж поки не «з’їли» цілі біологічні види. Задля створення полів вирубувалися величезні площі лісів — найбагатших
є 11 тис. га абсолютно заповідної
Отже, зміна середовища мешкання, скорочення площ природних екосистем, безпосереднє винищення організмів є основними
значного вимирання багатьох видів організмів. Близько
тварин зникло з лиця Землі за останнє





ністю. Окрім того, швидкість
води» (евтрофікації), які є наслідком інтенсивного розмноження ціанобактерій (рис. 22.6, Б)
го
Г висунула «парадокс довкілля»
2. Що з наведеного НЕ є джерелом
А вуличні ліхтарі Б
В сільськогосподарські поля Г зсуви гірського ґрунту
3. Проаналізуйте графік на рисунку 22.5 і виберіть правильну відповідь.
А найвищий темп вимирання видів спостерігається останні 50 років
Б темп вимирання біологічних видів то збільшується, то зменшується
В темп вимирання видів є орієнтовно
1
3

5.
6.
8.
що потрапляють до навколишнього середовища під час виробництва, транспортування, використання товару, а також із його рештками. І якщо, наприклад, смартфон важить близько 150–200 г, то відходів, пов’язаних із ним, утворюється близько 80–90 кг! На жаль, таке співвідношення характерне не лише для смартфонів — у розвинених країнах у середньому лише 1–1,5 % від маси добутої природної сировини потрапляє до складу кінцевого продукту, а решта перетворюється на відходи.
Екологічні проблеми, пов’язані із забрудненням, залежать від рівня економічного розвитку країни (рис. 23.1). Для держав, що розвиваються (зокрема й України), характерний високий рівень промислового забруднення, яке завдяки ретельному контролю вдалося значно скоротити в розвинених

викидів
зовсім інші. Крім того, забруднювачі
рення далі екосистемою. Так, наприклад,
Таблиця
Тип
забруднення

Хімічне
Фізичне
Механічне (засмічення)
Біологічне
Приклади
забруднювачів
Газуваті оксиди (СО2, SO2, NO, NO2), важкі метали, пестициди, надлишки мінеральних добрив, органічні розчинники, кислоти
Світло, шум, тепло, радіація
Промислові відходи, тверде
побутове сміття
Хвороботворні організми, інвазійні види
Метод визначення наявності забруднення
Перевищення ГДК чи ГДЕН (якщо трапляються в природі), наявність (для синтетичних речовин)
Перевищення ГДР чи ГДЕН
Перевищення гранично допустимого рівня утворення й накопичення Почастішання порушень здоров’я й розвитку хвороб, порушення стабільності природних екосистем
(ГДР), що характеризує, наприклад,
тромагнітного
(ГДЕН), яке визначає
допустиме
екосистеми й не перешкоджає її відновленню. Якщо навантаження є більшим за ГДЕН, то середовище поступово забруднюється. Порівнявши вміст, інтенсивність, кількість чи інший параметр із гранично допустимим, можна визначити, чи є цей вплив таким, що спричиняє зміни в довкіллі чи здоров’ї людини, тобто чи є він забруднювачем.
металів (переважно Плюмбумом, Купрумом і Цинком), продуктами розкладу полімерів, органічними розчинниками, кислотами, синтетичними мийними засобами. Деякі з цих речовин здатні накопичуватися в організмах і спричиняти порушення їхньої життєдіяльності та мутації. Ґрунт забруднюється як промисловими відходами, так і пестицидами та надлишками мінеральних добрив. Таке забруднення призводить до зменшення біорізноманіття й зміни складу біоценозів, зниження родючості ґрунтів. Фізичне й механічне забруднення спричиняють погіршення умов існування організмів До фізичного забруднення відносять

рівні хімічного та фізичного забруднення в містах є значно
Надзвичайно небезпечним є радіаційне забруднення. Основні його
атомна енергетика (виробництво ядерного палива, робота





23.3. Наслідки механічного забруднення А. Лелека, тіло якого заплуталось у пластикових пакетах, не може нормально літати. Б. Труп альбатроса, що загинув від
травній системі пластикового непотребу. В. Вода, зібрана з поверхні
тихоокеанської сміттєвої плями.

неживої природи, що не впливають хімічно чи фізично. Здебільшого це тверде сміття, що повільно руйнується: пластикова тара й пакети, металобрухт, вироби із гуми
скляні пляшки. Його накопичення перешкоджає
функціонуванню наземних екосистем, наприклад, зменшується проникність для світла, кисню й вологи. Також «нешкідливе» сміття насправді є небезпечним для
через особливості розташування течій сформувалася Велика тихоокеанська сміттєва пляма площею близько 1 млн км2 (понад півтори площі України!), на поверхні води у якій плаває



Рис. 23.4. Приклади інвазій А. Розселення колорадського жука Європою. Б. Борщівник Сосновського — один із найпоширеніших інвазійних видів в Україні.
ські, промислові й побутові стоки, трупи сільськогосподарських тварин, звалища сміття. Якщо біологічним забруднювачем є рослини чи тварини, то говорять про інвазії.


Згідно зі статистикою кожна шоста передчасна смерть у світі спричинена забрудненням довкілля, а це втричі більше смертей, ніж від СНІДу, малярії та туберкульозу разом узятих. На жаль, рівень забруднення території Україні є дуже високим: відповідно до даних Інституту впливів на здоров’я щороку лише від брудного повітря помирає 80 українців зі 100 тис. населення. Найбільш
Помірно
Забруднені
Дуже забруднені
Зони екологічної


Запорізької, Донецької, Дніпропетровської,
Запорізькій, Херсонській, Миколаївській
важких металів, тоді як на Півночі й Заході
В велику кількість кисню, що утворюється під час розкладання сміття
Г гірший розвиток інвазійних видів на сміттєзвалищах
2. Виберіть подію, що НЕ є наслідком біологічного забруднення.
А загибель популяцій окремих видів
Б збільшення видового різноманіття екосистем
В руйнування трофічних мереж
Г збільшення кількості хвороб, що спричинені бактеріями
3. Оскільки вміст важких металів у ґрунтах Запорізької і Миколаївської
областей перевищує ГДК, а пестицидів — не перевищує, то
А ґрунти Запорізької області є чистіші за ґрунти Миколаївської

7.
8.
цього середня температура
десять років (рис. 24.1).
Таблиця

Вуглекислий газ (СО2)
Водяна пара (Н2О)
Нітроген(І) оксид (N2O) Зміна
Метан (СН4)
Джерело
Спалювання викопного палива
Випаровування з перезволожених полів, штучних
Виділення мікроорганізмами, що живуть у кишківнику домашньої худоби, компості, на сміттєзвалищах; вивільнення під час добування вугілля, добування й транспортування природного газу Спалювання біомаси, викопного палива, денітрифікація надлишків нітрогеновмісних добрив
бездощів’я, зростатимуть і досягнуть половини всієї




рову, геотермальну, енергію біомаси тощо) є найперспективнішим напрямком розвитку енергетики з огляду на зменшення викидів. Утім, ці
Таблиця
Забруднювач
Тверді частинки
Леткі
органічні
сполуки
Чадний газ (СО)

Нітроген оксиди (NO, NO2)
Cульфур(IV)
оксид (SO2)
Сполуки
Плюмбуму (Pb)
Органічні
забруднювачі
Погіршує функціонування
дихальної системи
Сприяють формуванню
озону, мають канцерогенну
дію1
Блокує перенесення кисню
гемоглобіном, стимулює
розвиток серцево-судинних
захворювань
Сприяє виникненню кислот-
них опадів, формуванню
озону, стимулює розвиток
захворювань дихальної
системи
Сприяє виникненню
кислотних опадів
Накопичуються в організмі й спричиняють різноманітні порушення його роботи
Токсичні речовини, що мають канцерогенну дію
Сірчистий газ (SO2) та оксиди Нітрогену
опадів. Кислотні опади (кислотні
Джерело антропічного забруднення
Дим від горіння палива, пального чи сміття, пил Неповне згоряння викопного палива, випаровування розчинників і бензину, викиди виробництв
Неповне згоряння палива
Згоряння викопного палива й автомобільного пального, пожежі
Згоряння викопного палива
Виробництво батарей, виплавка свинцю, згоряння викопного палива, пального й сміття
Згоряння викопного палива й автомобільного пального, випаровування розчинників, будівельні
опадів (туман, дощ, сніг, град), за яких кислотність розчину є більшою за звичайну (рН2 < 5,5). Основними кислотами, що спричиняють підвищення кислотності, є сульфатна (H2SO4) та нітратна (HNO3). Cульфур(IV) оксид під дією окисників перетворюється на сульфур(VI) оксид (SO3), який під час розчинення у воді утворює сульфатну кислоту. У такий спосіб утворюється й нітратна кислота. Випадіння


екзоскелети на основі карбонатів (у форамініфер, коралів, молюсків), збільшується вимивання мінералів водою. Такі дії спричиняють вимирання популяцій і значні зміни видового складу екосистем (рис. 24.4), заболочування озер, зміну хімічних характеристик ґрунтів. Перешкодити цьому можна, відфільтрувавши оксиди із атмосферних викидів виробництв та зменшивши вміст Нітрогену в автомобільному пальному, або перейшовши на інший вид «пального» (водень, електрику, м’язову силу).
Озонові діри в атмосфері є наслідком забруднення атмосфери галогеновмісними органічними сполуками
Озоновий шар — це збагачена озоном (О3) частина стратосфери на висоті 20–30 км. Його молекули кисню й озону поглинають

ультрафіолету починає потрапляти на організми та спричиняє пришвидшення старіння шкіри, появу мутацій і виникнення раку шкіри (меланоми), розвиток катаракти (помутніння кришталика ока), загибель бактерій і, як наслідок, зменшення врожаїв. Причиною появи озонових дір були леткі галогеновмісні органічні сполуки. Від них під дією ультрафіолетових променів відщеплюються атоми Хлору й Брому, що стають каталізаторами руйнування молекул озону.




загострення хронічних і збільшення кількості гострих хвороб дихальної системи, підвищує частотність
токсичними речовинами. Наприклад,
смог у Лондоні (рис. 24.6, А), що тривав чотири дні в грудні 1952 року, спричинив загибель близько 12 тис. людей у наступні місяці.
в повітрі (рис. 24.6, Б).




Рис. А. Молекула дифлуородихлорометану (фреону R-12).

Рис. Б. Полярні стратосферні (перламутрові) хмари пришвидшують утворення хлор-радикалів.
з винайденням у 1920–30-х роках ефективних методів синтезу флуорохлоровуглеводнів з’явилась можливість заміни амоніаку як холодоносія (хладогену) в холодильних установках і кондиціонерах. Ці речовини є нетоксичними й зручними, оскільки хімічно інертні (не горять і не вибухають, не взаємодіють із металами, кислотами, лугами), мають близькі до нуля температури кипіння й великі питомі теплоти випаровування й теплоємності. Завдяки цим властивостям вони не руйнують охолоджувальні системи й поглинають багато теплоти. Також такі холодоносії легко зріджуються, що дозволило використовувати їх і в аерозольних балончиках.
Але вже у 1960–70-х роках стало зрозуміло, що фреони (рис. А), як почали називати флуорохлоровуглеводні за найменуванням торгової марки одного з перших їх видів, значно пришвидшують руйнування озону
1.

2.
зміна океанічних течій Г зростання кількості ультрафіолетових променів
3. Які схеми реакцій ілюструють процес утворення сульфатної кислоти
в атмосфері ([O] позначає окисник)?
А SO2 + SO3 + H2O H2SO3, Н2SO3 + [O] H2SO4
Б SO2 + [O] SO3, SO3 + H2O H2SO4
В SO + [O] SO2, SO2 + H2O H2SO4
Г SO3 + Н2О Н2SO3, Н2SO3 + [O] H2SO4
4. Зазначте дію, що сприяла відновленню вмісту озону в стратосфері.
А обмеження викидів вуглекислого газу
Б встановлення газових фільтрів на заводах
В заміна теплоносіїв у холодильниках
Г перехід на використання сонячної енергії
5. Увідповідніть забруднювач і
1 фенол
2 сульфур(IV) оксид
3 трихлорофлуорометан
4 частинки сажі
атмосферу.
утворення фотохімічного смогу
випадіння кислотних опадів
збільшення хмарності Г утворення димового смогу
руйнування озонового шару
У житті все просто
6. Яку екологічну проблему відображає малюнок? Запро-
понуйте кілька змін у повсякденні, що дозволили б зменшити вашу участь у розвитку цієї проблеми.
7. Чи можна повністю уникнути утворення кислотних опадів? Як нейтралізувати їхній

оксидом, тому при розчиненні у воді він утворює слабку карбонатну кислоту (Н2СО3). Через
поглинання СО2 океанами зросла її концентрація у воді. Це спричинило збільшення кислотності приблизно на 0,1 рН за останні 250 років. Така зміна негативно впливає на організми, до складу скелетів яких уходить кальцій карбонат (вапняк) через те, що за підвищеної кислотності він поступово розчиняється, і кількість доступних карбонат-іонів у воді зменшується. Одноклітинним еукаріотам, коралам і молюскам за таких умов складніше будувати й підтримувати зовнішні вапнякові скелети (рис. 25.1). Оскільки коралові рифи є домівкою для 25 % усіх видів морських організмів, то внаслідок зникнення рифів можуть загинути тисячі інших організмів. Не варто
забувати й про закислення




рівень підвищиться ще на 0,6–2,7 м щодо рівня 2010 року. Найбільше від цього постраждають острівні держави, середня висота території яких часто не перевищує 1–3 м над рівнем моря. Наприклад, до 2100 повністю або частково «потонуть» Мальдіви, Соломонові й Маршалові
розташованих на узбережжі, можуть
берегів пришвидшиться
біологічне забруднення гідросфери Звичайно ж, кількість чистої води зменшується також і
Основними забруднювачами гідросфери є патогенні мікроорганізми, гельмінти
та хімічні речовини (табл. 25.1).
Таблиця 25.1. Основні
Природа забруднювача
Біологічна

Хімічна
Вид забруднювача
Мікроорганізми, гельмінти та їхні яйця
Рештки життєдіяльності організмів
Неорганічні речовини
Органічні речовини
Джерело
антропічного
забруднення
Екскременти інфікованих людей і тварин із
каналізаційних стоків та змивів ферм
Дощові й каналізаційні стоки, змиви ферм
Стічні води виробництв, змиви з полів, прориви дамб відстійників, каналізаційні стоки, атмосферні викиди
Стічні води виробництв, змиви з полів, розливи нафтопродуктів
Разом із екскрементами хворих тварин і людей до води потрапляють збудники численних небезпечних хвороб: черевного тифу, холери, дизентерії, сальмонельозу, гепатиту, гельмінтозів1. При вживанні брудної води, немитих продуктів харчування чи
Дія на природу й організм людини
Порушення обміну речовин, отруєння організму, руйнування тканин
Під час гниття поглинається розчинений кисень
Отруюють організми, спричиняють евтрофікацію, засолення й закислення водойм Отруюють організми, порушують газообмін і освітлення у воді

до водойм неочищених каналізаційних
у воді зменшується у 2–5 разів, що спричиняє його нестачу для водних
мів, які починають гинути. Такі «мертві
впадіння рік, що приносять рештки, у



і зважених частинок, прозорість, колір,
Однією з найважливіших характеристик
кисню — кількість кисню, що
речовин.
визначення стану водойми


1.

має рацію?
А лише Арсен Б лише Дарина В обидвоє Г жоден
3. Одним із способів економії води на виробництві є
А використання води для охолодження
Б охолодження обладнання за допомогою вентиляторів
В одноразове використання води для промивання руди Г очищення стічних вод після використання
4. Увідповідніть
1 вуглекислий
8.
цими методами?
не тільки
шар біосфери, але й внутрішні пласти літосфери. Унаслідок цього зникають природні екосистеми, порушується ґрунтовий покрив, забруднюються й
нюються поверхневі та підземні води. Шахти й кар’єри, що з’являються
час розробки родовищ, часто є



є ґрунт, що забезпечує
зії полягає в погіршенні зчеплення частинок ґрунту внаслідок розорювання, надмірного випасу худоби, вирубки лісів. Через ерозії українські чорноземи щороку втрачають близько 19 млн т гумусу. Також ґрунтовій ерозії сприяють надмірна чи недостатня зволоженість ґрунту, що часто є наслідком зміни річкового й ґрунтового водостоку. Так, наприклад, в Україні нині підтоплено понад 50 тис. га зрошуваних земель. У посушливих регіонах, що охоплюють понад 40 % суходолу, антропічна ерозія спричиняє опустелювання (рис. 26.2, А). У його процесі земля стає неродючою, легко руйнується вітрами, що породжують пилові бурі. Процесам опустелювання сприяє глобальне потепління
яких зменшується кількість опадів у посушливих місцях. Найефективнішим способом
лісу. Кенійська громадська діячка, лауреатка Нобелівської
гарі Маатаї 1970 року заснувала загальноафриканський
учасниками й учасницями




йшлося у § 14), через що
внесення добрив повинні бути добре розрахованими та відмінними навіть для сусідніх ділянок поля, якщо їхній хімічний склад відрізняється.
Іншим джерелом забруднення є пестициди, якими обробляють поля й сади для боротьби зі шкідниками (бур’янами, рослиноїдами, паразитами) (рис. 26.3, А). Ці речовини негативно впливають не тільки на ті види, проти яких спрямована їхня дія, але й на інші організми, що проживають у агроекосистемах чи поряд із ними, тому що часто передаються харчовими ланцюгами. У результаті порушуються нормальні процеси функціонування екосистем, загальмовується відновлення гумусу. Крім того, оскільки шкідники стають дедалі стійкішими до пестицидів, то ефективність цих препаратів знижується. Сучасні агрохімікати повинні швидко розпадатися в природі й діяти лише на певну групу — на організми-шкідники.
Під час роботи на полях важка техніка стає джерелом забруднення території мастилом, пальним, аерозолями й відпрацьованими газами. Також, здіймаючи куряву, трактори, комбайни й вантажівки є причиною пилового забруднення угідь, що призводить до зменшення ефективності фотосинтезу. Тому лише справна сучасна



ферм чи приватних господарств (рис. 26.3, В). Зараження ґрунту надмірною кількістю невластивої
цеси в ньому, що виявляється
й ерозії. Контроль за такими
оскільки продуктивність вирощування худоби
якості розташованих поряд пасовищ.
Зрештою, забруднювачі до ґрунту
опадами. Яскравим прикладом
няють закислення середовища. Таке
тільки



Правильна утилізація побутових відходів є необхідним заходом у боротьбі із забрудненням Щороку кожен з українців у середньому створює близько 250 кг твердого побутового сміття, основними компонентами якого є папір, харчові рештки й бадилля, пластик, метали, резинові вироби, тканини, скло, деревина. Рівень утилізації побутового сміття в Україні за різними оцінками сягає 1–5 %, а основна його кількість накопичується на




Під час сортування разом збираються ті відходи, що можна використати для однотипної повторної переробки чи знищення: пластик, скло, папір, харчові відходи, електроприлади (рис. 26.5, В). Отримані групи сміття надалі намагаються максимально повторно використати: із паперу, наприклад, роблять картон, пластик і метали переплавляють у нові вироби, із харчових відходів отримують органічні добрива. Для того, щоб спростити сортування і переробку матеріалів, виготовлених
лу, їх позначають спеціальними міжнародними
лізацію сміття до такого рівня,

документи якнайбільше замінятися електронними носіями інформації. Упровадження біодеградабельних матеріалів у
сприятиме швидкому руйнуванню сміття в природі.
Численні держави світу, серед яких і Україна, упроваджують елементи природозбережливої освіти у
В швидке руйнування в природі та малий спектр видів, на які діють
Г швидке поширення харчовими ланцюгами та рідка форма 3. Оберіть групу відходів, що утилізуються разом.
А старі книги, картонні коробки, непотрібні паперові документи
Б ноутбуки, мобільні телефони, автомобілі
В поліетиленові пакети, зламані меблі, одноразовий пластиковий посуд
Г недоїдки, одяг, взуття 4. Увідповідніть антропічний вплив
1 видобування корисних копалин із-під землі
2 обробка полів тракторами
3 виливання стічних вод із тваринних ферм на поля
4 накопичення сміття на сміттєзвалищах
5.
6.

просто
7. Часто можна почути думку про те, що викинуті в сміття


маніття
Річ у тім, що стабільність екосистем і біосфери в цілому залежить від нього. До прикладу, в екосистемах із низьким біорізноманіттям стають можливими неконтрольовані зростання чисельності шкідників чи паразитів, витіснення одним видом інших тощо. А чим меншим буде екосистемне різноманіття біосфери, тим яскравіше проявлятимуться стихійні лиха, посухи, урагани тощо. Завдяки живій речовині в біосфері відбуваються колообіги хімічних елементів. У разі зменшення біорізноманіття вони можуть бути суттєво порушені. Тому, якщо ми хочемо, щоб біосфера існувала й надалі, ми повинні охороняти біорізноманіття.
Темпи зменшення біорізноманіття
вимирання

на фрагменти полями, дорогами, каналами, риболовецькими сітками, унаслідок чого

слизняк, рапана, сірий пацюк, сріблястий карась




існувати в екосистемах, збільшуючи їхні біорізноманіття й стійкість.

нізмів. У такого пристосування є генетично
акліматизуватися до умов, що знаходяться поза його діапазоном толерантності. Тобто теплолюбна рослина не житиме в холоді, а вологолюбна — у посушливих умовах. Окрім цього, акліматизація — це повільний процес й організми
Найчастіше інтродукція є штучним процесом, коли
новлення видів, що зникли чи зникають і підтримки



Полтавщині. Забруднення й глобальне
характерне найбільше видове різноманіття, страждають від непомірного винищення диких тварин, м’ясо яких є чи не єдиним
жілого населення країн. Навіть заборона полювання не зупиняє браконьєрів, особливо коли мова йде про природні продукти, які
ня навіть рідкісних

(рис. 27.6, Б).
рин (папуг, риб, змій, черепах) та
гантські масштаби. Водночас






ефективним засобом боротьби з гарячкою,
В

людина
Г під загрозою зникнення знаходиться кожен шостий вид на планеті
2. Заповніть пропуски в реченні про інтродукцію.
Під час інтродукції організми (1) й займають (2) в екосистемі.
А 1 – акліматизуються, 2 – увесь трофічний рівень
Б 1 – реакліматизуються, 2 – місце іншої популяції
В 1 – акліматизуються, 2 – вільну екологічну нішу
Г 1 – реакліматизуються, 2 – не менше половини біотопу 3. Наслідком забруднення середовища пестицидами НЕ є
А почастішання паразитарних інфекцій
Б збільшення частоти появи злоякісних пухлин
В погіршення можливостей акліматизації
Г посилення міжвидової конкуренції
4. Щоб зменшити надмірне
А дозволити полювання на рідкісних тварин
Б стимулювати проведення освітніх заходів на цю тему
В збільшити штрафи за завезення інвазійних видів рослин
Г посилити контроль над нелегальною торгівлею цуценятами
5. Увідповідніть тип впливу на біорізноманіття із наслідком діяльності людини.
1 руйнування місць проживання організмів
2 занесення видів-інтродуцентів
3 забруднення біотопу
4 надмірне винищення організмів
А закислення ґрунту
Б розвиток екосистеми на застиглій вулканічній лаві
В витіснення аборигенних видів інвазійним видом Г браконьєрство Д прокладання залізниці через ліс

1.
окремих областей України (дані за 2015 рік, без урахування тимчасово окупованих територій).
2. Для кожного параметра, що характеризує
ного у відсотках, заповніть порівняльну таблицю.
• Для розрахунку різниці між значенням параметра для вашої області та України загалом використайте формулу:
Характеристика

•
3. Для кожного параметра,

родних процесів, відбувається колообіг речовин
ватися. При цьому, щоб якість навколишнього середовища
вплив людини повинен бути врівноваженим
новлення. І мова йде

людську
Для
ство повинне керуватися принципами раціонального природокористування. Раціональне
що
а структура екосистем і колообіг речовин у них не має страждати. Бажано також, щоб технологічні процеси вивільняли до середовища відходи в мінімальних кількостях
такому
який розповсюджений у довкіллі. Тоді екосистеми будуть спроможні їх ефективно утилізувати.
2050 2100 2000 1950 1900 Час, роки

тися (рис. 28.1)
Ресурси
Народжуваність
Смертність
Кількість послуг, що припадає
на одну людину
Чисельність населення
Кількість їжі, що припадає
на одну людину
Рівень забруднення
Промислове виробництво, в розрахунку на одну людину
Надалі ми звернемо більшу
сталого розвитку
довкілля.
вищити продуктивність сільського
родні екосистеми й сприяти покращенню якості земель. Ціль №


більш досконалої техніки та покращених сортів і порід. Одним зі шляхів зменшення виснаження ґрунтів (дегуміфікації) є впровадження органічного фермерства — ведення рослинництва чи тваринництва без використання пестицидів, штучних добрив, гормонів і антибіотиків,
тично модифікованих організмів. Однак
няно з традиційним агровиробництвом,
зміну (дивись § 26) і полікультуру,
різні рослини (рис. 28.3). А от замінити пестициди в боротьбі зі шкідниками

цьому не

ючи шкоди природі.
Водовитрати
зменшити
Серед завдань, які потрібно виконати для досягнення цілі сталого розвитку № 6, є зменшення обсягів скидання неочищених стічних вод і підвищення ефективності во-
докористування.
Зрозуміло, що прямим шляхом зменшення кількості забруднених стічних вод є їхнє ефективне очищення, активними учасниками якого можуть бути й живі організми (рис. 28.4). Очищення також

дозволяє повернути до вжитку речовини, що зазвичай викидаються зі стічними водами (солі, йони металів, органічні розчинники), завдяки чому
видобування природних ресурсів, потрібних
Підвищення ефективності водокористування
виробництві
використовуватися сорти й породи, що пристосовані для зменшеного вживання води, економне зрошування, накривання землі (плівкою, дерев’яними ошурками, листям) для зменшення випаровування тощо. Не менш ефективною є й економія води в побуті: скорочення часу прийому душу, закривання води під час намилювання чи чищення зубів, рідше миття


сонячних
говуються, завдяки чому
Ба більше, кількість сонячних
і влада підтримує цей поступ. Гідроенергетика є джерелом

ня біомаси невпинно зростатиме.
того, не варто забувати про можливість
використання відходів для продукування біогазу (рис. 28.6).
Паралельно із переходом на

скільки ресурси нашої
виникло питання — коли людська цивілізація досягне межі демографічного й економічного зростання. Завдяки роботі Донелли й Денніса Медоуз, Йоргена Рандерса та інших було створено математич-
ну модель «World3». Вона містила важливі параметри, як-от: вироблення продовольства, розвиток промисловості, ріст населення, рівень забруднення й кількість
невідновлюваних ресурсів. Автори поєднали ці параметри за допомогою 16-ти диференційних рівнянь із
більш ніж 30-ма змінними й коефіцієнтами. Варіюючи останні, у 1972 році було розроблено 12 гіпотетичних сценаріїв розвитку людства, які було описано в
доповіді Римського клубу «Межі зростання».
П’ять із дванадцяти сценаріїв були песимістичними: відповідно до них на людство


(на рівні смертності 1975 року), обмеження капітальних інвестицій
вати, полягав у «м’якому» обмеженні народжуваності.
стверджували, що чим швидше ми почнемо контролювати ріст населення, то більші
шанси уникнути кризи. За 30 років у 2004 році
було переглянуто. Виявилось, що ріст чисельності населення,
2. Для боротьби зі шкідниками найменш екологічним методом є
А заселення на поля природних ворогів шкідників
Б використання вірусів і бактерій, що нищать шкідників
В засадження лісосмуг уздовж полів
Г обробка полів отрутохімікатами 3. Завдяки очистці стічних вод заводів
А корисні речовини повертаються в природний колообіг
Б менше токсичних речовин використовується у виробничих процесах
В підвищується ефективність використання природних ресурсів
Г погіршується
4. Отримання енергії шляхом спалювання біомаси

річок
Г збільшенню площ природних екосистем
5. Увідповідніть завдання сталого розвитку й шлях його досягнення.
1 збереження природних
екосистем
2 підвищення ефективності
водокористування
3 зменшення обсягів
скидання стічних вод
4 зменшення кількості
викидів СО2
А зменшення ерозії ґрунту
Б розвиток велоінфраструктури в містах
В відмова від використання генетично модифікованих культур
Г вчасний ремонт і заміна сантехніки
для уникнення протікань
Д очищення й повторне використання води на виробництві
що екологічно мислить, цікавиться станом довкілля, впливом своїх дій,
щодо природи, а також усвідомлює залежність людської цивілізації й життя та здоров’я кожної людини від стану навколишнього середовища. Такий тип мислення передбачає
нас хоч
приблизно рівну цінність. Тоді вся практична діяльність людини буде розглядатися крізь призму її
домашнє завдання — стане максимально дружньою до довкілля.
зменшиться.

вимирання Одним із проявів екологічного мислення є
із завдань сталого розвитку. Основним шляхом збереження внутрішньовидового й видового різноманіття є створення Червоної
вимирання. Станом на 2018 рік під загрозою зникнення в Міжнародній Червоній книзі знаходилося 26 тис. біологічних видів, що складає більше 1 % від усього описаного








Рис. 29.1. Тварини й рослини Червоної книги України А. Їжак вухатий. Б. Дрохва — «український страус». В. Гадюка Нікольського. Г. Устриця європейська. Д. Марсилія чотирилиста. Е. Півонія тонколиста.
Види, що занесені до Червоної книги, не можна ані збирати, ані полювати на них, їх не можна використовувати для отримання прибутку (наприклад, продавати букетики підсніжників). За порушення
заподіяння


А.

Чорноморський,
і найбільший та найновіший Чорнобильський радіаційно-екологічний біосферний заповідник (рис. 29.2, А). Природні заповідники, яких налічується в Україні 19, мають загальнодержавне значення й охороняють унікальні для країни екосистеми. Найбільшими серед них є Кримський і Рівненський (рис. 29.2, Б). У національних природних парках
але дозволено їх туристичне й



видів тварин і рослин, місць розмноження чи відпочинку тварин. Часто в них дозволено господарську діяльність у межах, що не перешкоджають збереженню охоронного об’єкта.
Унікальні елементи природи, угруповання чи сукупності можуть охоронятися завдяки створенню пам’яток природи. Старе дерево, скеля, гора, печера нерідко стають охоронними об’єктами в пам’ятках природи.
Охороняються державою також об’єкти, створені штучно. Це численні ботанічні сади, зоо- і дендропарки1, деякі пам’ятки природи й пам’ятки садовопаркового мистецтва (рис. 29.4). На жаль, надання території природоохоронного статусу в Україні
нацеєю від браконьєрів, несвідомих
копалин і






ну. В останньому, третьому, виданні
до складу природоохоронних
Незважаючи на заходи із захисту біорізноманіття,
видів у природі
На жаль, усі заходи, що вживаються для збереження біорізноманіття, все одно можуть бути марними. Через зниження якості довкілля частина видів вимирає. У останньому







Зелена книга України
Червоної тим, що А до неї занесено унікальні екосистеми, а не окремі види Б у ній схарактеризовано лише рослини, що вже вимерли В вона описує рослинні угруповання, а не окремі види
Г у ній міститься інформація лише про рослини й гриби
3. Школярі висловили свої думки про причини вимирання мандрівного
вали. Григорій думає, що
учнів має рацію?

1
2
3
4 ботанічний
5.
ведення сільського
дарства, але дозволено відпочивати



й виробництва;
• забезпечення сталого розвитку природно-ресурсного
• зниження екологічних
• удосконалення та розвиток державної системи природоохоронного

Рис. 30.2. Роль громадськості у


В Україні затверджено численні законодавчі акти, що регулюють природоохоронну галузь Правова охорона довкілля полягає у
громадян,
лишнім
заподіяну негативним впливом на довкілля.
Україна бере участь у міждержавному співробітництві
з питань охорони довкілля Один із законів екології Баррі Коммонера зазначає, що «усе пов’язано з усім» і процеси антропічної зміни природи не є винятком. Ще у § 23 ми говорили про те, що забруднення стало глобальним процесом,
утворення й
це впливу забруднювача можуть відділяти сотні й тисячі кілометрів

участь у транскордонних проектах
світі біосферним заповідником, розташованим
зація екологічних програм, пов’язаних із дельтою Дунаю,
України, Румунії
та Грузії. Між Україною
угоди про співробітництво в галузі охорони навколишнього
середовища, ядерної безпеки, управління водними ресурсами, змін клімату. Наша держава є активним учасником
ганізацій
Конвенція
Базельська конвенція про контроль

годження різними міністерствами


Б Стокгольмської конвенції про стійкі органічні забруднювачі
В Конвенції про збереження мігруючих видів диких тварин
Г Віденської конвенції про охорону озонового шару 3. Увідповідніть Закони України з цитатами
1 Про охорону навколишнього природного середовища
2 Про пестициди й агрохімікати
3 Про відходи
4 Про рослинний
світ

4.
5.
розділів. А визначення … системи заходів, пов’язаних з організаційно-економічним стимулюванням ресурсозбереження Б регулювання суспільних відносин у сфері охорони … мохоподібних, водоростей, лишайників В збереження природних ресурсів,





















тілесних недугів, то її можна вважати здоровою. Тому дослідження зосереджувалися на вивченні фізичного тіла людини, шляхів його убезпечення й лікування. Здоров’ям тоді вважали просто відсутність хвороби. Але в XIX ст. завдяки більш докладному аналізові психіки й суспільних процесів стало зрозуміло, що таке тлумачення здоров’я є дуже обмеженим. Здорова людина — енергійна, добре себе почуває, легко переносить стресові ситуації,
ка сотень різних визначень здоров’я. Найбільш
вважаємо
ров’я (ВООЗ): «здоров’я
це стан
фізичного, психічного й соціального1 благополуччя, а не тільки відсутність хвороб
фізичних вад». На жаль, точно сказати, чи повністю здорова
складно. Річ у тім, що багато хвороб і порушень мають безсимптомні
(наприклад, ВІЛ-інфекція може

соціальна
1
2
до життя в людському суспільстві. Також психічний і фізичний стани
бо як хвороба впливає на емоційний стан, так і від надмірних переживань погіршується тілесне здоров’я.
Утім, як би складно не було визначити, що таке здоров’я і який його стан, зрозуміло, що без гарного здоров’я не можлива самореалізація людини, досягнення успіху й щастя в житті. Тому саме здоров’я є однією з найвищих цінностей людського життя. Але на думку видатного українського хірурга Миколи Амосова, «щоб стати здоровим, потрібні
зусилля,

значні. Замінити їх немає
ризують (табл. 31.1). Водночас
Таблиця 31.1. Складники здоров’я
нормам, енергійність, адекватна реакція
довкілля, відсутність хвороб, наявність імунітету до них
Інтелектуальне Компетентність у певних сферах, уміння аналізувати й приймати раціональні рішення,
керувати емоціями, витримувати емоційні стреси, здатність

спільноти розробляють спеціальні анкети, способи ведення співбесід, зорові тести (рис. 31.2). На жаль, подекуди різні психологічні тестування, що використовуються для визначення однієї характеристики, дають різні результати.
Проблема виміру рівня соціального благополуччя
трібно спостерігати не
легко зробити й проаналізувати. Тому
людей (учнівства, робітничої


або соціоекологію), що
питаннями дії довкілля
здорового харчування займається дієтологія, статевого життя — сексологія. Очевидно, що основою цих дисциплін є біологія, яка вивчає розвиток і функціонування як організму людини, так і хвороботворних організмів, а також вплив середовища на живих істот.
Проблемами психічного здоров’я
діяльності, психіатрія — на
лікувальній

здоров’ї, але й чинники, що на нього впливають
існує навіть окрема галузь
соціологія медицини, що
вивченням ставлення людей до здоров’я й здорового способу життя, особливостей поведінки під час хвороби й лікування, впливу системи охорони здоров’я на різноманітні параметри суспільства.
Отже, єдиної науки, що займалася б вивченням усіх аспектів здоров’я, не існує. Створене в 1980-х роках у Радянському Союзі

Рис. 31.3. Посох Асклепія (А) та келих Гігієї (Б) є найпоширенішими символами медицини й походять із грецької міфології Рис. 31.4. Сеанс психотерапії Бесіди
ціалістом.
А хвора людина гірше керує своїми емоціями
Б під час хвороби може
В одужання збільшує рівень взаємоповаги між людьми
Г причиною хвороби є зниження імунітету
3. Який із наведених параметрів характеризує фізичне благополуччя людини?
А вага тіла 50 кг Б уміння співпереживати
В відсутність карієсу Г розуміння загальнолюдських цінностей
4. Однією зі складових психічного здоров’я людини є
А відсутність фізіологічних порушень
Б навички емоційного самоконтролю
В уміння знаходити спільну
Г м’язова витривалість
5. Увідповідніть науку,
1
3 епідеміологія
4 психотерапія

6.
7.
Здоров’я людини залежить від багатьох чинників різної природи На шляху до пошуку відповіді на питання «як бути здоровим?» необхідним кроком є визначення того, від чого ж залежить наше здоров’я. Було проведено багато досліджень, щоб віднайти чинники, які впливають на здоров’я. У результаті виокремили 5 основних груп чинників (табл. 32.1, рис. 32.1), впливи яких поде-
куди залежать не стільки від дій самої людини, як від суспільної організації (рівня медичного обслуговування, чистоти довкілля тощо).
Однак, найбільш суттєвий вплив здійснюють
фактори, пов’язані з поведінкою людини: її соціальне становище й спосіб життя.
Таблиця
32.1. Чинники впливу на здоров’я
Група чинників
Стан довкілля
Медичне
обслуговування
Спадковість і
параметри тіла
Соціальні умови
Спосіб життя

Рис. 32.1. Діаграма усередненого впливу різних груп чинників на здоров’я 1 – спосіб життя, 2 – соціальні умови, 3 – спадковість і параметри тіла, 4 – медичне обслуговування, 5 – стан довкілля.
Чинники
Якість води, повітря, ґрунту, продуктів
харчування, умови клімату, властивості техногенного середовища Доступність і якість медичного обслуговування, освіченість у питаннях здоров’я
Генотип, стать, вік, зріст, вага, фізіологічні та
анатомічні риси
Умови праці, наявність дискримінації, умови
проживання, культура й традиції, дохід, рівень освіти й грамотність
Фізична активність, харчовий раціон, режим відпочинку, шкідливі звички, статеве життя, рівень стресу, рівень оптимізму
Умови природного й антропогенного довкілля визначають здоров’я


Основними джерелами забруднення повітря, як вам уже
ди промисловості й транспорту. На центральних вулицях
промислових підприємств часто
ких органічних сполук перевищують

є
фільтрів, перехід на інші види енергії (електрику,
у світі! Ця проблема актуальна й для України навесні та восени,
Продукти харчування, що
чи пестицидами ґрунтах, є причиною хронічного отруєння, зниження імунітету й розвитку різноманітних порушень. Тому використання пестицидів повинно бути раціональним,
і
ґрунтів регулярно контролюватися. Не менший вплив на здоров’я
техногенне середовище. Перенаселеність міст є причиною швидкого
інфекцій, значного рівня хімічного й фізичного забруднення (шум, електромагнітне і світлове забруднення). Незручні умови проживання, пересування й роботи спричиняють стрес, порушення постави, психологічні розлади тощо. Розповсюдження
ров’я,
спеціаліста

невідкладної медичної
їні лікарні розташовані, здебільшого, в адміністративних центрах, що робить систему охорони здоров’я централізованою, але недостатньо розвиненою в сільській місцевості. Водночас усі базові медичні
ними й доступними для населення.
і розвитку епідемії.

Немає даних0%5%10%15%20%25%30%41%
Рис. 32.3. Поширення антивакцинних переконань у світі На мапі зазначено відсоток людей, які вважають вакцини небезпечними, у різних державах. На жаль, Україна знаходиться серед лідерів за розповсюдженням антивакцинаторських поглядів.


зумовлені генами, розташованими в Х-хромосомі. Для осіб жіночої статі
1 (розсіяний склероз, псоріаз, системний червоний вовчак)
хвороби
тканини (запалення судин, порушення будови кісток тощо). Утім для багатьох хвороб (особливо інфекційних) захворюваність ніяк не залежить від статі.
Зрозуміло, що здоров’я залежить і від віку людини:
хронічних хвороб, виникнення

соціальної напруженості (незадоволення
3.
4. Увідповідніть групу чинників
1 стан довкілля
2 медичне обслуговування
3 спадковість
і параметри тіла
4 соціальні умови
5 спосіб життя
5.

А використання застарілого обладнання для рентгенодіагностики
Б накопичення в сільськогосподарських ґрунтах йонів важких металів В відмова від вакцинації Г нерегулярний рух громадського транспорту
Д наявність у генотипі чоловіка алелю гемофілії

потреба розібратися, який спосіб життя дозволить кожному з нас бути здоровим. Такий спосіб, що відповідає
тованим рекомендаціям і спрямований
запобігання хворобам, збереження здоров’я й зміцнення організму, називають здоровим способом
(ЗСЖ) (рис. 33.1). До речі, забезпечення ЗСЖ є ціллю № 3 «Порядку
бол, волейбол, теніс, бадмінтон), активна робота на городі чи вдома. Але тричі на тиждень фізична активність має бути високоінтенсивною або анаеробною. Таке навантаження завжди короткочасне й велике, через що організм не встигає наситити м’язи киснем, і вони працюють у анаеробних умовах. Завдяки цим вправам зростає м’язова сила й витривалість. Це, наприклад, заняття у важкоатлетичному тренажерному
трамваєм чи автобусом, що вирушає із зупинки) тощо.
Дорослі повинні витрачати не менше 150 хвилин щотижня на аеробні
ви середньої інтенсивності або
75 хвилин на вправи високої інтенсивності, чи пропорційно (у співвідношенні 2 : 1) комбінувати їх. При цьому анае-



активні, мають менші ризики розвитку неінфекційних хвороб (наприклад, ішемічної хвороби серця1, атеросклерозу, раку, цукрового діабету), та мають вищу опірність організму до інфекційних хвороб. Зазвичай, вони менш схильні до ожиріння. Завдяки наявності фізичних навантажень стан м’язів і кісток покращується. Як наслідок, людина стає більш витривалою, спритною й гнучкою. Ба більше, рухова активність є ефективною профілактикою порушень опорної системи2, через які з віком стає важче рухатися.


Рухливі люди є більш психічно та соціально благополучними:
ся відчуття щастя (рис. 33.3)
навантажень у центральній нервовій системі утворюються
із їжею, повинна відповідати
випадку людина ризикує мати надмірну масу тіла й ожиріння
фізичною
Рис. 33.4. Харчова піраміда
продуктів здорового щоденного раціону
Найбільше в здоровому раціоні міститься зернових продуктів, овочів і фруктів.
Близько 30 % складають продукти, багаті на білки й ненасичені жири.
Молочні продукти третього
рівня займають п’яту частину
всього раціону. Решта —
це продукти, вживання яких потрібно звести до мінімуму.

свинини) і продуктів із нього (ковбас, консервів). Тому в здоровому раціоні повинно переважати м’ясо птиці, риб, безхребетних (молюсків, членистоногих) і рослинні білки, які також містять незамінні амінокислоти. Але важливо не переїдати білкових продуктів, щоб уникнути
калорійності їжі. Тому тістечка, печиво, морозиво, солодощі, безалкогольні газовані напої повинні стати рідкісними складниками щоденного раціону. Так само рекомендовано
йомом їжі
стати
здорового харчування. Важливо, що разом із волокнистими овочами (капуста, кабачки, перець), зеленню
злаків до організму надходить целюлоза (клітковина). Вона потрібна для нормальної життєдіяльності кишкової мікрофлори та руху їжі травним трактом. Крім того, рослинні волокна створюють відчуття ситості в шлунку,
уникненню переїдання. Ще однією рисою здорового харчування
солі у стравах — її
чайної ложки). Таке обмеження дозволяє
рушень серцево-судинної
умов життя, рівня фізичної активності, кількості рідких страв, що вживає особа. Нормою для дорослої людини з помірним фізичним навантаженням, яка проживає в м’якому кліматі, уважають 1,5–2,5 л рідини щодня. Очевидно, що фізично більш активні люди (спортсмени, вантажники), ті, хто працює у спекотних умовах (поряд із печами, на відкритому повітрі влітку), повинні вживати більше води. Окрім рекомендацій, що їсти, є й поради, як їсти. Найкраще споживати їжу частіше й невеликими порціями, як зголоднієш. Це позбавляє неприємних
чуттів від переїдання, а також підвищує ефективність травлення та
ня поживних речовин. Найоптимальнішим способом приготування їжі є варіння чи обробка парою. За такого спосо-
бу обробки зменшується ризик утворення небезпечних для здоров’я речовин, що виникають під час контакту
компонентів страв із


природних нейтральних жирах, особливо в рослинних оліях, містяться залишки ненасичених жирних кислот, у складі яких наявний один або декілька подвійних зв’язків між ато-
мами Карбону. У більшості жирів за-
лишки ненасичених жирних кислот перебувають у цис-формі. У той же час
карбонові ланцюги відходять із одного боку від подвійного зв’язку, що робить молекулу вигнутою (рис. А). Однак
бактерії рубця жуйних тварин можуть
утворювати й транс-ізомери ненасиче-
них жирних кислот. Тоді карбонові ланцюги відходять із різних боків, а моле-
кула не має вигину (рис. Б). Через це в
деяких продуктах тваринництва (масло, молоко, м’ясо великої рогатої худоби)
наявний високий уміст транс-жирів




(наприклад, маргарин)
у харчовій промисловості для виготовлення солодощів, печива, чіпсів і снеків, у яких їхній уміст сягає 30 г на 100 г продукту! Крім того, вони
ються під час смаження, особливо
ціям ВООЗ?
А вечірня 15-тихвилинна пробіжка парком у будні
Б тренування з шосейного велоспорту
В двогодинна гра в настільний футбол
Г 20-хвилинне вигулювання собаки в парку щоранку
3. Якого з наведених продуктів слід
буряка Б апельсинового соку В квашеної капусти Г ковбаси
4. Уживання свіжих овочів сприяє А зменшенню надходження
надходженню
5.

6.
7.
яють підтриманню здоров’я.
8. Узагальніть у вигляді
ти харчування, що ви купуєте, повинні бути свіжими й не протермінованими, зберігатися в належних умовах, мати непошкоджену упаковку. Інакше гарантувати те, що продукт безпечний для здоров’я, стає складно. Перед початком приготування чи споживання їжі потрібно ретельно вимити руки. Також очищення потребують усі робочі поверхні (стіл, дошка для різання), посуд і кухонне приладдя й самі продукти харчування. Особливо ретельного мити треба ті продукти, що були зібрані чи викопані із землі або не мають упаковки. Варто зауважити одразу, що вода для миття й куховаріння, має відповідати гігієнічним стандартам: бути чистою й продезинфікованою. Джерелом інфекції можуть
домашні тварини. Тому потрібно унеможливлювати їх контакт із їжею, посудом




і стоп, оскільки
найбільш імовірним. Під час миття краще використовувати неантибактеріальне мило, що дозволить нормальній шкірній мікрофлорі швидше відновитися. Частота
в людини жирне волосся, то це можна робити щодня, якщо
на спільнота радить мити й вуха, щоб видаляти вушну сірку
закупорювати слуховий прохід.
Чистити

які

мікрофлори. Його потрібно регулярно прати, й робити
свідчить про те, що бактеріальна й грибкова мікрофлора вже розмножилася між волокнами тканини. Взуття, як і одяг, має відповідати формі й розмірам тіла, бути


частинок і вуглекислого газу. Крім того, щотижня бажано позбуватися пилу й робити вологе прибирання. У місцях масового скупчення людей (школи, офіси, громадський транспорт) вологе прибирання має здійснюватися щодня. Ковдри, покривала, килими варто вибивати чи здавати
хімчистки

рік.
дозволять уникнути поширення й розмноження хвороботворних паразитів.
спілкуванню в родинному колі та з друзями й подругами, прогулянкам на свіжому повітрі, оскільки зміна виду діяльності й активний відпочинок пришвидшують відновлення сил. І як мінімум один день на тиждень має бути вихідним. Оскільки добові біологічні ритми (про них ішлося у § 11) властиві й людині, то в нічний час знижується активність роботи всіх систем організму, а разом із тим і продуктивність праці. Тому, для зменшення виснаження організму й відновлення його високої працездатності, кожна людина має регулярно спати

Рис. 34.4. Інемурі — японська традиція сну в громадських місцях чи на роботі У японському суспільстві поширеним є явище понаднормової роботи, що спричиняє нестачу сну в робітників і робітниць. Намагаючись її компенсувати,
вночі. Для підлітків найоптимальнішим є сон тривалістю 9–10 годин, а для дорослих — 8–9 годин. Бажано, щоб спання не переривалося, бо лише за умов тривалого сну ресурси організму встигають повністю відновитися. При цьому варто пам’ятати, що нестачу сну неможливо
пенсувати
організму,

тварин, розвивається реакція стресу. Стрес1 — це неспецифічна 2 нейрогуморальна реакція організму, що розвивається у відповідь на дію сильного подразника. Такими подразниками можуть бути екстремальні умови довкілля (холод, гучний звук), порушення організму (травма, інфекція), вплив хімічних речовин (алкогольне чи наркотичне сп’яніння), емоційні переживання (страх, радість). Завдяки стресу організм мобілізує ресурси: під дією

Рис. 34.5. Стадії стресу Під дією стрес-фактора (червона стрілка) загальна опірність організму зменшується. Але регуляторні системи швидко компенсують це і, мобілізувавши ресурси організму, поступово підвищують рівень супротиву. Якщо дія стресового чинника не припиняється, то з часом, через виснаження ресурсів, опірність починає спадати, що може навіть спричинити загибель організму.
у крові, зростає м’язова витривалість. Однак, через певний час резерви
му вичерпуються й наступає стадія виснаження, коли рівень опірності починає спадати. Тому стрес є ефективним механізмом пристосування до
«несподіванок», лише якщо
буває надмірною чи спотвореною. У такому випадку
вмирають від інсультів чи інфарктів
ну чи соціальну природу
життя й роботи, рівнем оплати праці, відносинами в колективі
ми, дискримінацією або перевтомлюються. Такий стрес є причиною розвитку хронічних порушень в організмі (гіпертензії, атеросклерозу, появи виразки шлунку), а також спричиняє зниження імунітету. У психоемоційній сфері в людини проявляються порушення сну, дратівливість, депресія, хронічна втома, з’являються неврози, болі, що мігрують, можливі істеричні напади. Для уникнення цих наслідків потрібно якнайшвидше
суміші в киплячій воді
2. Скільки часу на добу рекомендовано відпочивати дорослій людині? А 5 –10 хвилин Б 8-9 годин В 9-10 годин Г 16 годин 3. Для попередження плоскостопості потрібно А ходити босим Б тренувати м’язи пресу В їсти м’ясо Г ходити у взутті без підборів
4. Міняти постільну білизну рекомендовано
А щодня Б щотижня В тричі на місяць
5. Розгляньте графік на рисунку 34.5 і визначте, коли опірність організму найшвидше зростає. А на стадії тривоги Б на стадії опору В на стадії виснаження Г до дії стресового
6. Увідповідніть дію, пов’язану із підтриманням чистоти тіла, і рекомендовану частоту її виконання.
1 чищення зубів
2 миття тіла
3 зміна зубної щітки
4 миття сухого волосся

раз на тиждень
раз на день Д двічі на день
7.
8.
9.
Алкоголь у будь-яких кількостях негативно впливає
на організм
Напевне, найвідомішою рисою ЗСЖ є відмова від уживання алкоголю та
наркотиків, а також від куріння. Надзвичайно поширеною у світі згубною
звичкою є споживання алкогольних
напоїв, що містять етанол (етиловий
спирт) (рис. 35.1). Згідно зі статисти-
кою ВООЗ щороку кожна двадцята
людина на планеті, а це понад 300 млн
людей, гине через негативний вплив
алкоголю на організм. В Україні що-
дня від наслідків уживання алкого-
лю помирає кілька десятків людей, а за рік — майже 40 тис. осіб. За даними
досліджень, близько 40 % українських
підлітків регулярно його вживають.

Понад 200 порушень як фізичного (зокрема раку, хвороби серцево-судинної системи, порушення роботи печінки), так і психічного й соціального благополуччя пов’язані з алкоголем. Уживання етанолу часто є причиною побутового травматизму, бійок, дорожньо-транспортних пригод, самогубств. Також доведено: вживання алкогольних напоїв є чинником, що сприяє поширенню деяких інфекційних хвороб, наприклад, туберкульозу чи ВІЛ/СНІД. Надважливим є розуміння, що

Через активацію утворення нейромедітору1 дофаміну й ендорфінів п’яна людина починає відчувати
Оскільки органом, що детоксикує етанол, є печінка, то й страждає вона навіть від однократного вживання алкогольних напоїв. За тривалого ж прискорюється загибель клітин печінки й виникає цироз, коли місця мертвих клітин заповнює волокниста сполучна тканина (рис. 35.2). Через це погіршується функціонування печінки, що позначається й на процесах травлення.


Через порушення складу крові в людей, які вживають алкоголь, стінки судин кровоносної системи стають менш еластичними, тому ризик атеросклерозу, аритмії, інсультів зростає. Крім того, змінюється структура серцевого м’язу, що провокує серцеву недостатність та інфаркт. Спирт здатний проникати в статеві органи і впливати на їхні
відмовитись
Тютюнокуріння завдає удару по фізичному, психологічному
й соціальному благополуччю Тютюнопаління є не менш розповсюдженою шкідливою звичкою. Близько 7 млн людей (майже 20 % із них жінки) щороку вмирає від причин, пов’язаних із курінням тютюну. При цьому трохи менше 1 млн — це люди, що не палять, а лише дихають тютюновим димом (пасивні курці),
із тим, хто палить. Пасивними курцями є 40 % усіх дітей світу! Понад 6 млн українців курять щодня (і 30 % підлітків) й 120 тис. гине від причин, пов’я-
Достовірно відомо, що паління значно підвищує ймовірність розвитку раку: у понад 20 разів зростає частота
появи раку легень і у 2–10 разів розвиток раку інших органів дихальної, травної, видільної, статевої систем. Дихальна
система є тим місцем, що уражається
сигаретним димом насамперед. Через

накопичення смол, вплив отруйних речовин у людей, які палять, виникає постійне запалення бронхів (хронічний бронхіт) і руйнування структури комірок легень — альвеол, що має назву емфізема (рис. 35.3). Через ці порушення дихальні можливості легень знижуються, у людини з’являються задишка



втрата зубів серед людей, що палять, відбувається у 2-3 рази швидше, ніж у тих, хто не палить. Через зниження імунітету курці й курчині, частіше страждають від інфекційних хвороб, особливо тих, що передаються повітряно-крапельним шляхом і уражають дихальну систему. У тих, хто палить, частіше випадає волосся на голові, розвивається псоріаз, швидше старіє шкіра, жовтішають зуби й нігті (рис. 35.4). Люди, що курять,
Паління тютюнових виробів негативно впливає й на репродуктивне здоров’я1. Жінки, що палять, порівняно з тими, які цього не роблять, мають більшу ймовірність безпліддя та проблем із вагітністю. Вдихання тютюнового диму під час вагітності значно підвищує ризик передчасних пологів, мертвонародження, розвитку фізичних і розумових вад у дитини. У чоловіків куріння підвищує на 85 % імовірність імпотенції та погіршує якість сперми, що може бути причиною розвитку порушень у плоду.
Виживання, % людей відносно 25-тирічних

Вік, роки
Рис. 35.5. Зростання смертності людей від куріння Люди, які не курять (зелена лінія), мають нижчу смертність, ніж ті, що курять (червона крива). Відмова від паління у віці 45 років (синя лінія), порівняно із відмовою у 65 років (оранжева лінія) продовжує життя на більшу кількість років.
Відмова від тютюнопаління в будьякому віці має лише позитивні наслідки для організму. Але його повне відновлення потребує часу, подекуди понад 10 років. Крім того, припинення тютюнопаління збільшує
чи зниження чутливості до них — виникає звикання. І, щоб гарно
наркоману чи наркоманці
збільшені, дози наркотику. У людини з’являється залежність, спочатку психічна, а згодом і фізична. Тепер без наркотиків організм функціонує неправильно. Тому в процесі відмови від наркотичної речовини, як і у випадках із алкоголем і тютюнокурінням, виникає синдром відміни («ломка»), що проявляється в
частих інфекцій у людей, що вживають наркотики. Особливо яскраво це
людей світу, які вводять наркотики шприцом у вену, заражені цим вірусом. Наркотичні речовини здатні проникати крізь плаценту в кров плоду й спричиняти порушення його розвитку, викидні та передчасні пологи. Понад те, діти, народжені матерями, що вживають наркотичні речовини, більш схильні до асоціальної поведінки, уживання алкоголю й наркотиків. Часто наркотичні препарати не є чистими речовинами, а забруднені численними домішками. Уведення таких препаратів, особливо в кров, може спричинити загальне отруєння організму, порушення роботи
системи, печінки й нирок, смерть (рис. 35.6).
до
тіла порушується, і це може спричинити
Споживачі наркотиків
ні, мають ослаблену волю, їхні інтелектуальні



Мозок людини — це унікальна структура між вухами, що безпосередньо керує нашою поведінкою. Для того, щоб виникало бажання ще раз відчути дію позитивних для організму чинників (наприклад, смачної їжі), а також формувалося відчуття задоволення від них, у головному мозку є спеціальна система винагород. Її основою є
нервові центри середнього мозку й підкоркові центри переднього мозку, передача збудження між нейронами яких відбувається за
допомогою нейромедіаторів дофаміну й серотоніну. Саме їх вивільнення в синапсах між нервовими клітинами системи винагород й
викликає відчуття задоволення від перемоги на змаганнях, аплодисментів після виступу чи вишуканого десерту. Психоактивні речовини

му)
Задля того,
нейронах
2. На графіку, що наведений на рисунку 35.5, смертність людей (кількість, що помирає за одиницю часу), які палять, А є меншою, за смертність тих, хто не палить Б спадає із віком В залежить від відсотку людей, що не палять Г зростає із віком
3. У чоловіків, що курять тютюн, найбільше зростає імовірність
А випадіння зубів Б імпотенції В психозу Г раку легень
4. Передозування наркотиками небезпечне
А вимкненням мозкової системи винагород
Б надмірним навантаженням на організм
В розвитком синдрому відмови
Г розвитком ВІЛ-інфекції
5. Увідповідніть негативний вплив алкоголю й орган, на який він здійснюється.
1 порушення слизової оболонки
2 атеросклероз
3 погіршення координації рухів
4 зміна структури міокарду

А дрібні артерії
Б серце
В печінка
Г кишківник
Д мозочок
житті все просто
6. Скориставшись даними, наведеними на рисунку 35.1, і
з
фії визначте, у яких країнах Європи найбільший рівень уживання алкоголю, а в яких — найменший. Спробуйте пояснити таку різницю на основі відмінностей у культурі, релігії, побуті.
7. Поясніть, як зміни в складі крові в людей, що курять, збільшують ризик інфарктів та інсультів.
8. Що спільного у впливі алкоголю, тютюну й наркотичних речовин
здоров’я, а разом із ним і ЗСЖ, є дотримання правил
дозволяють уникати зараження інфекціями, що передаються переважно статевим шляхом (ІППСШ)1. ІППСШ
понад 30 інфекційних хвороб, зараження якими відбувається найчастіше під час статевого контакту. Збудником ІППСШ можуть бути віруси, бактерії, одно- і багатоклітинні еукаріотичні паразити (табл. 36.1). Одразу варто зауважити, що деякі з цих інфекцій можуть поширюватися й іншими шляхами. Наприклад, вірус імунодефіциту людини (що спричиняє СНІД) і вірус
контакті
інфікованої людини, зараження вошами й кліщами (збудниками педикульозу й корости відповідно), сифілісом, папіломою
бутовим шляхом

що
Природа збудника
Вірус
Бактерія
Одноклітинний еукаріот Багатоклітинний еукаріот Хвороби
СНІД, папілома, генітальний герпес, гепатити
Сифіліс, хламідіоз, гонорея, мікоплазмоз Трихомоніаз, кандидоз (молочниця)
Лобковий педикульоз (фтіріаз), короста
сечовипусканням



жави щороку!), не враховуючи ще 244 тис. випадків ВІЛ-інфікування. Розповсюдженим явищем у світі є дискримінація людей, які мають хвороби, що передаються статевим шляхом: їх уважають розпусними, такими, що працюють у індустрії сексуальних послуг, наркоманами й наркоманками. Негативний вплив дискримінації проявляється в їхньому небажанні звертатися за медичною допомогою чи здавати аналізи. А не дізнавшись свій
продовжувати



дитини, а також перевірити наявність щеплення від краснухи. Якщо в родинах батьків виявлялися спадкові хвороби, то їм варто відвідати медико-генетичну консультацію. Не менш важливими є психологічна й соціальна упевненість у бажанні мати дитину. А це означає, що батьки мусять усвідомлювати, які зміни відбудуться
сті й після народження дитини,

що відбуваються щорічно, завершуються смертю дитини. Задля того,
уникнути небажаної
методами контрацепції (табл. 36.2). Найбільш ефективними
гічні. Вони

(поведінкові)
Бар’єрні
Гормональні

Хімічні
Хірургічні
Не потребують додаткових засобів
Перешкоджають контакту гамет шляхом утворення фізичного бар’єру між ними
Блокують дозрівання яйцеклітини; змінюють стан слизу в матці, що блокує рух сперматозоїдів та імплантацію ембріона Знищують сперматозоїди й перешкоджають їхньому рухові
Шляхом перерізання статевих протоків запобігають виходу гамет із статевих залоз

Приклади методів
Календарний, перерваний статевий акт Презервативи, матковий ковпачок, діафрагма Оральні контрацептиви, гормональні ін’єкції й імпланти Креми, свічки, спреї, що містять сперміциди2
Вазектомія3
й стерилізація жінок



батьківства У Австралії, Канаді та США для попередження підліткової вагітності впроваджувалася програма віртуального батьківства, у якій підлітків навчали азам догляду за новонародженим за допомогою реалістичних ляльок-симуляторів. Однак виявилось, що це спричиняє збільшення кількості вагітностей серед підлітків, що брали участь у цій програмі, хоча й знижує рівень абортів.

ловині всіх випадків.
небезпечним способом, що може спричинити порушення
релігій). Від поведінки батьків під час вагітності
сутності медичного спеціаліста/спеціалістки в лікарняних умовах.
Найкращим способом харчування новонародженого є грудне вигодовування. Річ у тім, що грудне молоко містить не
необхідні для немовля поживні речовини, вітаміни й мінерали, але й антитіла, що забезпечують




із ІППСШ живе в Південній Америці Б найімовірніше зараження
ІППСШ у країнах Африки
В у США немає людей із ІППСШ
Г на континентах Південної
півкулі ІППСШ більш поширені,
ніж на континентах Північної
2. Після якої з наведених ситуацій варто здати аналіз на ВІЛ?

А користування чужим рушником
Б статевий акт із використанням презерватива
В позитивний результат тесту на вагітність
Г здавання крові з вени в поліклініці
3. Зазначте рису, якою наділені немовлята завдяки грудному вигодовуванню.
А стійкість до інфекцій Б пришвидшення травлення В зменшення маси тіла Г
тривалості сну
4. Вагітній жінці рекомендують зменшити
Г хімічні Д хірургічні

профілактику
від захворювань, що не передаються від людини до людини, — неінфекційних хвороб. Їхня поява визначається схарактеризованими раніше чинниками (табл. 37.1) нездоровим способом життя, шкідливими звичками, несприятливими соціальним і природним оточенням, спадковістю. Тому їхня профілактика й полягає у виконанні попередньо зазначених рекомендацій. Так можна знизити ризик появи захворювань серцево-судинної системи (ішемічної хвороби серця, інсультів), забезпечивши нормальний рівень фізичної активності, уникнути хвороб обміну речовин (цукрового діабету ІІ типу) — скоригувавши харчовий раціон, зменшити ймовірність розвитку раку легень
стресу. Варто розуміти, що лише одна дія, наприклад,
треба намагатися дотримуватися
здорової
лише проконсультуватися в якісного спеціаліста чи спеціалістки. Останнє особливо актуальне для людей, що з генетичних причин схильні до тих чи тих порушень.
Їм потрібно заздалегідь дізнатися про таку схильність (часто це можна зробити за родоводом) і враховувати ці знання в повсякденному житті.
Інфекційні й інвазивні хвороби
передаються різними механізмами


та шляхами Інфекційні2 хвороби спричинені проникненням до організму збудників (інфекційних агентів) — вірусів, пріонів, бактерій, одноклітинних еукаріотів, грибів. Якщо ж збудник є твариною-паразитом
інфекційні й інвазивні хвороби передаються
ження інфекційний агент має . залишити організм хворої людини;
. перенестися через навколишнє середовище; . проникнути до організму іншої людини.
Вихід збудника з організму хворої людини можливий завдяки фізіологічним виділенням (випорожнення, сечовиділення, чхання й кашель, кровотеча), завдяки укусам кровосисних комах, штучним шляхом під час медичних (уколи, переливання крові) чи косметологічних процедур (пірсинг, татуаж). Надалі інфекційні агенти за участю
ся
іншої людини. У перенесенні можуть брати участь повітря,
1
2
Таблиця
Механізм
Повітряний

Фекальнооральний
Трансмісивний
Контактний
Гемоконтактний
Вертикальний
Суть
Збудник переноситься зі слизової дихальних шляхів через повітря
Збудник вивільняється зі шлунково-кишкового тракту з калом чи блювотою та потрап-
ляє до рота іншої
людини
Збудник переноситься
кровосисними тваринами
Збудник виділяється
на шкіру чи слизові
оболонки й переноситься під час контакту
Збудник передається
через контакт
із кров’ю
Від матері до дитини
Шляхи
Повітряно-крапельний (із краплями слини)
Повітряно-пиловий (із частинками пилу)
Водний
Через продукти
харчування
Через предмети
побуту й ґрунт
За участю тварин-
переносників
Контактно-раньовий
Статевий
Через предмети побуту й ґрунт
Природний
(під час поранення)
Штучний
(під час медичних
чи косметичних
маніпуляцій)
Під час вагітності
Під час пологів
Приклади захворювань
ГРВІ, бронхіт, пневмонія, гепатит А
Гельмінтози (глистні інвазії), дизентерія, сальмонельоз, холера
Малярія (комарі), поворотний тиф (воші), хвороба Лайма (кліщі)
ІППСШ, правець, сифіліс, сибірська виразка
ВІЛ/СНІД, гепатит В і С
ВІЛ/СНІД, краснуха, герпес

Через осушування боліт із

зменшення
комарів, збільшення агро- і нафтопромислових площ, а також виселення корінних мешканців із 1992 року (А) по 2002 рік (Б) площа боліт зменшилась на 90 %, що спричинило опустелювання, вимирання видів і зміну клімату в регіоні.
контактів інфікованої людини з іншими людьми
ми хворобами повинні або самоізолюватися
не виходити з помешкання), або бути ізольованими
спеціальних інфекційних відділах чи лікарнях. Якщо такий карантин неможливий, то варто принаймні обмежити поширення власних виділень,
й ретельно миючи

й температурну обробку
тися з тваринами-переносниками інфекцій за рахунок осушування боліт, використання ін-
сектицидів (але робити це раціонально, лише якщо вигода перевищує несприятливу
довкілля, рис. 37.2), покращувати соціально-побутові умови малозабезпечених верств населення тощо. Не менш важливим елементом профі-



повністю викорінити
дів доз вакцини. Подібні
приносять користь. Так, щорічно у світі фіксується лише близько сотні випадків поліомієліту, порівняно з понад 350 тис. випадків 30 років тому. Кору й краснухи вже позбулися близько 80 країн світу, й усі випадки цих хвороб у них «завезені» (рис. 37.4). Охоплення комплексною
ному параграфі). Тому введення деяких
потрібно здійснювати щорічно восени, і вакцина має бути від того штаму інфекційного агента, епідемія якого очікується. Та й вакцинація подекуди не забезпечує захисту на все життя, та через певні проміжки часу деякі вакцини треба вводити повторно (наприклад, від дифтерії чи правця щодесять років). Ба більше, нові штами вірусів можуть
у організмах людей і тварин. Такі збудники, наприклад,
що виник в організмі

тяжкого
походження.
жають і сільськогосподарських тварин, спричиняючи їхню загибель. Тож люди, намагаючись уберегтися від
від людини до людини і спричинити епідемію. Для уникнення цього ВООЗ і міжнародні тваринницькі організації запровадили систему
швидкого сповіщення та розробили плани карантинних дій у разі початку епідемій. Отже, лише всезагальний контроль за джерелами інфекцій

В ретельно контролювати масу свого тіла
Г відвідувати лікаря щомісяця
2. Заповніть пропуски у твердженні
щодо зображеного на світлині об’єкта. Його можна використовувати для (1)
потрапляння збудника (2) у довкілля.
А 1 – обмеження, 2 – правця
Б 1 – покращення, 2 – малярії
В 1 – забезпечення, 2 – СНІД
Г 1 – блокування, 2 – бронхіту

3. Серед наведених хвороб виберіть ту, викорінення якої, імовірно, станеться найшвидше.
А кір Б поліомієліт В малярія Г гепатит В
4. Який із цих факторів сприяє швидкому поширенню інфекції
до людини?
А глобальне потепління Б урбанізація
В зменшення озонового шару Г зменшення біорізноманіття
5. Увідповідніть інфекцію та шлях її передачі.
1 грип
2 ВІЛ/СНІД
3 малярія
4 дизентерія

А комахами-переносниками Б при використанні спільного шприца
В із неочищеною водою Г повітряно-крапельний
6.
7.
8.
1.

Назва
2. Запропонуйте
Відпочинок
фоцити, фагоцити й інші допоміжні клітини (рис. 38.1, А). Вони утворюються в червоному кістковому мозку, а дозрівають і розмножуються в решті органів лімфатичної системи1: тимусі (загрудинній залозі), лімфатичних вузлах
кулах (їх багато в мигдаликах і апендиксі), селезінці (рис. 38.1, Б).
Компоненти вродженого імунітету забезпечують неспеціалізований захист Захист організму має три «лінії оборони»: захисні покриви2 , вроджений (неспецифічний) імунітет і набутий (специфічний)
імунітет. Захисна функція покривів реа-
лізується завдяки наявності механічного бар’єру між організмом і навколишнім середовищем. У людини таким бар’єром
є шкіра, а також слиз, сльози й сеча, що
захоплюють мікроорганізми та часточки
пилу на поверхні травної, дихальної, се-
чостатевої системи і виводять їх із орга-
нізму. Понад те, хімічні речовини також
беруть участь у захисті на рівні покри-
вів: так, до складу сліз і слини входить
фермент лізоцим, що здатний руйнувати клітинну стінку бактерій, а в шлунку міститься соляна кислота й протеази, які ефективно знищують мікробів, що потрапили всередину.
1 Іноді лімфатичну й імунну системи вважають однією й тією ж, оскільки органи

Моноцит
А

Лімфоцит
Лімфатичний капіляр
Тимус
Селезінка
Лімфатичний вузол
Б

Таблиця 38.1. Компоненти вродженого імунітету
Компонент
Система
комплементу
Медіатори
запалення
Фагоцити
Природні
кіллери

Природа
Гуморальна
Клітинна
Клітинна
Функція
Зв’язування з поверхнею інфікованої чи переродженої клітини та руйнування її мембрани, приваблення імунних клітин
Приваблення імунних клітин до місця
пошкодження, прискорення загоювання
Поглинання й перетравлення чужорідних агентів Виділення речовин, що вбивають ракові
Найбільш досконалим, характерним винятково для хребетних тварин є набутий імунітет. У його
лежить розпізнавання Т- і B-лімфоцитами1 компонентів чужорідних агентів — антигенів. Антигени — це речовини, які організм уважає нехарактерними для себе і які зв’язуються з антитілами чи рецепторами лімфоцитів. Таке зв’язування відповідає принципу «ключа й замка», згідно з яким тривимірна структура антигена має відповідати за просторовою формою антиген-зв’язувальній ділянці антитіла (білкаімуноглобуліна) чи рецептора (рис. 38.2). Саме ж зв’язування відбувається завдяки електростатичним, водневим й іншим міжмолекулярним зв’язкам. Завдяки тому, що окремі Т- і В-лімфоцити реагують лише на певний антиген, набутий























































імунітету
1. Інфікування клітини тіла.
2. Активація Т-кіллера.
3. Знищення інфікованої клітини.
















































































































































































































































































































4. Фагоцитоз збудника макрофагом.
5. Активація Т-хелпера.
6. Активація Т-хелпером Т-кіллера.
7. Активація B-лімфоциту Т-хелпером.
8. Активація B-лімфоциту антигеном.


















































9. Розмноження В-лімфоциту й перетворення на плазматичну клітину.
10. Утворення плазматичною клітиною антитіл.
будуть зв’язуватися з клітинами, що презентують антиген, і знищуватимуть їх, «пробивши» отвори в
Надалі
впливом Т-хелперів В-лімфоцити розмножуються
тини, які виділяють численні антитіла, що зв’язують антиген, блокують його дію й спричиняють знищення (наприклад, фагоцитами). Для обох видів набутого імунітету характерним є явище імунної пам’яті. Спеціальні клітини пам’яті, які коли-небудь контактували з певним антигеном,
Автоімунні хвороби
Імунодефіцити
Алергії
Онкологічні порушення

Суть порушень
Імунна система атакує речовини й клітини власного
Пошкодження однієї з ланок
імунітету, що спричиняє
послаблення захисту
Гіперчутливість імунної системи до безпечних речовин довкілля
Неконтрольоване розмноження імунних клітин
Приклади
Цукровий діабет І типу, розсіяний склероз, псоріаз
СНІД, важкий комбінований імунодефіцит
Алергія на пилок рослин, сіно, укуси комах
Лейкемія, лімфома
системи (наприклад,
сироватки з антитілами проти певного збудника). Якщо якась
нокорекція. Стимулювальну
формі й різними шляхами
(ехінацеї, женьшеню), синтетичні хімічні
активування імунних реакцій і покращення імунітету.
При алергіях та автоімунних порушеннях, навпаки, використовують пригнічувальну імунокорекцію, що послаблює імунні реакції. Її здійснюють за допомогою препаратів-імуносупресорів. Найчастіше — це кортикостероїдні гормони чи їх аналоги. Як імуносупресор може використовуватися й ультрафіолетове світло. Наприклад, так лікують шкірні автоімунні хвороби, як-от псоріаз (рис. 38.4): уражені


його фототерапія
А. Хвороба починається з появи на шкірі червоних плям, найчастіше
на ліктях, колінах і сідницях. Б. Терапія за допомогою ультрафіолетового

пересаджений
хвороб. Для цього часто використовують препарати, що стимулюють роботу імунної системи. Наприклад, для посилення противірусного імунітету використовують інтерферони чи речовини, що стимулюють їх вироблення. Крім того, пасивні способи імунотерапії, як-от сироватку з готовими антитілами (антисироватку), застосовують під час отруєнь (зокрема, ботуліністичним
після укусу змій) чи інфекцій. Окремою розвиненою галуззю
1.

3. Імунотерапія раку, проілюстрована на рисунку 38.5, є прикладом використання
А гуморальної ланки вродженого імунітету
Б штучно отриманих імунних клітин
В гуморальної ланки набутого імунітету
Г імунокорекції для лікування хвороб
4. Імунна відповідь під час повторного контакту з антигеном, порівняно
під час першого контакту, через
6.
7.
8.
плантату й імунокорекцією?







кажучи, вони почали займатися сільським господарством.
отримав назву неолітична революція. Подібні
туди навички вирощування культурних рослин і розведення

укова спільнота не є одностайною.
тичні зміни. Річ у тім, що близько 11-12 тис. р. до н. е. завершився
Таблиця 39.1. Центри різноманіття
Центр походження рослин
Центральноамериканський
Південноамериканський
Середземноморський
Передньоазійський
Ефіопський
Середньоазійський
Індійський
Китайський

Розташування
Мексика, Нікарагуа, Гондурас, Гватемала
Колумбія, Еквадор, Перу, Болівія
Албанія, Хорватія, Греція, Італія, Іспанія, Туніс, Єгипет
Іран, Ірак, Туреччина, Сирія, Ліван, Ізраїль, Йорданія
Ефіопія, Судан, Еритрея
Індія, Пакистан, Афганістан, Таджикистан, Узбекистан
Індія, М’янма, Філіппіни, В’єтнам, Лаос, Камбоджа Східна частина Китаю
з них.
Рис. 39.2. Центри різноманіття й походження культурних рослин
1. Центральноамериканський.
2. Південноамериканський.
3. Середземноморський.
4. Передньоазійський.
5. Ефіопський.
6. Середньоазійський.
7. Індійський.
8. Китайський.
культурних рослин
Приклади рослин
Кукурудза, квасоля, гарбуз, какао, соняшник
Картопля, томат
Овес, капуста, буряк, кріп, морква, олива
Пшениця, жито, горох, виноград
Кава, кавун
Диня, ріпчаста цибуля, часник
Рис, огірок, баклажан, цукрова тростина
Соя, яблуня, вишня, апельсин, мандарин, шовковиця, хурма

занадто агресивний, а лань занадто ляклива, щоб співіснувати з людиною. Для того, щоб тварина могла бути одомашнена, вона повинна мати цілий ряд характеристик. Навіть якщо одна з них відсутня, одомашнювання неможливе. Це правило
називають принципом Анни Кареніної1. Виходячи з цього принципу, сформульованого Джаредом Даймондом, усі одомашнені тварини схо-
жі між собою, а кожна неодомашнена не може бути одомашнена через свої причини.
Розглянемо більш детально ці ознаки, які є в одомашнених тварин:
. невибагливість у харчуванні;
. швидкий ріст;
. здатність розмножуватись у неволі;
. товариське ставлення до людини;
. відсутність схильності до паніки.
Як і у випадку з рослинами, одомашнення
тварин було прив’язане до певних географічних регіонів. Вівця, корова, кінь, одногорбий верблюд і коза були одомашнені в Передній Азії, собака й курка — у Південно-Східній Азії, кіш-
ка, осел і цесарка були одомашнені в Північній Африці, індик — у Центральній Америці, лама й альпака — у Південній Америці (рис. 39.3). Найпоширенішими методами селекції є штучний добір і гібридизація Після





необхідні
добір, посилюють прояв властивості, що була потрібна. Під час гібридизації
може посилитись,






Рис. 39.5. Різноманіття порід голубів Більш поширеною метою селекції є виведення нових сортів, порід і штамів на основі тих, що вже існують. При цьому намагаються посилити
для людини властивості: швидкість росту, невибагливість до умов проживання, стійкість до хвороб, покращити виживання, зробити смачнішими чи
нішими як продукти харчування,

одну з найбагатших у тогочасній Європі колекцію фруктових, овочевих і ягідних рослин (рис. 39.6) та ввів
у вжиток популярний сорт яблук Ренет Симиренка. Василь Юр’єв більшу частину свого життя провів у Харкові,

із них

в природі й без участі людини
Г джерелом різноманіття для добору є спадкова мінливість 3. Гібридизацію в селекції використовують для
А зменшення рівня прояву потрібної людині властивості
Б появи організмів із корисними ознаками, характерними для обох батьків
В отримання клонів із властивостями, що має батьківський штам
Г виокремлення серед усього різноманіття особин із найкраще вираженими ознаками 4. Серед наведених тверджень
виділяють із початкової популяції групу особин із бажаними ознаками й використовують їх для отримання потомства. Найчастіше такий добір застосовують до перехреснозапильних рослин. Проблема масового добору в тому, що організми, відібрані для розмноження, можуть мати різні генетичні причини прояву вигідної ознаки. Тому, унаслідок схрещування їх між собою, прояв ознаки може послаблюватися (розмиватися), а не посилюватися. Проте численні повтори актів масового добору все-таки призведуть до бажаного результату. Індивідуальний добір ґрунтується на
ознаками з метою отримання потомства
тільки

належать організми, що схрещуються, до одного виду, розрізняють внутрішньовидову й міжвидову гібридизацію. Під час внутрішньовидової гібридизації схрещують організми одного виду. Вирізняють два підвиди внутрішньовидової гібридизації: споріднену (інбридинг) і неспоріднену.

Р: AAbb aaBB
середня середня F1: AaBb
висока F2: 9 A_B_ + 3 A_bb + 3 aaB_ + 1 aabb
висока середня середня низька
Рис. 40.1. Гетерозис А. Гібридні сорти кукурудзи, качани яких розташовані посередині, унаслідок гетерозису мають більший розмір. По боках показані батьківські форми. Б. Схема, що пояснює виникнення й зникнення гетерозису за ознакою врожайності.

врожайністю ААbb і ааВВ, то в першому поколінні отримують
до гетерозиготного стану й втрачають
Але наступні схрещування між
представниками гетерозисного сорту чи породи є спорідненим схрещуванням і спричиняють поступову втрату
переваги, оскільки серед нащадків зростає кількість гомозигот. Тому





40.4, А). Проте він знаходить практичне застосування — завдяки




Рис. 40.4. Міжвидові гібриди тварин
А. Мул. Б. Бістер. В. Зеброїд.
Г. Леопон.

м’ясо (рис. 40.4, Б). Крім нього, є багато дивовижних гібридів, отриманих здебільшого шляхом штучного запліднення, такі як зеброїд (гібрид самця зебри і кобили), косаткодельфін, леопон (гібрид леопарда й левиці) та інші (рис. 40.4, В, Г).
Поліплоїдія дозволяє збільшувати розмір рослин і долати безпліддя міжвидових гібридів Характерною особливістю рослин, що розкриває широкі можливості для роботи селекціонера чи селекціонерки, є їхня схильність до поліплоїдії — кратного збільшення кількості гаплоїдних хромосомних наборів (n). Така геномна мутація спричиняє виникнення організмів із три- (3n), тетра- (4n), пента- (5n), гексаплоїдними (6n) наборами хромосом (і навіть більше). Зазвичай такі поліплоїдні рослини більші за диплоїдні за розміром (рис. 40.5, А). Зростання кількості хромосомних наборів можна легко досягти хімічною обробкою рослини, що

з’являтимуться триплоїдні кавуни без насіння (рис. 40.5, Б). Подібна безнасінність у триплоїдних бананів



їдна м’яка пшениця чи тритікале,
закону
спрогнозувати властивості майбутніх сортів і порід
Обмежене використання в селекції рослин має також
метод штучного мутагенезу. Під час нього насіння
або пилок рослин опромінюють чи обробляють хімічними речовинами, унаслідок чого виникають мутації
в ДНК. Рослини, що утворюються завдяки такому
насінню чи пилку, інколи мають нові ознаки, що можуть стати в нагоді для селекції. Із упровадженням генної інженерії (детальніше про неї йтиметься в § 42) цей метод стали застосовувати дедалі рідше. У передбаченні особливостей мутантів, яких варто очікувати від мутагенезу, корисним є закон гомологічних рядів спадкової мінливості, сформульований Миколою Вавиловим1. Його суть
що в споріднених видів і родів спостерігаються подібні ряди спадкової мінливості (набори варіантів, розташованих в певному порядку) (рис. 40.6). Із цього випливає, що якщо вивчити ряди мінливості близьких видів, то можна спрогнозувати можливість існування подібних форм у виду, що підлягає селекції. Закон має логічне еволюційно-генетичне підґрунтя: що більш спорідненими є види, то пізніше в еволюційній історії відбулося їх відокремлення від спільного предка (дивергенція) і більш подібними
К
ласичні методи селекції, що використовуються тисячоліттями, дозволяють отримати потрібні людині сорти й породи. Однак подекуди їх результати є небезпечними для людей чи власне живих істот. У 1967 році на ринок було випущено сорт картоплі «Lenape», який вирізнявся високим умістом крох-
малю в бульбах і стійкістю до хвороб.
Але вже за 3 роки виявилося, що карто-
плини є отруйними через підвищений
у чотири рази вміст глікоалкалоїдів у них, і сорт було вилучено з ужитку.
Яскравим прикладом негативних
наслідків селекції тварин, є поява схильності до хвороб і порушень у багатьох порід собак. У гонитві за великою силою укусу бійцівських собак чи «людяністю
обличчя» було виведено породи із вкороченою мордою: бульдогів, боксерів, мопсів, пекінесів (рис. А). Через зменшення
довжини верхньої щелепи в цих тварин
будову



Рис. Б. Бики блакитної
2. Бройлерні кури швидко ростуть, оскільки є
А результатом тривалого масового природного добору
Б спеціальною породою курей
В нащадками від схрещування різних видів птахів
Г гібридами різних порід курей
3. Гетерозис можна побачити під час схрещування
А близькоспоріднених організмів
Б організмів однієї чистої лінії
В неспоріднених організмів одного виду
Г організмів різних видів
4. Схожість варіантів мінливості будови колоса в пшениці та

5. У селекції тварин НЕ використовують А штучний добір Б наслідки закону гомологічних
6.
бактерії, одноклітинні
а також мікроскопічні гриби й водорості. Отримання кисломолочних продуктів, пива, вина, сиру, квашених овочів неможливе без роботи мікроорганізмів-бродильників (табл. 41.1). Найімовірніше, першим продуктом, отриманим із використанням мікроорганізмів, є пиво. Найдавніші пивні дріжджі було знайдено ще в єгипетських гробницях. Спочатку дикі дріжджі випадково потрапляли
дило до початку бродіння. Потім
почали додавати до нового сусла

попередньої, що
містила дріжджі1. Отже, людина, сама того не усвідомлюючи, почала культивувати дріжджі. Пізніше виявилося, що закваски
із деяких виходить пиво кращої якості, ніж з інших. Так почався процес
Таблиця 41.1. Продукти харчування, для
яких використовують мікроорганізми
Продукт
Хліб
Пиво
Вино
Текіла
Оцет
Кефір
Сир
Тип бродіння
Спиртове бродіння (необхідне для утворення
бульбашок вуглекислого газу, які
забезпечують пухку структуру хліба)
Спиртове бродіння
Спиртове бродіння
Спиртове бродіння
Оцтовокисле бродіння
Молочнокисле бродіння
Молочнокисле бродіння
Мікроорганізми Дріжджі
Дріжджі
Дріжджі
Дріжджі, бактерії
Бактерії
Бактерії
Бактерії, гриби
біологічно активних речовин.
Селекція мікроорганізмів суттєво
макроорганізмів Селекція мікроорганізмів
від селекції тварин і рослин. По-перше, селекціонер/селекціонерка має
практично необмеженої кількості індивідів — 1 мл поживного середовища
тин мікроорганізмів. Окрім того, швидкість росту культури є
сокою, оскільки проміжок між клітинними
хвилин (прокаріоти) або годинами (еукаріоти). Тому зміна поколінь відбувається надзвичайно швидко й отримання нового штаму займає лічені дні. Через різноманіття штамів у природі
можливості штучного добору для мікроорганізмів є дуже великими. З другого
боку, щоб знайти, наприклад, найпродуктивніший штам, знадобиться багато часу
на перевірку всіх доступних штамів.
Водночас гібридизацію практично
не використовують для отримання нових штамів мікроорганізмів. Річ у тім, що в їх більшості (у прокаріотів, багатьох одноклітинних еукаріотів) відсутнє статеве розмноження. Але навіть для тих мікроорганізмів, у яких статеве розмноження наявне (наприклад, у пекарських дріжджів), його досить важко контролювати. Однак, перенести спадкову інформацію від одного мікроорганізму до іншого можливо. Для цього існує ряд методів, наприклад, під час кон’югації чи за допомогою бактеріофага 1 (рис. 41.1). Завдяки цим
чи виду можуть передаватися іншому.
Цитоплазматичний місток

Бактеріофаг Б
Корисний ген
Клітинареципієнт
Рис. 41.1. Методи перенесення спадкової інформації з однієї бактерії до другої А. Під час кон’югації через цитоплазматичний місток клітини обмінюються спадковою інформацією. Б. Бактеріофаг разом зі своєю нуклеїновою кислотою може переносити й корисний ген навіть між організмами різних видів. Корисний ген
Клітинадонор спадкової інформації
робляють мутагенними речовинами. При цьому переважна більшість клітин (подекуди понад 99 %) мутує так, що не може далі жити й швидко гине. Але через те, що кількість клітин із мутаціями обчислюється мільйонами, існує невелика ймовірність, що в одній із них мутація (чи мутації) спричинить саме той ефект, що потрібний для селекції.
геноми1, то мутації проявляються

прикладом суміщення неспрямованого мутагенезу й штучного добору є отримання
пеніцила, здатних виробляти антибіотик пеніцилін у більшій
дяки мутагенезу,

Традиційними напрямами селекції є пошук найпродуктивніших, найстійкіших і найбільш економічно вигідних штамів
Селекція мікроорганізмів має на меті виведення штамів, що є найкращими в застосуванні. Найчастіше такі штами характеризуються високою продуктивністю цільової речовини. З другого боку, чим більше клітин існуватиме в культурі в певний проміжок часу, тим більшою буде загальна кількість корисної речовини, яку вона виробляє1. Тому
час штучного добору шукають такі штами, що були б не лише високопродуктивними, а ще
іншим
ми штаму мікроорганізму,

є таємницею той факт, що в сучасному світі
відходів. Існує безліч шляхів боротьби з наслідками забруднень, які вже відбулися, і останнім часом ефективнішим стає використання живих організмів для розкладання забруднювачів. Прикладом успішної роботи в цьому напрямі є добір бактерій, які засвоюють нафту (рис. 41.3). Хоча нафта й не трапляється в природних екосистемах, виявилося, що є мікроорганізми,

1.

розмноження дріжджів
В обміну ДНК між різними штамами бактерій
Г спрямованого мутагенезу грибів, що утворюють антибіотики
3. Двоє студенток висловилися про неспрямований штучний мутагенез. Таїсія переконана, що під час нього гине більшість бактерій. Ірина стверджує, що завдяки неспрямованому мутагенезу завжди можна покращити потрібну властивість. Хто з дівчат має рацію?
4. Бактерії, що споживають
А не трапляються
5. Увідповідніть властивість мікроорганізмів, що
1 частота поділів клітини
2 стійкість до наявності
3 стійкість до забруднення іншим мікроорганізмом
6.
і тварин? Чим це зумовлено?
називають генною (генетичною)
генній інженерії можливі два основних підходи. Перший — редагування генома з метою покращення властивостей. Цей підхід
жаних ознак або посилити необхідні.

Важливо розуміти, що ГМО є ширшим поняттям, ніж трансгенний організм, але будь-який трансгенний організм в будь-якому разі є ГМО.
Завдяки генетичній рекомбінації формуються нові молекули ДНК
Ключовим етапом отримання генетично модифікованого організму є об’єднан-
ня різних молекул ДНК для подальшої
генної модифікації. Процес об’єднання декількох молекул ДНК в одну назива-
ють генетичною рекомбінацією. Здійснюють цей процес так: обидві молекули ДНК обробляють спеціальними
ферментами — рестриктазами, які роз-
різають дволанцюгову ДНК у певних
місцях. При цьому утворюються «липкі
кінці» — ділянки одноланцюгової
ють трансформацію, забезпечуючи захоплення відносно великих молекул ДНК, наприклад, плазмід. Зазвичай для цього клітини бактерій піддають дії стресових факторів: високої температури, електричного поля, хімічних реагентів. Завдяки їм у мембрані бактерій утворюються тимчасові пори, через які до клітини й проникає ДНК із чужими генами (рис. 42.2). У такий спосіб було отримано клітини кишкової палички, здатні синтезувати людський інсулін1, інтерферон, гормон росту соматотропін та інші білки, що застосовують у медицині.
Окрім синтезу чужорідних речовин, завдяки генній інженерії вдалося отримати штами, що виробляють у більших кількостях антибіотики, вітаміни, амінокислоти та інші природні для бактерій речовини.
Здебільшого це було досягнуто завдяки порушенню механізмів регуляції синтезу або
введенню додаткових копій генів.
Генетична модифікація рослин може здійснюватися з використанням бактерій-симбіонтів
Варто зазначити, що чим більше геном організму, тим складніше здійснити генетичну модифікацію. Для доставки модифікувального

Рис. 42.2. Генетична модифікація бактерій Завдяки рестиктазі вирізається потрібний фрагмент із чужорідної ДНК, а також розрізається плазміда. Отримані ДНК зшиваються лігазою для отримання плазміди для трансформації. Після неї не всі бактерії отримують плазміду. І в поживному середовищі з антибіотиком виростають лише ті, що отримали плазміду з геном стійкості до нього.
1. Чужорідна ДНК.
2. Плазміда.
3. Ген стійкості до антибіотика.
4. Обробка рестриктазою.
5. Цільовий ген.
6. Вбудовування гена до плазміди.
7. Трансформація.
8. Вирощування трансформованих клітин.
нізмам його буде вбудовано до геному рослин. При цьому генетична модифікація агробактерії, як уже зазначалося, не є проблемою (рис. 42.3, А).
Для створення повністю генетично модифікованих рослин потрібна зміна геному всіх клітин тіла. Оскільки модифікувати зиготу в покритонасінних рослин складно через наявність численних захисних покривів,

рослинну тканину
проводити мікроін’єкцію. Одна з



шкідників. Так, винайдено сорти кукурудзи, рису й бавовни, які синтезують бактеріальну отруту — Bt-токсин, смертельний для комах, але нешкідливий для хребетних тварин і людини. Також уже вирощують сорти картоплі, стійкі до грибкового захворювання фітофторозу. За останні двадцять років об’єм сільськогосподарської продукції генетично модифікованих рослин виріс більше ніж у сто разів. Уже використовують як харчові продукти генетично модифіковані кукурудзу, сою, квасолю, рис, пшеницю, картоплю, гарбузи, баклажани, помідори, солодкий перець, яблука.
Генетична модифікація тварин здійснюється
Для доставки до геному тварин чужорідних генів найчастіше використовують віруси. А модифікацію
модифікованих тварин, які використовуються вже сьогодні, є кози, що
Завдяки наявності гена людини в геномі, кози виробляють молоко, що містить цей білок. Далі з молока виділяють і


рибки GloFish, які флуоресціюють.
з дикими комарами нежиттєздатне. Їх планують випускати в природу, де
будуть спаровуватися з дикими комарами, переносниками інфекцій, знижуючи їхню чисельність.
Клітинна інженерія дозволяє
із потрібними властивостями Проведення генетичної

і інтерферону. Для їхнього отримання потрібна велика кількість клітин імунної системи. Але В-лімфоцитів, які утворюють один тип антитіл, в організмі мало та їх досить складно виділити. Тому створюють клітинну культуру
Зараження
Рис. 42.6. Отримання лімфоцитів, що продукують антитіла
1. Антиген.
2. Організм-донор лімфоцитів.
3. Лімфоцит.
4. Антитіло.
5. Клітина пухлини.
6. Гібридома.
7. Утворені антитіла.
Злиття клітин
Розвиток ембріона на поживному середовищі
Імплантація до матки третьої вівці
Рис. 42.7. Схема клонування
вівці Доллі
1. Донор соматичної клітини.
2. Донор яйцеклітини.
3. Вирощування соматичних клітин.
4. Яйцеклітина з яєчника.
5. Видалення ядра яйцеклітини.
6. Ядро соматичної клітини.
7. Ранній ембріон.
8. Сурогатна мати.
9. Вівця Доллі, генетично ідентична донорові соматичної клітини.

тварин
отримавши генетично ідентичний організм — клон. Але для тварин такий спосіб не прийнятний, оскільки клітини дорослої тварини не здатні нескінченно ділитися й спеціалізуватися. Але й це обмеження можна обійти, скориставшись операцією пересадки ядра (рис. 42.7). Для цього із клітини тіла дорослого організму (соматичної клітини) вилучають ядро й переносять його до незаплідненої

ід моменту створення ГМО в 1980-х роках навколо їх безпеки точиться суспільна й наукова дискусія. І якщо наразі наукове обговорення є близьким до завершення з майже одностайним висновком про безпечність ГМО, які пройшли ретельну перевірку, то публічне обговорення продовжується. Нещодавно здійснені дослідження свідчать, що неправдива інформація поширюється приблизно у 100 разів краще, ніж істинна. Це зумовлено тим, що брехню легше зробити веселою, страшною, такою, що викликає подив чи суперечить усталеним поглядам. Завдяки цьому «wowефекту» різні вигадки, фейки та фальсифікації швидко «оселяються» у свідомості пересічних людей, тоді як правдива інформація часто має вигляд сухої, сірої й банальної. Тому ЗМІ й соціальні мережі набагато частіше популяризують інформацію про ті поодинокі дослідження, що
що харчувалися генетично модифікованою

2.

3.
людських А хромосом Б тканин В клітин Г імуноглобулінів
4. Заповніть пропуски в реченні про гібридоми.
Клітина гібридоми може нескінченно (1) і синтезувати під час свого існування (2).
А 1 – рости, 2 – інтерферон Б 1 – ділитися, 2 – антитіла
В 1 – рости, 2 – чужорідні білки Г 1 –
ділитися, 2 – вітаміни
5. Оберіть правильне твердження про клонування.
А є основним способом розмноження ссавців
Б призводить до отримання генетично ідентичних організмів
В здійснюють із використанням ферментів-рестриктаз
Г неможливо здійснити для рослин 6. Розгляньте рисунок 42.2 і вкажіть правильний порядок
створення штаму кишкової палички, що синтезує людський гормон росту.
А вирізання гена гормону росту з людської ДНК
Б трансформація бактерії рекомбінантною плазмідою
В вбудовування гена гормону росту до плазміди
Г вирощування бактерій, що містять рекомбінантну плазміду
7.
8. Чому технології генетичної модифікації
10.
у будь-якій районній лікарні.
вилікувати які медицина не здатна. Насамперед це
існують
мовлені вродженими порушеннями ДНК. Для деяких із них можлива терапія, спрямована на усунення або полегшення симптомів. Так, наприклад, при фенілкетонурії в організмі порушується процес метаболізму амінокислоти фенілаланіну. Це спричиняє накопичення в тканинах токсичних проміжних продуктів її розкладу, які негативно
спричиняючи розвиток ідіотії. Полегшити
симптоми
чайна

(генетичну) терапію.
1.
2.
3.
5.
6.
кувальні» фрагменти ДНК із часом втрачатимуться. Окрім вірусів, для доставки ДНК до клітин in vivo використовують ліпідні пухирці (ліпосоми), полімерні комплекси, неорганічні наночастинки (золото, Fe3O4, SiO2), спеціальні пептиди чи їхнє поєднання. Такі способи переносу поступаються ефективністю вірусам, але майже не збурюють імунну систему

подібний
спільнота сподівається, що подібна технологія дозволить лікувати дальтонізм у людини. До речі, у такий же спосіб у людей уже було вилікувано деякі спадкові захворювання сітківки. У численних клінічних випробуваннях вдалося провести успішні модифікації
Інший відомий приклад використання генетичної інженерії людини — генна модифікація клітин імунної системи для боротьби з раковими захворюваннями (рис. 43.3). Для її здійснення лімфоцити відбирають із крові пацієнта. Далі в лабораторних умовах ex vivo редагують їх геном із метою «навчити» розпізнавати ракові клітини. Далі «перепрограмовані» лімфоцити повертають назад до організму, де вони борються з клітинами пухлини. Нині вже відомі випадки успішного використання подібної терапії для лікування
лімфоми та лейкемії1: більше половини пацієнтів повністю виліковувалися від раку.
Існує й інший шлях генотерапії онкологічних захворювань, коли до організму вводять віруси, що заражають винятково ракові клітини і вбудовують до їх геному гени, що спричиняють загибель клітин
пухлин.
Крім лікування спадкових хвороб і раку, ще одним напрямком генної терапії є
боротьба з інфекціями. Так, під час досліджень вдалося створити лімфоцити, не чут-
ливі до зараження ВІЛ або такі, що продукують антитіла до цього вірусу. Це дозволило вилікувати людей від інфекції.
1 3 5 2 4


Рис. 43.3. Використання
перепрограмованих лімфоцитів дозволяє боротися
з раковими пухлинами
1. Відбір лімфоцитів.
2. Вирощування лімфоцитів у лабораторний умовах.
3. Генна модифікація лімфоцитів.
4. Уведення модифікованих клітин.
5. Знищення лімфоцитами клітин пухлини.
Можлива також генна терапія не лише окремих клітин, але й цілих тканин. У 2017 році було вилікувано хлопчика з бульозним епідермолізом — спадковим захворюванням шкірних покривів, під час якого на шкірі виникають пухирі та виразки. У пацієнта були виділені
1. Cas9.
2. Спрямовувальна РНК.
3. Розрізання ДНК.
4. ДНК-приклад.
5. Втрата фрагменту ДНК.
6. Вбудовування фрагменту ДНК.
Рис. 43.4. Схема генної модифікації заснована на системі CRISPR/Cas9 Спрямовувальна РНК визначає, який фрагмент ДНК буде змінено, комплементарно зв’язуючись з одним із ланцюгів ДНК. Надалі ДНК може бути пошкоджена (ліворуч)

будуть успадковані
вання геномом людини, людство
сильніших, витриваліших. Сукупність
покращення людської природи, називають євгенікою. Злочинне використання в нацистській Німеччині євгенічної філософії, як обґрунтування расизму, стало причиною масового винищення євреїв, циган, слов’ян
достовірно стверджувати, що людина менш розвинена за однією ознакою, не досягне успіху в інший сфері
знає точних механізмів генетичного визначення, якщо такі й існують, позитивних рис (розумність, фізична сила, винахідливість) і негативних рис (схильність до алкоголізму, злочинної поведінки), то здійснити покращення «людської природи» неможливо. Під час розгляду питань
ширитися людськими популяціями через краще виживання вилікуваних носіїв. І як це вплине згодом на людство, до кінця не зрозуміло. Однак нам варто пам’ятати, що генетична модифікація людини — неминуча реальність, із якою вам, читачі та читачки, доведеться зіштовхнутися в майбутньому, тому відповіді на ці питання потрібно шукати вже зараз.
У деяких країнах дозволено
отримання

юридичні
є біологічними батьками, який правовий статус клону тощо. Інша, актуальніша, задача — терапевтичне
в деяких країнах (Велика Британія, США). Воно має на меті отримання ембріонів, які слугуватимуть джерелом
матеріали
3. Генна терапія раку за допомогою модифікованих лімфоцитів здійснюється А зміною геному ембріона Б in vivo
В завдяки стовбуровим клітинам Г ex vivo
4. Укажіть процес, що законодавчо заборонений у більшості країн світу. А клонування ссавців Б симптоматичне лікування фенілкетонурії
В генна модифікація гамет Г генна терапія ВІЛ-інфекції
5. Увідповідніть проблеми, що виникають під час

6.
7.
технологічних
тощо. Але успіхи біологічної науки у XX ст. дозволили
тів і процесів із заздалегідь визначеною

Проте варто пам’ятати, що вона є сукупністю
нити природні явища.
функціонування живих організмів для отримання
або зміни природних процесів.
Фундаментом біотехнології є різні біологічні
Біотехнологія
но переплетена з ними. Вона широко використовує досягнення фундаментальних біологічних наук. Здобутки
організмів. Біосинтез нових ліків, промислове застосування ферментів ґрунтується на даних біохімії, а клітинна біологія необхідна для розвитку технологій трансплантації тканин і органів та репродуктивних
Біотехнологія є сукупністю галузей
Біотехнологія в сучасному вигляді складається з багатьох незалежних галузей, що виокремлені залежно від сфери діяльності й мети використання живих організмів (рис. 44.1). Варто відразу зазначити, що такий поділ на галузі є умовним. Так, сільськогосподарська біотехнологія може розглядатися як галузь харчової (чи на-
впаки), а водна біотехнологія (використання водних організмів) — як частина харчової, якщо вона виробляє продукти харчування, або промислової, якщо виробляє біопаливо.
Харчова
підвищенням урожайності
жить значна кількість


Рис.
ня хліба, пивоваріння, виноробства, сироваріння. Сільськогосподарська біотехнологія ж займається покращенням агропромисловості й продуктів, що отримують завдяки їй. Розвиток методів генної модифікації дозволив створювати рослини й тварин, які мають заздалегідь задані властивості:
до шкідників та інфекцій, знижену алергенність, багатші
створення фруктів та овочів, які повільніше псуються
Для



Наприклад, із одомашненого в Китаї тутового шовкопря-
що перевершують традиційний шовк за своїми параметрами. Один із них — павучий шовк (із якого павуки плетуть павутиння): легкий матеріал, міцність якого на розрив вища, ніж у сталі та кевлару! Однак шовк, зібраний із павуків,


Галузь
Харчова
промисловість
Паперова промисловість Виробництво мийних засобів Фармацевтична промисловість Молекулярна
біологія
Ферменти
Целюлази, пектинази
Амілази, протеази
Хімозин
Геміцелюлази, лінгін пероксидази
Протеази, ліпази, амілази
Лактатдегідрогенази, альдолази
Рестриктази, лігази, полімерази
паперу
Компоненти мийних засобів
Синтез лікарських препаратів
Генетична (генна) інженерія
відходів. Упровадження такого біопластика дасть можливість значно зменшити несприятливу дію на навколишнє середовище.
Біотехнології дозволяють зменшувати забруднення й визначати стан довкілля
Біотехнології можуть бути використані людиною, щоб зменшити негативний вплив на довкілля. Екологічні біотехнології дозволяють боротися з різними видами забруднень, а також розробляють індикатори для
Наразі мікроорганізми повсюдно знаходять
щенні стічних вод. У
розвинених
стічні води, що виробляються у великих містах, проходять багатоступеневе

і різноманітних забруднювачів до нейтральних сполук: води, вуглекислого газу тощо.
є використання закритих ємностей — біофільтрів і аеротенків (рис. 44.6). У разі використання аеротенка
сиченій киснем водній фазі, а біофільтра
зернистий пористий матеріал, населений мікроорганізмами.

розкладати нафтопродукти
під дією мікроорганізмів ці речовини перетворюватимуться на безпечніші чи швидше виводитимуться з ґрунту. Але таке
но суттєво впливати на життєдіяльність
Урешті-решт компоненти живого
тися

за допомогою
ферментів можна виявляти
параметрів, яка й детектується.



шою за ту, що утворюється за цей час у ньому, то з часом у апараті
А лишиться лише поживне середовище
Б усі дріжджі загинуть
В виробництво цільового продукту стане максимальним
Г зросте густина популяції дріжджів
3. Прикладом дослідження в галузі промислової біотехнології може слугувати
А розроблення технології отримання людських гормонів у бактеріях
Б збільшення плідності курей
В підвищення стійкості картоплі до пестицидів
Г створення штамів для очищення ґрунтів від нафтопродуктів
4. Метаногенні археї використовуються
для лікування вірусних
для отримання антибіотиків
В для очищення води
Г як компоненти біосенсорів
5. Увідповідніть біологічний об’єкт і галузь біотехнології, де він використовується. А харчова біотехнологія Б промислова біотехнологія В медична біотехнологія Г екологічна біотехнологія
1 бактерія Sedum alfredii, що поглинає Кадмій
2 тутовий шовкопряд
3 аденовірус людини
4 «золотий» рис, збагачений b-каротином
Медичні біотехнології забезпечують сучасними
аналізу
Як уже зазначалося в попередньому параграфі, сучасні біотехнології застосовують у багатьох сферах людської діяльності, зокрема й у медицині. Галузь біотехнологій, що займається розробкою нових методів діагностики та лікування, а також створенням і виробництвом ліків має назву медична біотехнологія.
Сучасна медична біотехнологія забезпечила
медицину величезним арсеналом потужних і чутливих методів аналізу, що дозволяють виявити
в пробі біомаркери захворювань. Імунофермент-
ний аналіз заснований на взаємодії молекул у пробі (антигенів) зі штучно отриманими антитілами (рис. 45.1, А). Антигеном може бути білок
оболонки бактерії або капсида вірусу, білок-маркер запального процесу або ракової пухлини тощо. До антитіла прикріплено фермент, що каталізує певну реакцію, за продуктами якої можна
говорити про наявність антигенів у пробі. Наприклад, за наявності антитіла з ферментом може змінюватися забарвлення, з’являтися світіння.
Фермент Реагент
Антитіло

Сигнальний продукт
Антиген

ном антитіло детектується за сигналом від продукту ферментативної реакції.
Б. Планшет на 96 лунок дозволяє здійснювати одночасний імуноферментний аналіз багатьох проб. Поява специфічного забарвлення (синього) свідчить про наявність антигена. А
Імуноферментний аналіз часто виконують на спеціальних планшетах, які дозволяють досліджувати водночас значну кількість проб (рис. 45.1, Б). Домашні тести на вагітність (рис. 44.7, Б) використовують цей вид аналізу у своїй роботі. Метод полімеразної ланцюгової реакції (ПЛР), як ви вже знаєте, дозволяє багаторазово скопіювати певну ділянку ДНК в пробірці, використовуючи бактеріальні ферменти реплікації. Для того, щоб реплікація


45.3. ДНК-чіп А. За наявності
ДНК із ділянкою, що є комплементарною фрагментові ДНК на чіпі, останній з’єднується з ДНК проби й там, де він розташований, спостерігається флуоресценція. Б. Кожна точка,
певної ділянки ДНК, синтезування великої
го аналізу. Як діагностичний метод
час пренатальної
збудників захворювання в пробі. ДНК-чіп — це пристрій, що є

ють
ренні індивідуального
що
виявити генетичні порушення або схильність до певних патологій.
Завдяки розвитку біотехнологій
препарати Сучасна медицина використовує
що отримують як із природних джерел (тобто біотехнологічні), так і методами хімічного синтезу. Нині глибокі
лювальних технологій дозволяє
фармакологічними властивостями. Проаналізувавши дані
потрібна їхня адресна доставка

1 2 4 5
Рис. 45.5. Схема
ліпосомної наночастинки для адресної доставки різних типів ліків
1. Поверхневі молекули для захисту від знищення
неракових клітин, що активно діляться (клітин шкіри, кісткового мозку,
4.

Пара пацієнтів
Пара донорів 6
1 2 3 4 5
Рис. 45.6. Методи репродуктивної медицини А. Екстракорпоральне запліднення. 1. Відбирання яйцеклітин. 2. Сперматозоїд. 3. Яйцеклітина. 4. Запліднення ex vivo, «у пробірці». 5. Уведення ембріона до матки. 6. Ембріон. Б. Метод цитоплазматичної заміни. 1. Зигота пари пацієнтів із ушкодженими мітохондріями. 2. Здорове ядро виймають із ушкодженої зиготи. 3. Ядро видаляють зі здорової зиготи. 4. Ядро пацієнтів переносять до зиготи донорів зі здоровими мітохондріями. 5. Ембріон, позбавлений мітохондріальних хвороб. 1 5 4 3 2 А
час вирощують у інкубаторі,
сурогатної матері. Метод цитоплазматичної
Клітини підшлункової

клітин, на відміну від ембріональних, вимагає генетичного перепрограмування соматичних клітин дорослої людини. Надалі в спеціальному середовищі з обох видів стовбурових клітин вирощують тканини й органи для трансплантації.
клітини (рис. 45.7). Останні отримують зі звичайних клітин організму, перепрограмуваши їх за допомогою методів генетичної інженерії.
Виростити цілий орган важко, оскільки він складається з різних тканин. Оригінальне рішення полягає в тому, щоб вирощувати різні типи клітин окремо, а потім збирати їх разом у єдиний орган. Це можливо завдяки створенню спеціальних 3D-біопринтерів. При цьому як «будівельний матеріал» використовуються вирощені клітини, речовини міжклітинного середовища
їхні замінники. На сьогодні за допомогою біопринтингу вже вдається успішно друкувати кровоносні судини (рис. 45.8, А). Проте в майбутньому
почати друк складніших структур і цілих органів. Важливо відрізняти біопринтинг від звичайного
гу. Останній застосовується, наприклад,
тезів (рис. 45.8, Б). У ньому використовується лише штучний матеріал, але не живі клітини. У випадку із 3D-друком протезів відновлюються


фізичні й механічні властивості
тканини.
парати, до їхньої оболонки вбудовують
А нуклеїнові кислоти, комплементарні клітинним
Б вуглеводи, що надають солодкості препарату під час
В ліпіди, що активують імунну систему
Г білки, що специфічно зв’язуються з рецепторами клітин 3. Під час екстракорпорального запліднення
А народжується клон одного з батьків
Б використовується тільки яйцеклітина
В народжується дитина з донорськими мітохондріями
Г частина ембріогенезу відбувається поза організмом матері
4. Використання стовбурових
вання тканин для

5. Увідповідніть медичну
1 РНК-інтерференція
2 адресна доставка препарату, що порушує мітоз
3 цитоплазматична заміна
4 тканинна інженерія
застосуванням. А блокування розмноження клітин пухлини
Б відновлення обгорілої ділянки шкіри В подолання жіночого безпліддя, спричиненого порушенням роботи мітохондрій Г виявлення спадкових порушень Д пригнічення надмірного біосинтезу білка в нейронах
Численні живі
тєдіяльності негативно діють на здоров’я людини, сільськогосподарських тварин і рослин, а також стан природних біологічних об’єктів — спричиняють хвороби, порушення життєдіяльності та навіть смерть. Такий вплив називають біологічною небез-
пекою (рис. 46.1), а компоненти живої природи, що
його здійснюють, біологічно небезпечними агентами. У цьому параграфі ми зосередимось на небезпеці для людини й суспільства, а питання негативного впливу організмів на довкілля були об’єктом
розгляду в § 23 і § 27. Найпоширенішими біологічно небезпечними агентами для людини є пріони, віруси, бактерії й інші паразити, що

становлять середовища, обладнання й посуд, які використовувалися
Група ризику
Поширення
Не передається
Наявність лікування
потрібне
Приклад
Вірус чумки собак, сінна паличка, пекарські дріжджі
Вірус свинки, бактерія-збудник гонореї, грибок кандида
часто зустрічаються
природодослідницького й медичного кіл, це працівники
сміттєзбирального господарства, харчової промисловості та навіть співробітники й співробітниці музеїв, архівів і бібліотек.
Використання біологічної зброї заборонене,
може бути застосована Біонебезпечні агенти можуть бути основною біологічної зброї — спеціальних боєприпасів, що містять організми чи

збудників чуми, сибірської виразки (сибірки), висипного тифу, геморагічних лихоманок (віруси Марбург і Ебола), натуральної віспи1.
такої зброї полягає в тому, що важко спрогнозувати
зараження: чи буде це лише

Рис. 46.2. Солдат військ радіаційного, хімічного та біологічного захисту в костюмі хімічного захисту
не тільки ураження людей, але й спричинення паніки, нанесення масштабних інфраструктурних і економічних

довкілля може
завжди ретельно охороняються.
одним можливим напрямом
ризму є аграрний, коли біологічні агенти використовуються для нанесення шкоди й знищення продовольчих, сільськогосподарських чи природних ресурсів країни. Для цього можуть використовуватися збудники хвороб сільськогосподарських тварин і рослин, шкідники, небезпечні організми, чиї токсини накопичуються в харчових продуктах. Така
дія може спровокувати інфікування людей, спричинити підвищення цін, фінансові збитки, масові заворушення.
ГМО мають створюватися й використовуватися із обережністю Створення


природи. Тоді, наприклад, природні
цидів. Час від часу такі випадки фіксувалися, тому розробники
розробниці почали створювати генетично модифіковані
Через свою високу стійкість до шкідників ГМО потенційно можуть витісняти природні організми з екосистем. Також уведені в трансгенні сорти токсини деколи мають негативну
на

ження в довкіллі. Для захисту людей усіх професій,
. Необхідно підтримувати високий рівень чистоти робочого простору (ефективна вентиляція, регулярне прибирання), інструментів, одягу та тіла працюючих (обладнати душові). . Треба маркувати й утилізувати відходи відповідно до рівня їхньої небезпечності (рис. 46.4).
Заходи біологічної безпеки ефективно реалізуються в лабораторіях
Найбільшим джерелом біологічної небезпеки (окрім природних осередків епідемії) є науково-

Рис. 46.4. Спеціальні пакети для різних типів біонебезпечних медичних відходів
дослідні лабораторії. Тому найяскравіше біологічний захист проявляється саме в них. Щоб не заразитися під час роботи з небезпечними організмами, персонал одягає засоби індивідуального захисту (рис. 46.5).

ступенем захищеності
поділяють на чотири групи: BSL-1 –BSL-41. Робота з організмами ІІІ і ІV груп ризику (див. табл. 46.1) відбувається в лабораторіях із рівнями ВSL-3 і BSL-4 відповідно, що мають спеціальне оснащення: двері з автоматичним замиканням, повністю ізольовані костюми з надлишковим тиском, герметичні бокси (рис. 46.6). Усе повітря, рідини і тверді частинки в таких лабораторіях збираються спеціальними системами, фільтруються та дезінфікуються чи знищуються. Крім того, до лабораторій високих рівнів навіть науковці мають обмежений доступ і там організовано воєнізовану охорону для уникнення диверсій і біотероризму.



Рис. 46.5. Індивідуальні засоби біобезпеки
Рис. 46.6. Обладнання лабораторій високого рівня біозахисту
A. Завдяки надлишковому

Безпечне
об досліджувати смертельно
небезпечні інфекції (чи навіть
тіла позаземного походження)
й розробляти ліки від них, потрібне безпечне місце — лабораторія
четвертого рівня біобезпеки (BSL-4).
Для того, щоб зайти на її територію, необхідна спеціальна перепустка. На-
далі співробітниці чи співробітнику
доведеться зняти одяг і перевдягнутися в спеціальний захисний костюм.

Цей костюм зроблено з цупкого прорезиненого матеріалу, що повністю ізолює дослідника від довкілля. Навіть проміжки між штанинами й взуттям заклеюють скотчем, якщо воно не є частиною спецкостюма!
тиляції
тюмі тиск є більшим за тиск у приміщенні, тож якщо герметичність одягу буде порушено, то повітря виходитиме
небезпечним збудникам проникнути
навпаки, є меншим за атмосферний, що убезпечує довкілля від потрапляння до нього збудників: у
заражене повітря не залишатиме
Б інфікувати якомога більше людей
В спричинити порушення громадського порядку
Г визначити рівень навченості правоохоронних структур
3. Укажіть правильну реалізацію біологічного захисту на сміттєсортуваль-
ному заводі.
А максимальна автоматизація процесів
Б збільшення кількості працівників для підвищення ефективності
В робота зі сміттям лише в герметично замкненому просторі
Г обов’язкове миття працівників перед входом до цеху
4. Усі тверді відходи з лабораторії
А викидаються зі стічними водами
ґрунт В вивозяться разом із побутовим сміттям Г знезаражуються
1 здатність передавати свої гени «диким» організмам
2 висока стійкість до шкідників
3 здатність синтезувати токсини
5. Увідповідніть властивість ГМО й прояв біологічної небезпеки. А швидке виснаження ґрунтів Б можливість витіснення природних видів зі складу екосистеми В поширення стійкості по екосистемі Г отруйність для нешкідників


Однією з нагальних потреб медицини є розуміння процесів, що відбуваються в організмі на молекулярному та клітинному рівнях, бо саме тут починаються всі хвороби. І допомогти з’ясувати це має біологія. Завдяки все більшому розширенню арсеналу підходів і методів біодосліджень, експериментам над штучно створеними тканинами й органами, зростанню можливостей моделювання та комп’ютерної обробки даних амбітна ціль — зрозуміти, як працює людський організм і чому та в який спосіб виникають хвороби, — є усе ближчою до досягнення. Після розшифрування геному людини було розпочато рух до розшифрування й мапування інших важливих її систем: змін геному без зміни послідовності нуклеотидів (епігеному), набору матричних РНК (транскриптому), білків (протеому), нейронів головного мозку (коннектому, рис. 47.1), мікрофлори організму (мікробіому) тощо. Усі ці «–оми» якраз і є тим шляхом, що веде до створення всеохопної картини функціонування нашого організму. А отримані знання потрібні не лише для вирішення проблем людського здоров’я, але
думовою впровадження багатьох технологій медицини майбутнього.
Персоналізована медицина
індивідуальними



такої технології. Визначення генотипу
лактиці полігенних захворювань (діабету
раку чи
ра й Паркінсона), які зумовлені наявністю специфічних алелей у генотипах. Лікарі й лікарки, знаючи з генотипу можливість їх розвитку, рекомендуватимуть пацієнтові чи пацієнтці змінити спосіб життя й частіше проходити
ження, щоб діагностувати хворобу

тати (рис. 47.2), які


в тілі. Досягнення регенеративної медицини — створення
ком, їхнє оновлення
фотосинтез. Уже розроблено системи, які здійснюють розщеплення води на водень і кисень більш ефективно, ніж фотосистеми хлоропластів (рис. 47.3, А). Але отриманий водень
наразі триває створення пристроїв, що зможуть використовувати електрони, «відірвані» за рахунок
світла
лекислого газу й утворення органічних сполук (рис. 47.3, Б). Іншими перспективними підходами до вирішення
(рис.
нок вирощування рослин без ґрунту

ню яких сприятимуть біотехнології. Так, отримання альтернативних викопному видів палива з відходів завдяки археям (метан), бактеріям (водень), грибам (спирти), водоростям і наземним рослинам (олії) допоможе



(ферментів, антитіл) у побут і промисловість
логічність. Урешті-решт,

параметри серцево-судинної системи суттєво змінюються. Космічна радіація
не
з аеронавтики й дослідження космічного простору (NASA)
Тераформування
кліматичних умов космічного тіла для життя наземних істот — однозначно буде
здійснюватися за участі живих організмів (рис. 47.5). Наразі відомо, що в змодельованих умовах Марсу можуть виживати
деякі ціанобактерії та археї. Оселення цих організмів на планеті призведе до виділення парникових газів (вуглекислого газу, метану), що сприятиме розігріванню
планети. Крім того, разом із киснем вони
поступово утворюватимуть первинну атмосферу планети, а рештки відмерлих
організмів ставатимуть основою ґрунту.
Але для реалізації цього сценарію обрана

для заселення планета повинна мати значні запаси води. Майбутнім «інопланетним» екологам і екологиням доведеться створювати за допомогою
ної інженерії нові види мікро- і макроорганізмів, пристосованих до умов
цих справах не обійтися

частково розв’язана. Найімовірніше, поселенці полетять до свого нового дому у вигляді заморожених ембріонів.
Наразі вже розроблено технологію заморожування ембріонів у рідкому азоті без
втрати їхньої життєздатності. А «виношу-
вання» плоду буде здійснено спочатку на
поживному середовищі, а згодом у штучній матці (рис. 47.6).
Однак, не варто забувати, що на нашій планеті ще вдосталь незаселених місць і океанічних просторів.


зовсім іншою. Головний багаж, із яким
тися, розучуватися й переучуватися. Нічого не бійтеся, особливо помилятися. Не засмучуйтесь, якщо будуть невдачі та провали. Пам’ятайте: не помиляється той, хто нічого не робить. Робіть спроби, експериментуйте, досліджуйте й тіштеся кожній, навіть найменшій, перемозі.
і знайомих! Будьте позитивними, радісними
людям посміхається удача.
Біологія сьогодні — це
гічні
ціональний університет
155 с. Екологія довкілля. Охорона природи: навчальний посібник / В. Грицик, Ю. Канарський, Я. Бедрій. — К.: Кондор, 2009.
Злобін Ю.А., Кочубей Н.В. Загальна екологія: Навчальний посібник. — Суми: ВТД «Університетська книга», 2003. Клінічна та лабораторна імунологія. Національний підручник. За загальною редакцією доктора медичних наук, професора Кузнецової Л.В.; доктора медичних наук, професора Фролова В.М.; доктора медичних наук, професора Бабаджана В.Д. — К.: ООО «Полиграф плюс», 2012.
Мягченко О.П. Основи екології. Підручник. — К.: Центр учбової літератури, 2010. Національна доповідь про стан навколишнього природного середовища в Україні у 2015 році. — К.: Міністерство екології та природних ресурсів України, ФОП Грінь Д.С., 2017. Чернова Н.М., Былова А.М. Общая экология: Учебник для студентов педагогических вузов. — М.: Дрофа, 2004. Яблоков А.В., Юсуфов А.Г. Эволюционное учение: Учеб. для биол. спец, вузов. — 6-e изд., испр. — М.: Высш. шк., 2006.
Якобисяк М. Імунологія / Переклад
— Вінниця: НОВА КНИГА, 2004.
Basic and Applied Aspects of Biotechnology / Gupta V., Sengupta M., Prakash J., Charan Tripathy B. — Springer, 2017.
Campbell Biology, — 11th ed. / Urry L., Cain M., Wasserman S., Minorsky P., Reece J. — Pearson Higher Education, 2016.
Cunningham W.P., Cunningham M.A. Environmental science: a global concern, — 11th ed. — McGraw-Hill Higher Education, 2010.
Ecology, — 4th ed. / Bowman W.D., Hacker S.D., Cain M.L. — Sinauer Associates Inc., 2017. Essentials of clinical immunology, — 6th ed. / Chapel H., Haeney M., Misbah S., Snowden N. — Wiley Blackwell, 2014.
Futuyma D.J., Kirkpatrick M. Evolution, — 4th ed. — Sinauer Associates Inc., 2017.
Molles M.C.Jr. Ecology: concepts and applications, — 7th ed. — McGraw-Hill Education, 2016. Odum, E.P. Basic Ecology. — CBS College Publishing, New York, 1983.
Ridley M. Evolution, — 3rd ed. — Blackwell Publishing, 2004.
Thieman W.J., Palladino M.A. Introduction to biotechnology, — 3rd ed. — Pearson, 2013. Smith T.M., Smith R.L. Elements of ecology, — 9th ed., global ed. — Pearson Education Limited, 2015.
Wright R.T., Boorse D.F. Environmental Science: Toward a Sustainable Future, — 13th ed. — Pearson Higher Education, 2017.

http://helianthus.com.ua/books/bio11
https://www.ed-era.com/ https://www.khanacademy.org/
https://www.sciencegamecenter.org/
http://www.rcsb.org/
https://www.ncbi.nlm.nih.gov/gene
http://ensemblgenomes.org/
Вакцинація ....... 211, 240, 245–246, 252
Види-вселенці див. Інтродуценти Виїдання див. Рослиноїдність
Відновлювані

енергії 155, 187
принцип конкурентного
виключення 34, 93
Екологічна пластичність 31–32
див. також Діапазон толерантності
Екологічна політика.................... 198
Екологічне мислення ................... 191
Екологічний моніторинг див. Екологія — методи
Екологічні фактори (чинники) 84
лімітувальні (обмежувальні) 91
Екологія 79
галузі ................................... 79
завдання
методи ............................. 80–82
об’єкти.................................. 79
предмети 80
Екосистема 103
властивості 106–107
клімаксна 116
Екстракорпоральне

209–213
Імунна система ...................... 66, 250
253–254
253 Імуноферментний аналіз .............. 296 Інбридинг 263–264
Інвазійні види...................... 150, 176 види і механізми імунітету 250–252
імунна пам’ять...................... 252 імунні порушення 253
Інтродуценти ....................... 176–177
реінтродукція 177
Забруднення ........... 141–142, 146–150
типи
України 143–144, 150–151
Забруднювачі .............................. 146 атмосфери 155–156
гідросфери ..................... 163–164
ґрунтів 169–170
Закислення океанічних вод ........... 161 Закон
рядів спадкової
Медико-генетичне консультування .. 237 Медицина 206, 210–211 персоналізована .................... 309 регенеративна 310 репродуктивна ...................... 298 Межі витривалості див. Діапазон толерантності
П
3D-принтинг ............................ 300
Паразитизм 61, 64–65
значення ............................... 68
поведінка хазяїна .................... 67
пристосування 67–68
форми .............................. 65–66
Парниковий ефект 142, 153
Пестициди .................... 122, 148, 210
Підвищення рівня океану 161
Піраміда екологічна .............. 112–113
Планктон див. Гідробіонти
Пойкілотермні організми .......... 51–53
Полімеразна ланцюгова реакція 296
Поліплоїдія............................... 266
Популяційні хвилі 99 Популяція

екологічної
обов’язкового заповнення екологічної ніші див. Екологічна ніша Принцип Анни Кареніної .................... 259
екологічної відповідності 93
екологічної індивідуальності 93
конкурентного виключення див. Екологічна ніша
Чорної королеви .................... 20
Природоохоронні території 192–194 Продуценти ............................. 104 Р
Раціональне природокористування 82, 184
Редуценти 104
РНК-інтерференція 297–298 Рослиноїдність 87–88
Переднє
Адаптація
§ 1. Адаптація — властивість
біологічних систем 5
§ 2. Закономірності формування адаптацій 11
§ 3. Стратегії адаптування ............. 17
§ 4. Молекулярні та клітинні
адаптації ............................. 24
§ 5. Екологічна ніша .................... 31
§ 6. Життя в наземно-
повітряному середовищі 37
§ 7. Життя у водному та ґрунтовому середовищах
§ 8. Cпособи терморегуляції
організмів ...........................
§ 9. Організм як середовище
Паразитизм
Практична робота
Визначення ознак адаптованості різних організмів до середовища
§ 11. Біологічні ритми
Екологія
§
§ 13. Екологічні фактори
§ 14. Екологічні закони
§ 15. Популяція
§ 16. Екосистема
§ 17. Зв’язки між популяціями
в екосистемі 109
§ 18. Сукцесії 115
§ 19. Агроценоз 121
§ 20. Біосфера 126
§ 21. Біогеохімічні цикли ...........
Сталий розвиток та раціональне природокористування
§ 22. Екологічні проблеми сучасності 140
§ 23. Забруднення довкілля
§ 24. Антропічний вплив на атмосферу
§ 25. Антропічний вплив на гідросферу....................
§ 26. Антропічний
§

182
§ 28. Концепція сталого розвитку 184
§ 29. Екологічне мислення
й охорона довкілля ............ 191
§ 30. Екологічна політика в Україні .......................... 198
Біологічні основи здорового способу життя
§ 31. Здоров’я людини 204
§ 32. Чинники впливу на здоров’я ....................... 209
§ 33. Принципи здорового способу життя – 1 215
§ 34. Принципи здорового
§ 35. Алкоголь, тютюн, наркотики і здоров’я .......... 228
§ 36. Репродуктивне здоров’я ...... 235
§ 37. Профілактика захворювань людини .......... 242
Практична робота
Розробка рекомендацій щодо
профілактики захворювань 249
§ 38. Імунна система 250
Застосування результатів
біологічних досліджень
у медицині, селекції та біотехнології
§ 39. Селекція ......................... 257
§ 40. Селекція рослин і тварин . . . . . 263
§ 41. Селекція мікроорганізмів .... 270
§ 42. Генна й клітинна
§ 43. Генна інженерія людини
§ 44. Сучасна біотехнологія
§ 45.
§ 46.
§
Навчальне видання
Ш АЛАМОВ Руслан Васильович
КАЛІБЕРДА Микита Сергійович НОСОВ Георгій Андрійович

БІОЛОГІЯ (рівень стандарту)
Підручник для 11 класу закладів загальної середньої освіти Рекомендовано Міністерством освіти і науки України
Видано за рахунок державних коштів. Продаж заборонено.
Редактор Юлія Тимченко Комп’ютерна верстка
Чумак Коректор Світлана Живолуп, Владислав Колеснік Художник Костянтин Дехніч Художнє оформлення Костянтин Дехніч
В оформленні підручника використані зображення, розміщені в мережі Інтернет для вільного використання
Формат 60х90 1/16. Папір офсетний. Друк офсетний. Умовн. друк. арк. 20щ. Наклад 28332 примірників. Зам. № 9371.
ТОВ «ТО «Соняшник» Адреса видавництва: 61115, м. Харків, а/с 3182. helianthus.com.ua/books Свідоцтво суб’єкта видавничої справи серія ДК № 5180 від 11.08.2016 р.
Видрукувано з готових діапозитивів у ТОВ «Поліпрінт» 04074, м. Київ, вул. Лугова, 1А Свідоцтво суб’єкта видавничої справи серія ДК № 1250 від 27.02.2008 р.